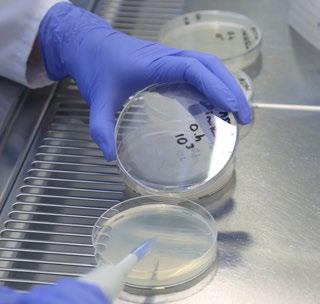

Válida desde el 01.02.2023

Tarifa / Catálogo 2023

Energía solar térmica
Acumulación de agua caliente
Suelo radiante frío/calor
Acumulación y gestión del agua

Depuración de aguas residuales
Depósitos para gasóleo
Industrial

Válida desde el 01.02.2023


Energía solar térmica
Acumulación de agua caliente
Suelo radiante frío/calor
Acumulación y gestión del agua

Depuración de aguas residuales
Depósitos para gasóleo
Industrial
Alemania Roth Industries (Sede Central)




Austria Roth Austria, Krems
Bélgica Roth Benelux, Keerbergen
Canadá Roth Canada, Beloeil
China Roth China, Shanghai
Chile Roth Chile, Santiago
Dinamarca Roth Nordic, Fredriksund
Eslovenia Roth Solvenia, Ljubljana
España Roth Ibérica, Tudela
EEUU Roth Global Plastics, Syracuse, NY



EEUU Roth Industries, Watertown, NY
Finlandia Roth Nordic, Parainen
Francia Roth France, Lagny sur Marne
Gran Bretaña Roth UK, Taunton, Somerset

Grecia Roth Greece, Athen
Holanda Roth Netherlands, LZ Delft

Hungría Roth Hungary, Budapest
Irlanda Roth Ireland, Carrickmore
Italia Roth Italia, Groppoli (MS)
Noruega Roth Nordic, Baerum
Polonia Roth Polska, Zielona Góra
Portugal Roth Portugal, Lisboa
Rep. Checa Roth Czech Repulic, Brno
Rumanía Roth Romania, Timisoara
Rusia Roth Russia, Moskau
Serbia Roth Serbia, Belgrad
Suecia Roth Nordic, Malmö
Suiza Roth Swiss, Kreuzlingen&Kirchdorf
Energía solar térmica


Suelo radiante frío/calor

Acumulación y gestión del agua
Depuración de aguas residuales
Depósitos para gasóleo
Industrial
Acumulación de agua caliente Índice alfabético














Roth Ibérica, S. A. U. tiene contratado un seguro de responsabilidad civil que cubre la actividad industrial de la empresa. Por ello, cualquier daño a terceros que pueda causar la rotura o mal funcionamiento de cualquier producto comercializado por Roth Ibérica, S. A. U. queda cubierto por dicho seguro.
El límite máximo de indemnización por daños personales, materiales y sus consecuencias con cargo del Asegurador ascenderá a 1 MILLÓN DE EUROS (€) por siniestro y año.
También se cuenta con una póliza Master a nivel internacional del Grupo Roth, complementaria a ésta, que cubre 5 MILLONES DE EUROS (€) por siniestro y 15 MILLONES DE EUROS (€) por año.
El ámbito geográfico de cobertura de la póliza es de todo el mundo, excepto EE. UU. y Canadá.
El ámbito temporal de la póliza es mientras permanezca en vigor, es decir, quedan cubiertos por la póliza cualquier siniestro que se produzca durante la vigencia de la misma, siempre y cuando quede constatado, pericial o judicialmente en su defecto, que el siniestro ha sido:
- Por defecto de fabricación del producto.
- Por defectos en la concepción y diseño del producto.
Gama
Energía solar térmica
Acumulación de agua caliente
Suelo radiante frío/calor
Acumulación y gestión del agua
Depuración de aguas residuales
Depósitos para gasóleo
Industrial
El presente certificado no tendrá validez en los siguientes casos:
Descripción de producto
Años
Rothsol 207 10
Rothpool® 5
Sistemas Termosifón (captadores/resto) 10/5 Accesorios en general 3 Componentes y productos eléctricos 3
Quadroline® 5 Acumuladores Vitrificados 3
Accesorios en general 3 Componentes y productos eléctricos 3
Para todos los componentes en general 10 Componentes y grupos mecánicos móviles 3 Componentes y productos eléctricos 3
Rothagua Cerrado 5 Rothagua enterrado Twinbloc 5 Rothagua Abierto PEAD 3 Rothagua EcoCompact 3 Dosificadores químicos 3 Accesorios en general 3
Rothafos / Rothepur 5 Rothagras 5 MicroStar / MicroStar Twinbloc / MicroStep 5 Separadores Hidrocarburos 5 BioStep 5
Accesorios en general 3
Rothalen Plus 5 Duo System 5 Rothalen 5 Accesorios en general 3
AdBlue Station 5
RothStation Portable 3 Unitech / Multitech / Service Box 5 Accesorios en general 3
- Incumplimiento de las especificaciones indicadas en la documentación técnica facilitada por Roth.
- Manipulación, uso, conservación o mantenimiento indebido o inadecuado de los productos fabricados y suministrados por Roth Ibérica, S. A. U.
- Los daños se deriven de una instalación incorrecta de los productos.
- Los datos aportados por el cliente no sean confirmados, sean erróneos o incompletos.
- Los productos y accesorios instalados no sean en su totalidad de Roth.


El concepto Passivhaus proviene de una iniciativa que busca la sostenibilidad de edificios y viviendas. Combina un elevado confort interior con un consumo de energía muy bajo: hasta un 70% en comparación con construcciones tradicionales. Nuestro catálogo está orientado hacia este modelo.
Roth es partner oficial de la Plataforma de Edificación Passivhaus (PEP) cuyos objetivos básicos son adaptar, estudiar y promover este tipo de construcciones en España.
Los productos de Roth usados en construcciones sostenibles presentan varias ventajas además del ahorro. Por ejemplo, nuestra alternativa a la calefacción tradicional es el suelo radiante, más saludable y mucho más eficiente que los radiadores. También hemos desarrollado sistemas que permiten calentar agua utilizando captadores solares térmicos y acumular ACS durante más tiempo sin hacer un consumo energético mayor.
Todos nuestros productos son adaptables a las necesidades de cada vivienda. En Roth pensamos que siempre hay formas de innovar en el ahorro energético.
Breeam® es un certificado de construcción sostenible con presencia a nivel internacional del que formamos parte.

Varios de los criterios con los que Breeam® certifica que una construcción es sostenible son el confort, la salud y el respeto por el medio ambiente. Gracias a las tecnologías Roth de suelo radiante, reutilización de aguas o energía solar térmica, muchos edificios consiguen la certificación Breeam®.
La Plataforma de Edificación Passivhaus (PEP) es una asociación sin ánimo de lucro que promueve los edificios pasivos de España.
Nuestro modelo de negocio persigue el desarrollo e impulso de sistemas sostenibles en hogares y edificios. El papel de Roth se centra en la especialización de tecnologías dentro del área de las energías renovables, la eficiencia energética y la reutilización de recursos.
Con Roth, muchos espacios pueden volverse más sostenibles, pero además lo harán de una forma certificada.
Roth fabrica productos utilizados en edificios certificados por Breeam®.
Fabricamos sistemas centrados en el cuidado del medio ambiente y la salud de quienes nos rodean
Desarrollamos tecnologías que respetan el medio ambienteMicroStar Año 2016 Planta de tratamiento Oxidación Total.

En Roth llevamos más de 70 años innovando por un futuro sostenible.

Tarifa de precios 2023
Válida desde 01.02.2023


El sol es una gran fuente de energía cuya superficie se encuentra a 5.700 ºC y gran parte de esta energía llega hasta nuestro planeta. Además, es una energía limpia e inagotable. Entonces ¿Por qué no utilizarla?
Los sistemas solares para producción de energía térmica están ampliamente desarrollados y nos permiten obtener agua caliente de forma sostenible.
Es importante cuidar nuestro planeta y para ello debemos usar energías limpias que sean obtenidas de forma sostenible. Y qué mejor que
utilizar la energía del sol, una fuente inagotable y gratuita, para producir el agua caliente que necesitamos diariamente en cualquiera de nuestras viviendas, hoteles, instalaciones deportivas, etc. El uso de la energía solar térmica nos permite, además de cuidar el medio ambiente que nos rodea, ahorrar en nuestra factura energética, ya que gran parte de la energía necesaria para calentar el agua que consumimos la podemos generar de forma gratuita gracias a las instalaciones solares.
Incluso en situaciones en las que no contemos con un sistema de generación convencional podríamos abastecer de la energía necesaria cualquier tipo de instalación gracias a las energías renovables.
Hoy en día, viendo el auge de las viviendas bioclimáticas o Passivhaus, las instalaciones de energía solar térmica se convierten en una parte importante de la vivienda a la hora de calentar el agua caliente necesaria, ya que la idea de estas viviendas es llegar a un consumo casi nulo que podemos obtener gracias a la energía solar térmica.
y aparatos eléctricos
Diferentes usos, un mismo sistema Los sistemas solares térmicos nos permiten dar servicio a diferentes instalaciones, desde una vivienda unifamiliar, a un camping o duchas de polideportivo, hasta grandes instalaciones como hoteles o residencias.

Gracias a la versatilidad de los sistemas solares, además de producir ACS podemos generar energía para dar apoyo a la calefacción por suelo radiante.
El ahorro en producción de ACS puede llegar incluso al 100% El gasto en producción de agua caliente de una vivienda supone alrededor de un tercio de la energía total que se consume en una vivienda. Según el CTE, de esta energía, al menos el 60 % debe ser generada a través de sistemas renovables como la energía solar térmica y podríamos llegar incluso hasta un 100 %, con el ahorro energético y económico que supone.

Incluso podemos utilizar los excedentes de producción de ACS y calefacción para calentar piscinas tanto interiores como exteriores.

 Calefacción
Aire acondicionado
Luz
Cocina
Ahorro en A.C.S. A.C.S.
Calefacción
Aire acondicionado
Luz
Cocina
Ahorro en A.C.S. A.C.S.
Sostenibilidad y ahorro
Una instalación solar térmica nos permitirá, además de cuidar el medio ambiente que nos rodea, ahorrar en nuestra factura energética, ya que gran parte de la energía necesaria para calentar el agua que consumimos la podemos generar de forma gratuita gracias a nuestra instalación solar.
Fuente de energía inagotable El sol, una inmensa fuente de energía limpia y gratuita que tenemos al alcance de nuestra mano y con un gran potencial infrautilizado.

Respetuosos con el medio ambiente El uso de energías limpias se está convirtiendo en algo indispensable en una sociedad en la que cada vez la contaminación es mayor. Y la energía solar térmica tiene un gran potencial ¡Aprovechémosla!




Captador solar de alto rendimiento para la producción de ACS y apoyo a calefacción y piscinas. Reduce tus costes energéticos
La gama de energía solar Roth ofrece a nuestros clientes una solución completa para la instalación de sistemas solares en multitud de situaciones, desde una vivienda unifamiliar a un polideportivo, pasando por hospitales, restaurantes, etc. Nuestra filosofía consiste en dar un servicio completo a nuestros clientes, por lo que incluimos todos los componentes necesarios para la instalación, así como el asesoramiento técnico necesario en cada caso para poder realizarla, desde la colocación de los bastidores para el captador solar hasta la puesta en marcha de la centralita de regulación.



El captador Rothsol 207 permite producir agua caliente tanto para ACS como para el apoyo de
calefacción o calentamiento de piscinas. Podremos ir desde la instalación más sencilla a la más compleja con nuestra amplia gama de regulación.
El tratamiento TINOX del absorbedor, junto con su acabado final, hacen del captador Rothsol 207 un captador de alto rendimiento, capaz de producir agua caliente en las peores condiciones.
El diseño interior en parrilla del Rothsol 207 hace que éste sea un captador muy versátil y que se pueda utilizar tanto en instalaciones forzadas con bomba, como en sistemas de termosifón o instalaciones con sistemas de auto vaciado DrainBack.
Por su parte, el diseño exterior permite instalar el captador de forma sencilla tanto en tejados inclinados sobre teja como en cubiertas planas.
Todos los ensayos realizados, tanto internamente como por laboratorios independientes, nos permiten tener un captador robusto y fiable, por lo que podemos ofrecer a nuestros clientes una garantía de hasta 10 años, sabiendo que el captador tendrá una vida útil mucho mayor. El know-how adquirido a lo largo de los años nos ha permitido ir desarrollando un captador cada vez más fiable con menores costes, lo que nos permite ofrecer a nuestros clientes un captador más económico y con toda la fiabilidad de la marca Roth.
El diseño exterior permite instalar el captador de forma sencilla tanto en tejados inclinados sobre teja como en cubiertas planas.
en edificios de viviendas Podremos ir desde la instalación más sencilla a la más completa con nuestra amplia gama de regulación.
Instalación Instalación versátil






Juego bastidor ST vertical 1 captador Rothsol 207
Para la instalación de un captador sobre tejado en vertical. Se compone de 2 perfiles de aluminio, juego de fijación al captador y anclajes para teja mixta. Incluye tapones, tornillos y tuercas de sujeción.
Juego bastidor ST vertical 2 captadores Rothsol 207

Para la instalación de dos captadores sobre tejado en vertical. Se compone de 2 perfiles de aluminio, juego de fijación al captador y anclajes para teja mixta. Incluye tapones, tornillos y tuercas de sujeción.
6070200358 178,00
Juego bastidor CP vertical 1 captador Rothsol 207
Para la instalación de un captador sobre cubierta plana en vertical. Se compone de 2 perfiles de aluminio, juego de fijación al captador y 2 bastidores. Incluye tapones, tornillos y tuercas de sujeción.

6070200359 248,00
Juego bastidor CP vertical 2 captadores Rothsol 207
Para la instalación de dos captadores sobre cubierta plana en vertical. Se compone de 2 perfiles de aluminio, juego de fijación al captador y 2 bastidores. Incluye tapones, tornillos y tuercas de sujeción.
6070200360 152,00
6070200361 245,00
Grupo hidráulico solar UPM3/7,5 con bomba de alta
Unidad premontada con toda la valvulería necesaria, integrada en carcasa de EPP, altamente resistente con grupo de purga incluido. Formada por grifo de bola con válvula anti-retorno integrada, fijación a pared, grupo de seguridad con válvula de seguridad a 6 bar, manómetro de 0 a 10 bar, llaves de esfera de llenado y vaciado, incluidos elementos de montaje, circulador de alta eficiencia Grundfos UPM3PWM/7,5 cableado y probado.
• Sistema premontado con bomba, grupo de purga, desaireador, etc.
• Todos los componentes para cumplir el CTE.
• Presión máxima de trabajo 10 bar.
• Temperatura máxima de trabajo 120 ºC.
• Adaptado a la Directiva Europea de Ecodiseño ErP.
• Mayor rendimiento del sistema y menor consumo energético.
• Facilidad de montaje ya que no necesita una inclinación determinada de los captadores ni una posición concreta del grupo hidráulico respecto a éstos.
• Fácil llenado de la instalación gracias a las válvulas de llenado y vaciado incluidas.
Esquema de instalación de un sistema solar convencional La instalación captará toda la energía que le llegue del sol siempre que pueda seguir calentando el acumulador solar. Cuando el acumulador alcance su temperatura máxima la bomba del grupo de impulsión será parada por el regulador solar para que no se produzcan sobretemperaturas en ningún componente de la instalación. En esta situación, la sobrepresión producida por el aumento de temperatura será absorbida por el vaso de expansión.
• Ausencia de aire en la instalación por lo que no hay peligro de corrosión.
Modelo Referencia PVP €/ud Grupo hidráulico solar UPM3/7,5 6020400334 695,00


Grupo hidráulico DrainBack AE con bomba de alta eficiencia
• Adaptado a la Directiva Europea de Ecodiseño ErP.
• Grupo compacto con depósito de drenaje.
• Bomba Yonos Para ST15/13 PWM2.

• Altura máxima entre el DrainBack y captadores de 13 m.
• Conexiones ½” macho - Cu15.
• Presión máxima de trabajo 3 bar.
• Temperatura máxima de trabajo 110 ºC. Conexionado máximo de 4 captadores o hasta 8 captadores con el kit de ampliación.


• No es necesario disipar los excedentes de energía ya que no se producen.
• Bajo riesgo de congelación ya que los captadores y tuberías quedan vacíos.
• No hace falta rellenar la instalación por pérdidas por sobrepresión ya que no se van a producir.
• Menor mantenimiento del aditivo caloportante.
• No son necesarios algunos elementos de seguridad como purgadores o vasos de expansión.

Instalación solar parada
Esta situación se produce cuando no hay radiación solar (porque es de noche o hay nubes) o cuando esta radiación es excesiva. En este caso la mezcla aditivo-agua queda en la cámara de drenaje y los captadores se vacían.
Instalación solar en funcionamiento Esta situación se da cuando hay radiación solar suficiente para captar la energía del sol y transmitirla al acumulador solar. En este caso la bomba impulsa la mezcla aditivo-agua hasta los captadores solares y la instalación funciona como cualquier otro equipo forzado.
Regulador solar Ex BW v2
Regulador para sistemas solares pequeños y medianos. Con 3 entradas de temperatura y 2 salidas de relé (una de ellas con conexión PWM para bombas HE).
Ideal para los siguientes tipos de instalaciones solares térmicas:
• Calentamiento de 1 acumulador de ACS.
• 1 Acumulador de ACS + disipación de excesos con aerotermo.
• 1 Acumulador de ACS + generador auxiliar. Calentamiento de piscinas. Incluye 3 sondas PT1000.
Regulador solar Ex BW/H v3
Regulador para sistemas solares medianos y grandes. Con 4 entradas de temperatura y 4 salidas de relé (dos de ellas con conexión PWM para bombas HE). Cuenta con varios sistemas preconfigurados y múltiples funciones adicionales que se pueden añadir al sistema así como bloques funcionales para personalizar la instalación.
Ideal para los siguientes tipos de instalaciones solares térmicas:
• Calentamiento de 1 acumulador de ACS + calentamiento de piscina.
1 Acum. ACS + 1 acum. inercia calefacción + disipación con aerotermo.
• 1 Acum. Quadroline TQ-K (combi ACS + inercia) + calentam. piscina.
• 1 Acum. Quadroline TQ-K (combi ACS + inercia) + disipación aerotermo.
Incluye 4 sondas PT1000. Accesorio opcional para conexión a través de App.
Regulador solar BW/H Confort AE



Regulador diferencial de temperaturas con las siguientes funciones: Pantalla digital multifuncional y de mayor tamaño. 7 sistemas base con funciones adicionales. Reloj horario para la bomba solar. Función para sistemas DrainBack. Regulación de velocidad y balance de energía. Limitación de temperatura de captador y acumulador. Sistema de protección anti-hielo. Función de vacaciones (refrigeración del acumulador).
Tarjeta de memoria SD para un tratamiento de datos más cómodo (no incluida).
8 entradas, 5 salidas de relé y 2 salidas PWM. Incluidas 3 sondas PT1000. Dimensiones: 198 x 170 x 43 mm.
Accesorio opcional para conexión a través de App. Consultar plazo de entrega
Sonda inmersión PT1000
Sonda de temperatura para captador y depósito, 6 mm de diámetro, con 2,5 m de cable de silicona, estabilizado para temperaturas hasta 180 ºC.
6040100331 255,00
6040100332 480,00
1135007151 978,00
1135002271 23,00
Vaina para sonda de inmersión
Para alojar la sonda PT1000. 60 mm de largo y rosca de ½" macho. 6020700252 29,00

Caudalímetro
Accesorio para el regulador BW/H Confort AE.
Permite obtener el caudal de agua (o de mezcla de agua con glicol) utilizando una entrada de impulsos. Se utiliza en combinación con el calorímetro integrado en el BW/H Confort AE, utilizando dos entradas de temperatura, para obtener un balance de energía.
Caudalímetro DN 20 - diseñado para su instalación en horizontal o vertical. Frecuencia de impulsos: 1 litro/impulso.
Caudalímetro DN 32 - diseñado para su instalación únicamente en horizontal. Frecuencia de impulsos: 25 litros/impulso.
* Hasta fin de existencias.
Caudalímetro DN 20 - hasta 40 m2 de captadores
6040200143 206,00
Caudalímetro DN 32 - hasta 300 m2 de captadores 6040200144 499,00

Aerotermo 8 kW y 32 kW
Aerotermos para disipación de calor en instalaciones solares térmicas. Equipos modulares que permiten su conexión en batería dependiendo de las necesidades de cada sistema en particular.
Potencia Conexiones Medidas (ancho x alto x profundo) 8 kW ¾” 498 x 288 x 138 mm 32 kW 1” M 870 x 613 x 138 mm
Aerotermo 8 kW 6020700291 815,00

Aerotermo 32 kW 6020700292 2.485,00

Toldo Universal Roth
Toldo protector para captadores solares planos. Se adapta a la superficie de captación de todos los captadores planos Roth, evitando el sobrecalentamiento producido por la incidencia directa de los rayos de sol.
Este dispositivo es apto para evitar que se produzcan excedentes de energía en instalaciones que carecen de consumo e incluso en puestas en marcha o paradas parciales, mediante un tapado parcial o total del campo captador.
Intercambiadores de placas a medida
Intercambiadores de placas calculados a medida para cada instalación solar de ACS, calefacción o piscina. Fabricados en Acero Inoxidable o Titanio según las necesidades. Consulta con el departamento técnico y te calcularemos el modelo más adecuado.
6020100008 245,00
Válvula diversora motorizada 3V Válvulas diversoras de 3 vías para regulación todo/nada en instalaciones solares, de calefacción y de agua fría. Diseñadas para instalaciones solares (llegan a soportar puntas de temperatura de 120 ºC).
* Hasta fin de existencias.
Válvula diversora motorizada 3V - ¾" Kvs 7 6020700290 171,40
Válvula diversora motorizada 3V - 1" Kvs 7,7 6020700289 189,80



Purgador solar
Purgador automático de aire para instalaciones solares. Cuerpo en latón. Cromado. Conexión 3/8” M. Máx. Presión de trabajo: 10 bar. Máx. Presión de descarga: 5 bar. Rango de temperaturas de trabajo: -30 °C a 200 °C.
6020400111 49,50
Válvula de corte para purgador Válvula de corte para purgador automático. Conexión 3/8” M - 3/8” H. Presión máxima de servicio: 10 bar. Rango de temperaturas de trabajo: -30 ºC a 200 ºC 6020400128 29,80

Válvula de seguridad Cuerpo en latón. Conexiones hembra - hembra. Cromado. Conexión ½” H x ¾” H. Rango de temperaturas de trabajo: -30 ºC a 160 °C.
Válvula de seguridad 3 bar 6020400126 29,80
Válvula de seguridad 6 bar 6020400127 36,00 Válvula de seguridad 8 bar 6040200117 38,00
Válvula mezcladora termostática ¾” para ACS Diseñada para el control de la temperatura del agua caliente. Alta sensibilidad incluso en caudales bajos. Con volante manual para seleccionar la temperatura de la mezcla. Protección contra quemaduras. Incluye racores a ½”. Rango de ajuste de temperatura de ACS: 30-60ºC.

* Hasta fin de existencias.

Instrumento de medida para obtener la concentración de aditivo del circuito primario (solar). El refractómetro mide la concentración de propilenglicol (aditivo caloportante Roth para captadores planos) y con este valor sabemos los grados centígrados a los que está protegida la instalación.
6020700330 124,20
6020700161 165,00
Vasos de expansión de membrana fija Para el circuito solar. Membrana fija. Temperatura máxima de servicio 130 ºC. Presión de precarga 2'5 bar. Conexión rosca ¾".
Vaso expansión 12 l: Presión máxima de trabajo 10 bar.
Vaso expansión 24 l: Presión máxima de trabajo 8 bar.
Vaso expansión 12 l Ø 270 mm/ H 304 mm
6020400080 64,00
Vaso expansión 24 l Ø 270 mm/ H 405 mm 6020400081 90,00
Vasos de expansión de membrana recambiable Para el circuito solar. Membrana recambiable. Temperatura máxima de servicio 130 ºC. Presión de precarga 2'5 bar. Presión máxima de trabajo 10 bar.
Conexión vaso de expansión 35, 50 y 100 l: rosca 1". Conexión vaso expansión 200 l rosca 1 ½".


Vaso expansión 35 l Ø 360 mm/ H 615 mm 6020400089 205,00
Vaso expansión 50 l Ø 360 mm/ H 750 mm 6020400090 238,00
Vaso expansión 100 l Ø 450 mm/ H 850 mm 6020400091 440,00
Vaso expansión 200 l Ø 485 mm/ H 1400 mm 6020400092 910,00
Aditivo caloportante azul para captadores planos Bidón de aditivo para mezclar directamente con el agua. Medio portador del calor, protege al circuito solar contra corrosión y heladas. Con una mezcla al 30% se podrá garantizar una protección anticongelante a una temperatura exterior de -13 ºC. Porcentaje mínimo de mezcla aditivo-agua al 20%. Para temperaturas todavía más bajas aumentar el porcentaje de aditivo en la mezcla.

Aditivo caloportante azul para captadores planos 10 l 6020100006 130,00
Aditivo caloportante azul para captadores planos 25 l 6020200002 325,00
Aditivo caloportante azul para captadores planos 210 l 6020100343 2.750,00
El sistema termosifón, como su propia palabra indica tiene un movimiento termosifónico, esto hace que se produzca un movimiento del agua caliente hacia arriba y agua fría hacia abajo por diferencia de densidad. Con lo que conseguimos un sistema autónomo sin bombas de recirculación, sondas, ni centralitas de regulación. Por lo tanto, el Termosifón RTS de Roth es un sistema independiente que no necesita elementos externos para su funcionamiento, lo que simplifica su puesta en marcha y posteriores mantenimientos Gracias a su diseño interno, el calentamiento del ACS se produce de forma instantánea y en un serpentín de Acero Inoxidable AISI 316L, esto hace que al no tener agua de consumo acumulada, ésta se produzca de forma más higiénica y se minimice la proliferación de legionella.

Sistema sin ánodo de sacrificio, sin bomba y sin presión. Todo ello hace que tengamos un sistema muy fiable, ya que se reducen los componentes móviles y los accesorios. Y minimiza las labores de mantenimiento del sistema una vez instalado y puesto en marcha.
Contamos con dos tamaños (RTS 200 y RTS 300) con los que cubrimos todas las necesidades de cualquier vivienda o mediana instalación en nuestras latitudes. Además, ambos sistemas pueden ser instalados tanto en cubierta plana
como sobre un tejado inclinado con tejas. Estas características nos permiten dar servicio a una amplia variedad de instalaciones.
El diseño del RTS Selectivo con el acumulador ligeramente escondido tras los captadores solares hacen de este termosifón un sistema más estético, ya que su elevación es menor frente a otros termosifones con el acumulador en la parte superior. Opcionalmente, contamos con estructuras galvanizadas que no tienen ningún tipo de corrosión, ideales para ambientes marinos en los que queremos que el sistema se mantenga intacto por más tiempo.

Los captadores de alto rendimiento con recubrimiento selectivo de TINOX, junto con el sistema de producción de agua caliente instantánea y su recubrimiento de poliuretano de 50 mm de espesor y libre de CFCs, hacen que tengamos un termosifón de gran calidad a un precio muy competitivo.
Los termosifones RTS Selectivo cuentan con ensayos y certificados tanto a nivel europeo como en España.
En España contamos con los certificados correspondientes del Ministerio para la transición ecológica, así como la homologación dentro del PROSOL, programa de la Agencia Andaluza de la Energía para las subvenciones en instalaciones solares.
Agua caliente gratuita Gracias a este sistema de fácil instalación y eficiente producimos agua caliente de forma instantánea y gratuita asegurando el máximo confort.

Consigue agua caliente gratuita con los sistemas solares autónomos de alto rendimiento
Roth RTS Selectivo
Especificaciones técnicas RTS 200 RTS 300

Captador Unidades 1 2
Dimensiones (mm) 1.988 x 1.218 x 90 1.988 x 1.041 x 90

Superficie bruta (m2) 2,42 2,07 x 2
Superficie apertura (m2) 2,24 1,92 x 2

Superficie absorbedora (m2) 2,23 1,90 x 2
Rendimiento η0= 73% K1= 3,77 W/m2K K2= 0,011 W/m2K
η0= 73% K1= 3,77 W/m2K K2= 0,011 W/m2K Peso (kg) 44 37,20 x 2
Presión de trabajo máx. (bar) 10 10 Temperatura de reposo (ºC) 194 194 Acumulador
Intercambiador
Conexiones (pulgadas)

Presión de trabajo máx. (bar) 6 6 Volumen secundario (litros) 15 15
Volumen total del primario (l) 176
¿Por qué solo bañarnos en verano si la temperatura ambiente es agradable durante más meses?
El captador solar Rothpool® permite calentar el agua de la piscina en esos meses en los que hace calor pero la temperatura del agua todavía no es la idónea para bañarse.

En días soleados, el sistema Rothpool® hace que el agua de la piscina pase por los captadores calentándola para que ésta sea más agradable, por ello es un sistema idóneo para esos meses en los que hace calor pero todavía no apetece bañarse porque el agua está fría Su diseño, con zonas que pueden ser perforadas, hacen que el Rothpool® pueda colocarse en infinidad de posiciones y estructuras. Sus 8 conexiones permiten unir los Rothpool® en diferentes bloques para adaptarnos al espacio existente; y por el propio principio de funcionamiento del sistema, éstos pueden colocarse en múltiples inclinaciones.

Todo esto hace que el producto sea extremadamente versátil y podamos colocarlo en el muro de la casa, sobre un porche, en una cubierta plana, etc.
El sistema de fabricación por co-extrusión con dos capas fabricadas simultáneamente, hacen del Rothpool® un captador robusto y versátil. Y por sus materiales y la forma de fabricación, estos captadores admiten el paso del agua de piscina con cualquier tipo de cloración.

Los ensayos de durabilidad y rendimiento realizados por el CENER garantizan un producto de calidad.

El precio económico de los Rothpool®, junto con los mínimos accesorios necesarios para realizar la instalación, hacen que éste sea un sistema muy asequible y atractivo para el usuario. Teniendo que realizar una inversión relativamente baja para el gran confort que va a obtener a lo largo de los años en su piscina.
El
se presenta en dos tamaños (2,2 y 1,2 m2) para ofrecer una mayor versatilidad a la hora de su colocación y adaptar el sistema Rothpool® a las exigencias de cada instalación.
Aprovecha durante más tiempo tu piscina calentando el agua con los captadores de polietileno Rothpool®Ensayados en laboratorio independiente Dos tamaños
Especificaciones técnicas
Rothpool® 1.2 Rothpool® 2.2
Medidas (mm) 1.090 x 1.110 x 15 2.000 x 1.110 x 15
Superficie útil (m2) 1,2 2,22
Conexiones 8, de las cuales 4 son de ø 40 y 4 de ø 25. A utilizar según conexionado entre paneles. Rendimiento η0= 81,70% K1= 24,29 W/m2·K
Caudal (l/h por m2 Rothpool®) 143 l/h por m² Rothpool® 143 l/h por m² Rothpool®
Pérdida de carga 0,003 bar a 200 l/h·m² 0,003 bar a 200 l/h·m²
Peso (kg) 8,5 14
Presión máxima (bar) 3 3
Presión de trabajo máxima (bar) 1,5 ± 0,5 1,5 ± 0,5
Temperatura máxima (ºC) 70 70
Temperatura mínima (ºC) -50 -50 Capacidad (l) 8 16

Material/color PEHD negro PEHD negro
Paneles conexionados por las tomas de Ø 40 recomendado máximo de 8 por fila Paneles conexionados por las tomas de Ø 25 recomendado máximo de 8 por columna recomendado máximo de 4 por columna
Conexión en campo solar recomendado máximo de 6 columnas x 8 filas recomendado máximo de 6 columnas x 4 filas
Alturas límite de instalación Rothpool® a 10 m sobre la piscina o a 3 m bajo la piscina desde la lámina de agua


Método de fabricación Fabricado por coextrusión y doble capa de polietileno para aumentar la resistencia y durabilidad.

Fácil instalación
Para fijar un captador a la estructura pueden agujerearse directamente las zonas planas.
Versátil El producto es extremadamente versátil y podemos colocarlo en el muro de la casa, sobre un porche, en una cubierta plana, etc.

Kit anclaje sobre tejado - Teja mixta
Formado por 2 anclajes de acero cincado y dos pletinas de sujeción al panel, además de todo el material necesario para su instalación.
Bastidor de aluminio 2 Rothpool®

Bastidor de aluminio de 40 x 20 x 2230 mm perforado, 6 tornillos de acero inoxidable, arandelas y juntas de EPDM. Para instalación de 2 Rothpool® uno al lado del otro. Necesarios 2 ud. en instalaciones de 1 fila, 3 ud. en instalaciones de 2 filas, 4 ud. en instalaciones de 3 filas y 5 ud. en instalaciones de 4 filas.
Bastidor de aluminio 1 Rothpool®
Bastidor de aluminio de 40 x 20 x 1100 mm perforado, 3 tornillos de acero inoxidable, arandelas y juntas de EPDM. Para instalación de 1 Rothpool®. Necesarios 2 ud. en instalaciones de 1 fila, 3 ud. en instalaciones de 2 filas, 4 ud. en instalaciones de 3 filas y 5 ud. en instalaciones de 4 filas.
Unión para bastidores Rothpool®
Formado por un bastidor de aluminio de 35 x 15 x 300 mm perforado para unir bastidores y 4 tornillos de acero inoxidable autorroscantes.
Kit tapones
Formado por 1 manguito de unión de 200 mm que debe cortarse por la mitad, 4 abrazaderas inox supra W2 34-37 y 2 tapones de PPR de 35 x 40. Válidos sólo para las conexiones de Ø 25.
Kit unión Ø 40
Formado por 1 manguito de unión de 240 mm que debe cortarse por la mitad, 4 abrazaderas inox supra W2 51 - 55.

Kit unión Ø 25
Formado por 1 manguito de unión de 240 mm que debe cortarse por la mitad, 4 abrazaderas inox supra W2 34 - 37.
Espiga PVC
Formada por espiga y racor loco de PVC para conexión de Rothpool® con circuito hidráulico.







Espiga PVC Ø 25 con racor loco 25 x 1”
1135004075 66,00
1115010527 74,00
1115010528 65,00
1115010544 24,00
6020400025 29,80
6020400024 33,00
6020400023 27,00
6060000010 4,70
Espiga PVC Ø 40 con racor loco 40 x 1” ½ 6060000011 6,50
Regulador solar EX BW v2

Ideal para controlar el funcionamiento sistemas Rothpool de calentamiento de piscinas. Con display para visualizar la temperatura de captador y piscina así como el estado de la bomba de recirculación. Incluye 3 sondas PT1000.
Sonda inmersión PT1000
Sonda de temperatura para captador y depósito, 6 mm de diámetro, con 2,5 m de cable de silicona estabilizado para temperaturas hasta 180 ºC.

Vaina acero inoxidable para sonda inmersión
Fabricada en acero inoxidable. Diseñada para alojar la sonda PT1000. Dimensiones 60 mm de largo y rosca de ½” macho.
6040100331 255,00
1135002271 23,00
6020700252 29,00





Primera gama completa de depósitos PE para gasóleo.

Tarifa de precios 2023
Válida desde 01.02.2023

 Acumulación de Agua Caliente
Acumulación de Agua Caliente
En la sociedad en la que vivimos no podemos imaginar cómo sería vivir sin agua caliente. Y para producirla y que esté accesible cuando la necesitamos tenemos dos opciones, calentarla en el momento o almacenarla caliente para su uso. Y ahí es donde aparecen los acumuladores de agua caliente sanitaria. Estos acumuladores son capaces de almacenar agua caliente a alta temperatura durante un
largo periodo de tiempo sin que ésta se enfríe
El nivel de eficiencia de un acumulador de agua caliente nos lo dará su etiqueta energética, que dependerá tanto de la propia fabricación del acumulador como del aislamiento que tenga.
Cuanto mejor sea la etiqueta energética (A+, A, B) del acumulador, menores serán las pérdidas energéticas y, por lo tanto, mayor el ahorro que
obtendremos en mantener el agua caliente en su interior para su posterior uso.
En Roth contamos con acumuladores de agua caliente con una alta calificación energética que nos permiten ofrecer un servicio de calidad, además de contar con una amplia gama adaptable a cualquier instalación que podamos imaginar (con caldera, bomba de calor, captadores solares, etc.).
LIGERO
El Quadroline es el acumulador más ligero del mercado, prácticamente la mitad que cualquier acumulador vitri cado
Alta cali cación energética. Excelente aislamiento térmico. El forro aislante nos da un extra de aislamiento llegando a la cali cación energética A
Primer acumulador de bra de composite para agua caliente
Producción instantánea de A.C.S. Serpentín de ACS en acero inoxidable AISI 316L
Ideal para viviendas de consumo casi nulo. Tanto su acabado nal como sus excelentes componentes de fabricación, nos ofrecen un acumulador ideal para viviendas de alto standing energético
Almacenamiento e ciente del agua caliente. Gracias a su aislamiento de EPS y gra to las pérdidas de energía son mínimas.
Quadroline®, un acumulador de alto rendimiento Dentro de nuestra gama de acumuladores de agua caliente sanitaria destacan los acumuladores Quadroline®. Estos acumuladores, de fabricación alemana, cuentan con una serie de características que tanto por sus materiales de fabricación como por su alta calificación energética los hacen únicos en el mercado.
El propio material del acumulador junto con un gran aislamiento de EPS con grafito y los forros adicionales, hacen que podamos ofrecer un acumulador con calificación energética A. La calificación más alta del mercado.

La producción instantánea de ACS hace que el Quadroline® sea un acumulador muy seguro ya que no estamos almacenando grandes cantidades de agua caliente que luego se vayan a consumir, por lo que la proliferación de microorganismos se minimiza.

Materiales de última generación
Por sus materiales y construcción, el Quadroline® tiene un mínimo mantenimiento, ya que no son necesarios cambios de ánodos ni paradas para limpiezas dado que la producción de ACS se realiza de forma instantánea en un serpentín de acero inoxidable AISI 316L.


Su fabricación en polietileno hace que tengamos un acumulador de un peso mínimo, prácticamente la mitad que cualquier acumulador vitrificado del mercado. Lo que supone una gran ventaja para los instaladores a la hora de transportarlo y colocarlo en las salas técnicas.


La alta calidad de los acumuladores Quadroline® hace que el gasto energético sea menor que en otras instalaciones, lo que nos ayuda a tener sistemas más respetuosos con el medio ambiente.
 Calidad Passivhaus certificada Roth está adherida y comprometida con los sellos Breeam y PEP (Plataforma de edificación Passivhaus) que aglutinan a las empresas comprometidas con la sostenibilidad en edificios y construcciones a nivel internacional.
Calidad Passivhaus certificada Roth está adherida y comprometida con los sellos Breeam y PEP (Plataforma de edificación Passivhaus) que aglutinan a las empresas comprometidas con la sostenibilidad en edificios y construcciones a nivel internacional.





ROTH lleva trabajando en el campo de la fabrica-ción de depósitos desde 1963 y más de 40 años con materiales plásticos. Gracias a esta amplia experiencia hemos desarrollado el acumulador de agua caliente Quadroline®, el primer acumulador fabricado en polietileno de alta densidad y con las mismas prestaciones que un acumulador convencional de acero inoxidable Destaca por su bajo peso y su total resistencia a la corrosión, que combinado con su diseño
compacto y atractivo hacen que sea una perfecta solución para las instalaciones solares térmicas. Además, el aislamiento externo desmontable de EPS con grafito junto con los forros aislantes con extra de aislamiento, hacen que tengamos un acumulador con una calificación energética de las más altas del mercado. Lo que hace que consigamos un sistema de una alta calidad que añade valor a cualquier instalación en la que se incorpore.


La







El aislamiento de EPS mejorado con grafito (λ=0,028 W/mK) que recubre todo el acumulador asegura un aislamiento de alta calidad que evita las pérdidas energéticas, por lo que el agua en su interior se mantiene caliente por más tiempo y el consumo energético de la vivienda se reduce si lo comparamos con una instalación en la que se utilicen otros tipos de acumuladores.
Alta calificación energética Gracias a los materiales con los que está fabricado el Quadroline® y a su gran aislamiento, obtenemos una etiqueta energética con una alta calificación energética, llegando a la calificación A utilizando los forros térmicos clase A.


La facilidad para poder quitar y poner el aislante es una ventaja a la hora de transportar e instalar el Quadroline® ya que tendremos acceso tanto a las asas de transporte superiores e inferiores como a las conexiones. Recambios disponibles, consulte con nosotros.









de ejemplo para instalaciones tipo. A la hora de realizar la instalación se deberán tener en cuenta las normativas a aplicar en cada caso, así como los elementos de protección básicos de la instalación. Para otros esquemas, consultar con el Departamento Técnico o visitar la página web.


(gasoil, biomasa, gas, electricidad, bomba de calor...)
(gasoil, biomasa, gas, electricidad, bomba de calor...)
Depósito acumulador con 1 serpentín para ACS
Presión máxima (serpentín ACS) 10 bar
Presión máxima (circuito caldera / calefacción) 3 bar
Temperatura máxima 80 ºC
Conexiones a 1 ¼” 4 Alojamientos de sonda* 4(8)*
Esquemas de ejemplo para instalaciones tipo. A la hora de realizar la instalación se deberán tener en cuenta las normativas a aplicar en cada caso, así como los elementos de protección básicos de la instalación.
Producción instantánea de ACS con acumulador a 65 ºC y caldera apagada (Suministro a 38 ºC y 20 l/min según DIN 4708. Agua de red a 12 ºC).




TQ-TW 325 TQ-TW 500 TQ-TW 850 Volumen de suministro (litros) 375 510 930 Índice de potencia NL 2,8 4,3 7
TQ-TW 325 TQ-TW 500 TQ-TW 850 Caudal máx. (l/min) 40 40 50 Duchas simultáneas 6 6 8 (según CTE HS4)
Depósito acumulador con 2 serpentines
Presión máxima (serpentín ACS) 10 bar
Presión máxima (serpentín SOLAR) 10 bar
Presión máxima (circuito caldera / calefacción 3 bar
Temperatura máxima 80 ºC
Conexiones a 1 ¼” 6
Alojamientos de sonda* 4(8)*
*Modelo 850 litros.
Producción de ACS instantánea con captadores solares
Red
ACS (gasoil, biomasa, gas, electricidad, bomba de calor...)
Esquemas de ejemplo para instalaciones tipo. A la hora de realizar la instalación se deberán tener en cuenta las normativas a aplicar en cada caso, así como los elementos de protección básicos de la instalación. Para otros esquemas, consultar con el Departamento Técnico o visitar la página web.
Producción instantánea de ACS con acumulador a 65 ºC y caldera apagada (Suministro a 38 ºC y 20 l/min según DIN 4708. Agua de red a 12 ºC).


TQ-TWS 325 TQ-TWS 500 TQ-TWS 850 Volumen de suministro (litros) 375 510 930 Índice de potencia NL 2,8 4,3 7
Sonda Sonda
Caudal máximo de producción de ACS
biomasa, gas, electricidad, bomba de calor...)
TQ-TWS 325 TQ-TWS 500 TQ-TWS 850 Caudal máx. (l/min) 40 40 50 Duchas simultáneas 6 6 8 (según CTE HS4)
Para caudales superiores, instale varios Quadroline® conectados en paralelo.
(bomba de calor, geotermia, biomasa...)
Esquemas de ejemplo para instalaciones tipo. A la hora de realizar la instalación se deberán tener en cuenta las normativas a aplicar en cada caso, así como los elementos de protección básicos de la instalación. Para otros esquemas, consultar con el Departamento Técnico o visitar la página web.
Depósito acumulador con 1 serpentín para ACS Presión máxima (serpentín ACS) 10 bar Presión máxima (circuito caldera / calefacción) 3 bar Temperatura máxima 80 ºC Conexiones a 1 ¼” 6 Alojamientos de sonda* 4(8)*
Producción instantánea de ACS con acumulador a 65 ºC y caldera apagada (Suministro a 38 ºC y 20 l/min según DIN 4708. Agua de red a 12 ºC). TQ-TWK 500 TQ-TWK 850 Volumen de suministro (litros) 410 780 Índice de potencia NL 2,5 5,8


Caudal máximo de producción de ACS
TQ-TWK 500 TQ-TWK 850
Caudal máx. (l/min) 40 50 Duchas simultáneas 6 8 (según CTE HS4)
Para caudales superiores, instale varios Quadroline® conectados en paralelo.
Depósito acumulador con 2 serpentines
Producción de ACS instantánea y calentamiento de suelo radiante con captadores solares y apoyo con energía convencional

(bomba de calor, geotermia, biomasa...)
Esquemas de ejemplo para instalaciones tipo. A la hora de realizar la instalación se deberán tener en cuenta las normativas a aplicar en cada caso, así como los elementos de protección básicos de la instalación. Para otros esquemas, consultar con el Departamento Técnico o visitar la página web.
Presión máxima (serpentín ACS) 10 bar
Presión máxima (serpentín SOLAR) 10 bar

Presión máxima (circuito caldera / calefacción) 3 bar
Temperatura máxima 80 ºC Conexiones a 1 ¼” 8
Alojamientos de sonda* 4(8)*
*Modelo 850 litros.
l/min según DIN 4708. Agua de red a 12 ºC).

TQ-K 500 TQ-K 850
Volumen de suministro (litros) 410 780 Índice de potencia NL 2,5 5,8
Gracias a su diseño, es posible calentar el acumulador Quadroline TQ-K con un sistema solar térmico y otra fuente de energía auxiliar renovable sin disminuir el aprovechamiento de energía solar.
Caudal máximo de producción de ACS TQ-K 500 TQ-K 850
Caudal máx. (l/min) 40 50
Duchas simultáneas 6 8 (según CTE HS4)
Para caudales superiores, instale varios Quadroline® conectados en paralelo.
Forro térmico clase A
Forro embellecedor de PVC con tapa y aislante PS integrado de 35 mm, para su uso en todos los modelos de acumulador Quadroline® TQ 325 y TQ 500 y así lograr una mayor eficiencia y la calificación energética A. Color blanco. Espesor total (forro+aislante): 35 mm. La anchura del acumulador aumenta en 70 mm.
Forro térmico clase A para Quadroline® TQ 325 1135007443 395,00
Forro térmico clase A para Quadroline® TQ 500 1135007444 465,00

Forro
Forro embellecedor de PVC con tapa para su uso en todos los modelos de acumulador Quadroline® TQ 325, TQ 500 o TQ 850. Color blanco. Espesor del forro 5 mm.
AForro para Quadroline® TQ 325 1135007441 305,00
Forro para Quadroline® TQ 500 1135007440 325,00
Forro para Quadroline® TQ 850 1135007594 385,00



Accesorio de recirculación de ACS
Accesorio para la recirculación de ACS compuesto por un tubo corrugado de acero inoxidable de 1,8 m de largo y conexión en T de latón. Para su uso con acumuladores Quadroline® TQ-TW, TQ-TWS y TQ-K.


Este accesorio llegará premontado de fábrica en el acumulador Quadroline correspondiente*.
* Consultar plazo de entrega.
Racores de conexión Racor macho/macho y junta plana, fabricado en latón CW511L bajo norma DIN 50930-6. Para su uso en instalaciones de ACS, así como en instalaciones en las que la calidad del agua requiera materiales deszincados.
1135007439 158,00
Racor conexión 1 ¼” 1135007394 15,45
Racor reducción 1 ¼” - 1" 1135007681 22,95
Válvula de seguridad Cuerpo en latón. Conexiones hembra - hembra. Cromado. Conexión ½” H x ¾” H. Rango de temperaturas de trabajo: -30 ºC a 160 °C.
Válvula de seguridad 3 bar 6020400126 29,80 Válvula de seguridad 8 bar 6040200117 38,00
Base antivibraciones Rothapac Bases antivibraciones indispensables para toda buena instalación. Las bases Rothapac están compuestas por una plataforma de chapa de acero galvanizado en la cual se inyecta una espuma de poliuretano. Fabricada con materiales imputrescibles, la base ofrece garantías en cuanto a su durabilidad y su capacidad para soportar cargas pesadas.
Rothapac tipo B para Quadroline® TQ 325 (700 x 850)
7061010101 123,00
Rothapac tipo C para Quadroline® TQ 500 (1.300 x 850) 7061010102 197,00
Rothapac tipo E para Quadroline® TQ 850 (1.500 x 950) 7061010104 367,00
Acumulador Vitrificado de 1 serpentín
Interacumulador de acero carbono ST 37.2 revestido interiormente por capa de vitrificado cerámico de alta calidad, apto para el almacenamiento de agua potable. Serpentín de acero carbono vitrificado. Ánodo de magnesio y termómetro incluidos. Aislamiento de poliuretano expandido rígido de 50 mm y acabado exterior en PVC gris.


Tª máx. ACS 95 ºC
Presión máx. ACS 8 bar
Tª máx. serpentín 95 ºC
Presión máx. serpentín 10 bar
WWS-200 (ø 560 mm / H 1340 mm) C - 81 W
6030100335 1.445,00
WWS-300 (ø 660 mm / H 1420 mm) C - 90 W 6030100336 1.795,00
WWS-500 (ø 750 mm / H 1720 mm) C - 99 W 6030100337 2.555,00
Acumulador Vitrificado de 2 serpentines
Interacumulador de acero carbono ST 37.2 revestido interiormente por capa de vitrificado cerámico de alta calidad, apto para el almacenamiento de agua potable. Dos serpentines de acero carbono vitrificado. Ánodo de magnesio y termómetro incluidos. Aislamiento de poliuretano expandido rígido de 50 mm y acabado exterior en PVC gris.



Tª máx. ACS 95 ºC
Presión máx. ACS 8 bar
Tª máx. serpentín 95 ºC


Presión máx. serpentín 10 bar
EPS-200 (ø 560 mm / H 1340 mm) C - 81 W
6030100338 1.575,00
EPS-300 (ø 660 mm / H 1420 mm) C - 90 W 6030100339 1.985,00
EPS-500 (ø 750 mm / H 1720 mm) C - 99 W 6030100340 2.795,00
Acumulador Combi Vitrificado
Depósito acumulador con acumulador interior de acero vitrificado según DIN 17100, con un serpentín y ánodo instalado. Aislamiento desmontable de poliuretano de 100 mm.
Tª máx. ACS 95 ºC
Presión máx. ACS 6 bar
Tª máx. circuito primario 110 ºC
Presión máx. circuito primario 10 bar
Tª máx. circuito calefacción 95 ºC Presión máx. circuito calef. 3 bar
*Hasta fin de existencias.
Combi Vitrif. 900/200 (ø 790 mm / H 2.123 mm / serpentín 3,00 m2) 6030100132 2.731,20
Válvula de seguridad Cuerpo en latón. Conexiones hembra/hembra. Cromado. Conexión ½” H x ¾” H. Rango de temperaturas de trabajo: -30 ºC a 160 °C.
Válvula de seguridad 3 bar 6020400126 29,80
Válvula de seguridad 6 bar 6020400127 36,00
Válvula de seguridad 8 bar 6040200117 38,00
Base antivibraciones Rothapac Bases antivibraciones indispensables para toda buena instalación. Las bases Rothapac están compuestas por una plataforma de chapa de acero galvanizado en la cual se inyecta una espuma de poliuretano. Fabricada con materiales imputrescibles, la base ofrece garantías en cuanto a su durabilidad y su capacidad para soportar cargas pesadas.
Rothapac tipo A (600 x 650) 7061010100 96,20
Rothapac tipo B (700 x 850) 7061010101 123,00

Ánodos de magnesio Ánodo anticorrosión para recambio en los acumuladores que ya disponen de ánodo. Conexión roscada 1 ¼” M. Importante: Revisar al menos una vez al año. Según la dureza del agua, revisar cada 6 meses.
Ánodo D 32 x 350 6030200342 70,00
Ánodo D 32 x 520 6030200343 82,00
Para calentamiento de agua en los acumuladores que lo permitan. *Accesorio para resistencia y termostato formado por racor hexagonal 1”1/4 H – 1”1/2 M, junta hexagonal y caperuza de protección.
Importante: a la hora de colocar la resistencia se debe tener especial cuidado en que ésta no choque con algún elemento interno del acumulador.
Aviso: resistencias no válidas para acumuladores Quadroline®
Resistencia 1,5 kW. Dimensiones: 32 x 300 mm. 6070300025 46,00

Resistencia 2 kW. Dimensiones: 32 x 300 mm. 6070300023 47,00

Resistencia 2,5 kW. Dimensiones: 32 x 320 mm. 6070300026 49,00

Termostato para resistencia 6070300024 34,00
Protector para resistencia/termostato más racor* 6070300027 23,00
 Modelo
Referencia PVP €/ud
Modelo
Referencia PVP €/ud
TÜV Technische Überwachung GmbH



Fraunhofer IKTS





Se trata de un sistema de climatización que utiliza una red de tuberías plásticas embutidas en toda la superficie del suelo donde pisamos, por la que circulará agua a la temperatura adecuada para transmitir el calor a la estancia de una manera uniforme. Todo el sistema de climatización queda oculto y evitamos tener a la vista elementos como radiadores o aparatos de aire acondicionado. Ahora imagina todo el espacio que ganas y las posibilidades estéticas que se te
abren. Al circular agua a baja temperatura (30-40 ºC) conseguimos sistemas altamente eficientes Además al transmitir el calor por radiación (como lo hace el sol) el ambiente es mucho más saludable: sin corrientes de aire que mueven partículas de polvo y producen sequedad. Nuestra gama de suelo radiante incluye el Sistema original Roth de placa lisa con el que obtendremos el máximo contacto entre tubo y mortero gracias a las grapas de fijación Ex, y el Sistema de placas de nopas
con una variedad de modelos con diferentes espesores y valores de aislamiento térmico-acústico que se adaptará a cualquier requerimiento de la obra. Además, para casos especiales en los que no dispongamos de la suficiente altura para instalar uno de los sistemas anteriores, podremos optar por el Sistema ClimaComfort Compact que solo ocupa 17 mm.
Comparativa de sistemas Si enfrentamos los 3 sistemas más utilizados en la climatización de viviendas, edificios de oficinas, espacios públicos, etc. podemos observar que el suelo radiante es el sistema más confortable y eficiente, por lo que genera más ahorro durante su uso y además permite una libre decoración de estancias porque no necesitamos colocar elementos en las paredes.

Además del sector residencial, el suelo radiante es ideal para edificios de uso terciario como oficinas, hospitales y en especial para locales con altos techos como iglesias o naves industriales porque al calentar por radiación, como lo hace el sol, evita la formación de bolsas de aire caliente en el techo y las consiguientes pérdidas de energía.





Confort y estética Ambientes limpios, agradables y una sensación de bienestar incomparable.
Pies calientes, cabeza fría Así alcanzamos el estado de confort, y así es como calienta el suelo radiante: desde el suelo y sin generar molestas e insalubres corrientes de aire



En la primavera de 1980, Manfred Roth introduce en el mercado la idea de utilizar clips o grapas de plástico para fijar la tubería a las placas aislantes lisas de suelo radiante. Consideró que podía ser un método mucho más sencillo y eficaz que la fijación mediante bridas a rejillas de acero, que era uno de los sistemas que se usaba en ese momento.

Debido al gran éxito de este método de fijación, Roth patentó este sistema como “Tacker system”, término que se extendió y se comenzó a conside-
rar como nombre genérico de sistemas de placa lisa, incluso de otros fabricantes.
El concepto “Tacker system” se sigue utilizando a día de hoy y caracteriza al Sistema Original de placa lisa Roth. El sistema combina placas aislantes lisas de EPS (según norma UNE 13163) de baja conductividad térmica, tuberías de polietileno resistente a la temperatura PERT de alta flexibilidad y fiabilidad, y grapas de fijación que se instalan de una manera rápida y sencilla con la grapadora Roth SpeedStar.






Hasta un 20% más eficiente que el sistema de nopas
Confort garantizado
Los rendimientos del sistema han sido ensayados y verificados tanto para calefacción como para refrescamiento.

Hasta un 15% más eficiente que el sistema de autofijación
Sistema de placa de nopas.
Sistema de placa lisa de autofijación o con grapa convencional.
Sistema original Roth de placa lisa con grapa Ex que eleva el tubo.
Las placas aislantes del sistema original de placa lisa han sido ensayadas por un laboratorio independiente para determinar el nivel de aislamiento acústico aéreo y a impacto.
El film de PVC que recubre las placas protege la capa de EPS e incorpora dos solapas autoadhesivas para unirlas y que el montaje sea más rápido.

Tubería Roth X-PERT S5


De 5 capas y con barrera antioxígeno EVOH protegida en la capa intermedia para evitar que se deteriore durante la instalación. Fabricado en polietileno resistente a la temperatura PERT mediante co-extrusión.

El sistema de suelo radiante tradicional más eficiente y rápido del mercado. Científicamente comprobado
de la tubería mediante


Roth Ex es el más eficiente del mercado porque permite un contacto total entre el tubo y el mortero. Ensayos en laboratorio demuestran que con este método el sistema calienta un 15% por más rápido que otros sistemas de autofijación o grapa convencional.

El sistema de placa de nopas Roth combina tuberías X-PERT S5 con barrera antioxígeno y placas aislantes machihembradas a 4 caras que permiten cumplir con prácticamente todos los requerimientos de altura y nivel de aislamiento térmico y acústico.

La gama de placas de nopas Roth incluye varios modelos con acabado plastificado (para tubo Ø 16 mm y Ø 20 mm) y varios modelos Stark, "fuerte" en alemán, con acabado termoconformado rígido (para tubo Ø 16 mm) que
otorga a la placa una gran resistencia al tránsito de operarios.
En todos los modelos de placas, las nopas están específicamente diseñadas para que el tubo quede sujeto sin necesidad de grapas o complementos y, según el modelo seleccionado, encontramos placas fabricadas en EPS mejorado con grafito, que permiten conseguir un excelente aislamiento térmico con menos espesor que si fuesen fabricadas en EPS convencional.

La unión con doble machihembrado entre placas es sencilla y agiliza la instalación. Una vez colo-
cadas, tendremos todas las nopas perfectamente alineadas y dispondremos de un sistema totalmente estanco sin posibilidad de formación de puentes térmicos
La gama de placas de nopas Stark incluye placas de bajo espesor para adaptarse a edificaciones con poca altura disponible para instalar un suelo radiante y placas con elevados rendimientos térmicos: resistencias térmicas de hasta 1,25 m²K/W pero con posibilidad de fabricar a medida según las necesidades.


Sujeción del tubo sin herramientas
No es necesaria ninguna herramienta para la instalación de la tubería. Además, las nopas están específicamente diseñadas para que el tubo quede sujeto sin necesidad de grapas o complementos.


Placas adaptadas a nueva normativa En 2022 se actualizó la norma UNE-EN 1264. Uno de los cambios más importantes es el método de cálculo del valor de la resistencia térmica de las placas aislantes con tetones. A partir de ahora solo contará la parte plana de la placa como espesor aislante.
Tubería Roth X-PERT S5 De 5 capas y con barrera antioxígeno EVOH protegida en la capa intermedia para evitar que se deteriore durante la instalación. Fabricado en polietileno resistente a la temperatura PERT mediante co-extrusión. Este método de fabricación no necesita procesos de reticulación adicionales para soportar temperatura y presión, por lo que conseguimos una tubería altamente flexible y fiable. Disponible en Ø 16mm y Ø 20 mm.
La más amplia gama de placas de nopas para adaptarse a cualquier requerimiento estructural y de aislamiento térmico




En la norma UNE-EN 1264 se especifica una serie de requisitos que se recomienda cumplir para diseñar un suelo radiante. Uno de los más importantes y donde la norma incide es el aislamiento térmico que debe existir bajo las tuberías para limitar el flujo de calor a través del suelo a las salas situadas inmediatamente debajo. En 2022 se actualizó esta norma UNE y uno de los cambios más importantes precisamente afecta al aislamiento térmico y cómo se debe
determinar ahora el valor de la resistencia térmica de las placas aislantes con nopas. Antes de la actualización, la norma UNE-EN 1264 permitía sumar parte de las nopas al espesor de la parte plana del panel para calcular la resistencia térmica de la placa. Actualmente la norma ya no permite este cálculo y las nopas ya no cuentan. Por lo tanto, las placas de nopas deben incrementar el espesor de la parte plana para cumplir la norma.
Las placas aislantes lisas no se ven afectadas por este cambio normativo y no tendrán que incrementar su espesor para cumplir la norma. Este hecho favorece el uso del Sistema Original de placa lisa Roth ya que mantendrá sus características, diseño y espesor ofreciendo una mayor eficiencia y mejor rendimiento frente a sistemas de placa de nopas.

El espesor aislante es solo la parte plana de la placa

Los cálculos de suelo radiante que desarrollamos en Roth se realizan con el software OPEN BIM ROTH basado en la norma UNE-EN 1264 e integrado en la metodología BIM. Con este software podemos diseñar instalaciones de suelo radiante y refrescante de una forma sencilla y muy ajustada a la realidad, así como extraer del diseño el listado de materiales necesarios, exportarlo a pdf o incluso a un fichero BC3 que le permitirá intercambiar fácilmente información entre programas de presupuestación y bases de datos de la construcción. Este programa se puede descargar de forma gratuita desde la web de Roth. Descarga gratuita



A la hora de diseñar un edificio, lo primordial es dotarlo de un buen aislamiento térmico que limite la pérdida de calor. El Código Técnico de la Edificación proporciona las características que debe cumplir la envolvente de cualquier edificio independientemente del sistema de climatización que se instale (suelo radiante, radiadores, etc).
Resistencia a la conducción de calor mínima de las capas del sistema aislante por debajo de los tubos de los sistemas de calefacción/refrigeración por suelo radiante:
Centrándonos en los edificios climatizados por suelo radiante y basándonos en las pautas que establece la norma UNE EN 1264:2022 para limitar la pérdida de calor hacia abajo de estos sistemas de suelo radiante, mostramos las resistencias tér-
UNE-EN 1264-4:2022 (Tabla 1)
1
2
3.1
3.2
3.3
micas aconsejadas de las capas aislantes que se colocan bajo la tubería (valores independientes del aislamiento para suelos fijado por el CTE).
Por otro lado, todas las placas aislantes Roth cumplen con la norma de obligado cumplimiento
Habitación climatizada inferiormente: R=0,75 m2K/W
Habitación no climatizada inferiormente o directamente sobre el terreno: R=1,25 m2K/W
Habitación en contacto inferiormente con el aire exterior ≥ 0 0C: R=1,25 m2K/W
Habitación en contacto inferiormente con el aire exterior entre 0 y -5 0C: R=1,50 m2K/W

Habitación en contacto inferiormente con el aire exterior < -5 0C: R=2,00 m2K/W
UNE EN 13163 para aislamientos y poseen su correspondiente declaración de prestaciones y certificado CE. Sin estos documentos, la placa aislante no cumpliría la norma y no sería posible su uso.
Placa lisa 25
Dimensiones
1.000 x 1.000 x 27 mm
Densidad nominal 20 kg/m3
Conductividad térmica λ=0.035 W/mK
Resistencia térmica 0,75 m2K/W
Resistencia mín. a compresión 100 kPa
Compatibilidad tubos de Ø 16 y Ø 20mm
Interdistancia entre tubos libre Reducción ruido de impacto 20 dB (1)
Placa lisa 30 rollo
Dimensiones
10.000 x 1.000 x 30 mm
Densidad nominal 15 kg/m3
Conductividad térmica λ=0.040 W/mK
Resistencia térmica 0,75 m2K/W
Resistencia mín. a compresión 65 kPa
Compatibilidad tubos de Ø 16 y Ø 20mm
Interdistancia entre tubos libre
Mortero por encima del tubo mínimo 45 mm (CT-F4)
Reducción ruido de impacto 28 dB (2)
Placa lisa 44
Dimensiones
1.000 x 1.000 x 44 mm
Densidad nominal 20 kg/m3
Conductividad térmica λ=0.035 W/mK
Resistencia térmica 1,25 m2K/W
Resistencia mín. a compresión 100 kPa
Compatibilidad tubos de Ø 16 y Ø 20mm Interdistancia entre tubos libre
Caja 17 m² 4061010525 18,20 €/m²
Rollo 10 m² 1135001581 18,00 €/m²
Placa lisa 30
Dimensiones
1.000 x 1.000 x 30 mm
Densidad nominal 20 kg/m3
Conductividad térmica λ=0.035 W/mK
Resistencia térmica 0,85 m2K/W
Resistencia mín. a compresión 100 kPa
Compatibilidad tubos de Ø 16 y Ø 20mm Interdistancia entre tubos libre
Caja 10 m² 4061010544 25,80 €/m²





Placa lisa 26
Dimensiones
1.000 x 1.000 x 26 mm
Densidad nominal 30 kg/m3
Conductividad térmica λ=0.035 W/mK
Resistencia térmica 0,70 m2K/W
Resistencia mín. a compresión 150 kPa
Caja 15 m² 4061010530 21,80 €/m²
Caja 20 m² 1115001222
22,80 €/m²
Placa de nopas 23 térmica (EPS Grafito)
Dimensiones
1.350 x 750 x 52 mm
Superficie 1,0125 m2
Densidad nominal 25 kg/m³
Espesor aislante parte plana 23 mm
Conductividad térmica λ= 0,030 W/mK Resistencia térmica 0,75 m²K/W según UNE-EN 1264:2022
Resistencia mín. a compresión 150 kPa
Compatibilidad tubos de Ø 16 y Ø 20 mm Interdistancias entre tubos 75, 150, 225 mm Reducción ruido de impacto 22 dB(3)
Placa de nopas 38 térmica (EPS Grafito)
Dimensiones
1.350 x 750 x 67 mm
Superficie 1,0125 m2
Densidad nominal 25 kg/m³ Espesor aislante parte plana 38 mm
Conductividad térmica λ= 0,030 W/mK Resistencia térmica 1,25 m²K/W según UNE-EN 1264:2022
Resistencia mín. a compresión 150 kPa
Compatibilidad tubos de Ø 16 y Ø 20 mm Interdistancias entre tubos 75, 150, 225 mm...
Placa de nopas 13 térmica Stark
Dimensiones
1.400 x 800 x 35 mm
Superficie 1,12 m2
Densidad nominal 25 kg/m³ Espesor aislante parte plana 13 mm Conductividad térmica λ= 0,034 W/mK Resistencia térmica según 0,35 m²K/W UNE-EN 1264:2022
Resistencia mín. a compresión 150 kPa
Compatibilidad Tubo Ø 16 mm Interdistancias entre tubos 50, 100, 150, 200 mm
Placa de nopas 27 térmica Stark
Dimensiones útiles 1.400 x 800 x 49 mm
Superficie 1,12 m2
Densidad nominal 22,5 kg/m³ Espesor aislante parte plana 27 mm
Conductividad térmica λ= 0,035 W/mK Resistencia térmica 0,75 m²K/W según UNE-EN 1264:2022
Resistencia mín. a compresión 100 kPa
Compatibilidad Tubo Ø 16 mm Interdistancias entre tubos 50, 100, 150, 200 mm Reducción ruido de impacto 22 dB(3)
Placa de nopas 44 térmica Stark
Dimensiones útiles 1.400 x 800 x 66 mm



Superficie 1,12 m2
Densidad nominal 22,5 kg/m³ Espesor aislante parte plana 44 mm
Conductividad térmica λ= 0,035 W/mK Resistencia térmica 1,25 m²K/W según UNE-EN 1264:2022
Resistencia mín. a compresión 100 kPa
Compatibilidad Tubo Ø 16 mm Interdistancias entre tubos 50, 100, 150, 200 mm
Caja 12 ud (12,15 m²/ caja) 4025000023 20,40 €/m²


Caja 9 ud (9,11 m²/caja) 4025000038 28,00 €/m²
Caja 14 ud (15,68 m²/ caja) 4024000013 23,90 €/m²
Caja 9 ud (10,08 m²/ caja) 4024000027 26,40 €/m²
Caja 6 ud (6,72 m²/ caja) 4024000044 33,80 €/m²
Modelo Suministro Referencia PVPEl crecimiento de la rehabilitación y reforma de edificios es un hecho. Si a esto le sumamos que cada vez más los sistemas de calefacción por suelo radiante se están imponiendo sobre el resto, los fabricantes debemos ofrecer sistemas de bajo espesor y que reduzcan al máximo los tiempos de ejecución.
El sistema Roth ClimaComfort Compact cumple con estos dos requisitos porque solo necesita 17mm de altura y es posible instalarlo directamente sobre el suelo existente
altura de la instalación incluido el mortero:

Altura reducida. Menor inercia térmica
La fina capa de mortero que cubre este sistema (17 mm) permite que sea instalado en zonas con poca altura disponible y aumenta la velocidad de reacción en comparación con sistemas tradicionales. Este mortero debe ser autonivelante y, en función de la base sobre la que se instale, puede ser necesario un tratamiento previo del suelo (imprimación por ejemplo) antes de colocar las placas. Contacte con fabricantes de mortero para obtener más información (PCI BASF, MAPEI, ARDEX, WEBER...).
Las placas base son autoadhesivas, fabricadas en PET, con una matriz de nopas que ayudará a guiar el tubo X-PERT Ø 11 mm. Una vez instalada la tubería, cubriremos todo con un mortero autonivelante especial para espesores finos que permite ser revestido a las 24 horas con el consiguiente ahorro de tiempos y costes. Además, al utilizar una capa tan fina de mortero, la inercia térmica se reduce drásticamente en comparación con sistemas tradicionales en los que los espesores de mortero son de 50 mm.



En tan solo 60 minutos el sistema está a pleno rendimiento y emitiendo la máxima potencia a la estancia. Los rendimientos del sistema han sido ensayados en laboratorios independientes y verificados mediante certificación DIN CERTCO tanto para calefacción como para refrescamiento. Confort garantizado

Tubería Roth X-PERT S5
De 5 capas y con barrera antioxígeno EVOH protegida en la capa intermedia para evitar que se deteriore durante la instalación. Fabricado en polietileno resistente a la temperatura PERT mediante co-extrusión. Este método de fabricación no necesita procesos de reticulación adicionales para soportar temperatura y presión, por lo que conseguimos una tubería altamente flexible y fiable.
Confort garantizado
Los rendimientos del sistema de suelo radiante ClimaComfort Compact han sido ensayados en laboratorios independientes y verificados mediante certificación DIN CERTCO tanto para calefacción como para refrescamiento.
El sistema de suelo radiante ideal para rehabilitaciones y reformas por su gran eficiencia y su mínima altura: solo 17 mmPInstalación
la estructura hacen que este sistema de suelo radiante sea el más adecuado en obras de rehabilitación para aportar un plus de confort.

¿Reformas tu baño? Aprovecha y cambia el radiador por suelo radiante Con un Grupo compacto CC Compact A.E. se puede instalar suelo radiante ClimaComfort Compact en una sola estancia (un baño por ejemplo) conectando el sistema a un circuito de radiadores a alta temperatura existente. El grupo incluye bomba de alta eficiencia y válvula mezcladora con regulación 10 ºC - 45 ºC. Son necesarios 2 racores Ø11 (1135006677) para conectar un circuito o 2 racores dobles (1135004001) + 4 racores Ø11 (1135006677) para conectar 2 circuitos.



El sistema de pared radiante es ideal para calentar o refrescar estancias en las que no es posible instalar un suelo radiante convencional ni un suelo radiante de baja altura.

Este sistema convierte las paredes en grandes superficies radiantes basándose en el mismo principio del suelo radiante: confort saludable con agua a baja temperatura y sin corrientes de aire.
• Rápida velocidad de reacción tanto para calentar como para refrescar.
• Ideal para rehabilitaciones en edificios donde no sea posible instalar suelo radiante.
• Distribución del calor uniforme por toda la superficie de la pared.
• Instalación rápida y sencilla con tubería Roth X-PERT S5 Ø 16 mm o con tubería multicapa Alu-laserFlex Ø 16 mm.



• Carril portatubos Ø 16. Fabricado en plástico y diseñado para la instalación de los circuitos con tubería Ø 16 mm. Incorpora agujeros perforados para su anclaje a la pared. Medidas: 2.500 x 38 x 22,5 mm. Paso: 50 mm.

• Tubo Roth X-PERT S5 Ø 16 mm. Compuesto de 5 capas, con barrera EVOH en la capa intermedia.
• Tubo multicapa Alu-laserFlex Ø 16 mm PERT/ AL/PE.
• Tira perimetral aislante autoadhesiva para permitir la libre dilatación y evitar puentes térmicos
2. Instalar los carriles portatubos manteniendo las distancias indicadas.
Realizar los circuitos según proyecto empe zando desde abajo Llenar y purgar los circuitos mediante bomba eléctrica de llenado. Realizar prueba de presión.
minerales, plásticas o metálicas) en el primer recrecido.
7. Aplicar una segunda capa de recrecido de 10-15 mm.
Para las capas de recrecido se debe utilizar un mortero adecuado de entre los disponibles en el mercado. Estas capas de recrecido se aplicarán siguiendo las especificaciones propias del fabricante.
1. Tira perimetral aislante autoadhesiva.
2. Pared.

3. Carril portatubos Roth Ø 16 mm (d1: 22,5 mm).
4. Tornillos de fijación del carril.
5. Tubo Roth X-PERT S5 o Alu-LaserFlex Ø 16 mm.


6. Primera capa de mortero.
7. Malla de revoque.
8. Segunda capa de mortero (d2: entre 10 y 15 mm).
9. Enlucido.
Tubo de 5 capas de polietileno resistente a la temperatura PERT tipo II fabricado mediante co-extrusión según norma UNE-EN ISO 22391.
Certificado AENOR 001/007449 y DIN 3V266 PE-RT. De alta flexibilidad, destinada a su utilización en instalaciones de agua caliente y fría en el interior de la estructura de los edificios,


Ø 11 x 1,3 mm Ø 16 x 2,0 mm Ø 20 x 2,0 mm
Volumen interno (l/m) 0,04 0,113 0,201
Conductividad térmica (W/mK) 0,35 0,35 0,35
Rugosidad interna (mm) 0,0003 0,0003 0,0003

Temperatura máxima de trabajo (ºC) 70 70 70
Temperatura máxima puntual (ºC) 95 95 95
Presión máxima (bar) 6 6 6
Radio curvatura 5 x D 5 x D 5 x D
para la conducción de agua destinada o no al consumo humano (sistemas domésticos) y para sistemas de calefacción y refrigeración, a las presiones y temperaturas de acuerdo con la clase de aplicación. Con capa EVOH (copolímero de alcohol vinílico y etileno) en la capa intermedia para evitar que se dañe durante la instalación,
que actúa como barrera anti-oxígeno por lo que se consigue impedir la entrada de oxígeno en la instalación. De este modo se reducen los problemas de corrosión cuando se combinan tubos de plástico con materiales metálicos, consiguiendo aumentar la vida útil de la instalación.


Diámetro exterior nominal (mm) 16
Espesor de pared nominal (mm) 2
Volumen interno (l/m) 0,11
Temperatura/presión de trabajo 70ºC / 6 bar
térmica (W/mK)
Las tuberías multicapa Roth Alu-LaserFlex, fabricadas según normas DIN 4726 y DIN EN ISO 22391, están compuestas por 5 capas. La capa interior en contacto con el fluido es de polietileno resistente a la temperatura (PERT), en el centro se encuentra la capa de aluminio
soldado a tope para impedir la entrada de oxígeno en la instalación y en el exterior hay otra capa protectora de polietileno rojo. Las otras dos capas están compuestas por un polímero altamente adhesivo que une firmemente la capa interna con la de aluminio y a su vez con la capa
protectora externa. Al combinar plástico y metal obtenemos unas tuberías muy resistentes, ligeras e impermeables al paso de oxígeno. Quedan libres de corrosión o incrustaciones garantizando una larga vida útil y una excelente flexibilidad para su uso en instalaciones de suelo radiante frío/calor.
Original y patentada. Sujeta el tubo Ø 16 o Ø 20 mm a la placa lisa y lo eleva para que el mortero lo rodee completamente, así conseguimos mejorar la transmisión de calor y aumentar la velocidad de reacción. Recomendado utilizar 2-3 grapas por metro de tubo.
Grapadora Roth Speedstar
Herramienta que permite trabajar de una forma más rápida y sencilla. Incorpora muelle de retorno que agiliza la fijación del tubo Roth X-PERT S5 Ø 16 o Ø 20 mm a las placas lisas Roth mediante grapas Roth Ex. Mango ergonómico y capacidad de hasta 135 grapas.
Grapa para sujeción de tubo a mallazo 4-5mm
Caja 1000 ud 1135006302 0,16 €/ud
1 ud 1115010582 450,00 €/ud
Cajas 400 ud 4310114205 0,28 €/ud
Grapa para sujeción de tubo a mallazo 6mm Cajas 400 ud 4310114206 0,28 €/ud
Grapadora para grapas mallazo 1 ud 4310101420 150,00 €/ud
Accesorio y herramienta para fijar con seguridad la tubería Ø16 o Ø20 a mallazo de 4, 5 o 6 mm. Ideal para grandes superficies o suelos radiantes industriales. Necesarias entre 2 y 3 grapas por metro de tubo.
Tira perimetral aislante con doble adhesivo Aislamiento de espuma de poliestireno de 10 mm de espesor y 160 mm de altura para bordear las placas aislantes y asegurar una total independencia entre la losa de mortero y las paredes. Con tira adhesiva en la parte posterior para fijarla a la pared y tira adhesiva en el babero plástico para fijarlo a la placa aislante y evitar que el mortero se cuele bajo las placas. Ideal para sistemas de suelo radiante con mortero autonivelante.
Perfil para junta de dilatación Espuma de poliestireno en perfil angular plástico diseñado para dividir la losa del mortero si la superficie es superior a 40 m² y así evitar fisuras. Medidas: 1.800 x 100 x 10 mm.
Barrera antihumedad
Film de polietileno de 0,2 mm de espesor que se coloca bajo las placas aislantes en forjados en contacto directo con el terreno para evitar el ascenso por capilaridad de humedades. Resistencia a la difusión del vapor de agua SD20. Dimensiones rollo: 50 m x 1,5 m.
Lámina de aislamiento acústico Rothsilent Lámina de polietileno reticulado flexible de 5 mm que se coloca bajo las placas lisas o de nopas y mejora en 20 dB el comportamiento acústico del forjado a ruidos de impacto, y en 8 dB a ruido aéreo. Resistente a la humedad y a la difusión de vapor. Ayuda a cumplir CTE DB HR (protección frente al ruido). Capa de mortero recomendada sobre la lámina: entre 4 y 5 cm. Dimensiones rollo: 15 x 1 m.
Desbobinador plegable para tubo
Muy útil para desenrollar rápidamente el tubo durante la instalación de un suelo radiante. Incorpora sistema de rodillos para asegurar el giro del rollo de tubo y una argolla lateral para desenrollar la bobina a través de ella. Suministro en bolsa con asas para su transporte. Apto para todos los formatos de tubo Roth X-PERT 16 y 20.
Carro de transporte
Ayuda ideal para transportar y manejar el tubo con facilidad por toda la instalación. Apto para todos los formatos de tubo Roth X-Pert Ø 16 y para rollos de 500 m. de tubo Ø 20. Apto también para tubo multicapa AluLaserFlex Ø16 en rollo de 600 m.

Tijera cortatubos monocorte
Sencilla y ligera. Diseñada para dar un corte limpio, cómodo y rápido. Sirve para tubos de polietileno reticulado y multicapa hasta Ø 26.
Rollo 25 m 1135002831 1,00 €/m
Caja 10 perfiles (1,80 m por perfil) 4310100003 16,88 €/ud
Rollo 75 m² 1135000263 1,48 €/m²
Rollo 15 m² 4310300030 4,60 €/m²









1 ud 4310100006 298,00 €/ud
1 ud 4011010006 778,00 €/ud
1 ud 1400214026 40,00 €/ud
Modelo Suministro Referencia PVPColectores compactos 1” HKV-CL (con caudalímetro) Colector de ida y retorno en latón, rosca macho 1” en ambos lados y salida a circuitos con conexión cónica ¾”. Colector de ida con indicador de caudal incorporado para cada circuito, para equilibrado hidráulico de los mismos. Colector de retorno con válvulas termostatizables M30 con caperuza de cierre manual, sustituible por actuador electrotérmico. Soporte insonorizado. Incluye terminal de llenado/vaciado y purgador.
Colector Compacto con caudalímetro HKV-CL 3 296
Especificaciones técnicas Salidas 3-12 Conexión al distribuidor rosca macho Ø 1” Salida a circuitos conexión cónica ¾” Caudal máximo 2,88 m3/h Temperatura máxima 70 ºC Presión máxima 6 bar Profundidad del colector 76 mm

Colector Compacto con caudalímetro HKV-CL 4 346 1 ud 1115009798 240,00
Colector Compacto con caudalímetro HKV-CL 5 396 1 ud 1115009799 278,00
Colector Compacto con caudalímetro HKV-CL 6 446 1 ud 1115009800 320,00
Colector Compacto con caudalímetro HKV-CL 7 496 1 ud 1115009801 358,00
Colector Compacto con caudalímetro HKV-CL 8 546 1 ud 1115009802 398,00
Colector Compacto con caudalímetro HKV-CL 9 596 1 ud 1115009803 436,00
Colector Compacto con caudalímetro HKV-CL 10 646 1 ud 1115009804 478,00
Colector Compacto con caudalímetro HKV-CL 11 696 1 ud 1115009805 510,00
Colector Compacto con caudalímetro HKV-CL 12 746 1 ud 1115009806 552,00 *Las válvulas de corte aumentarán la longitud del colector 70mm.


Colector para suelo radiante refrescante que se monta a mano y permite de manera rápida y sencilla disponer siempre de las salidas de circuito necesarias para cada instalación. El kit base incluye purgadores manuales, grifos de llenado/vaciado, 2 termostatos, tapones de cierre, 2 soportes y abrazaderas. Cada módulo de ida + retorno incorpora caudalímetro en el ida y válvula termostatizable M30 en retorno. Disponibles accesorios opcionales como purgadores automáticos y bypass de presión diferencial.




técnicas Material PA66-GF30
Salidas 2-14 Conexión al distribuidor rosca hembra Ø 1” Salida a circuitos conexión cónica ¾” Caudal máximo 3,5 m3/h Temperatura máxima 3 bar 90 ºC Temperatura máxima 6 bar 60 ºC Profundidad del colector 79 mm


Apto para instalaciones de calefacción y refrescamiento, se adapta automáticamente a las condiciones de la instalación gracias a la tecnología de válvula dinámica Roth Thermaset. Una vez aplicados los ajustes necesarios en las válvulas dinámicas de cada circuito, ya no es necesario realizar nuevos reajustes aunque las condiciones hidráulicas cambien. Si hay estancias que ya han llegado a la temperatura ambiente deseada y el termostato cierra los actuadores de sus circuitos, las válvulas Thermaset del colector garantizan que el resto de circuitos no reciban más caudal del necesario evitando excesos. Es posible acoplar termómetros de contacto al colector que se suministran por separado.
Material PA66 reforzada con fibra de vidrio
Conexión al distribuidor rosca hembra Ø 1”
Salida a circuitos conexión cónica ¾”
Métrica de las válvulas termostatizables M 30x1,5

Temperatura/presión max. de servicio 60ºC/6bar | 90ºC/3bar
Rango de trabajo 0,5 - 5 mca (presión diferencial)
Rango de control dinámico Thermaset 2 - 5 mca (presión diferencial)
Rango de ajuste de caudal 0,3 l/min a 5,6 l/min
Caudal máximo 300 l/h por circuito
Caja blanca empotrable para colectores
Cajas empotrables con marco frontal y puerta extraíble, lacadas en blanco. Regulables tanto en profundidad (75 - 150 mm) como en altura (790 - 880 mm). Chapa frontal guía para mortero y doble media caña protectora del tubo. Incorpora pletinas de fijación para colector. Apertura y cierre sin llave (coin lock). El embalaje de cartón puede recortarse y utilizarse como tapa de caja provisional durante la instalación para evitar que se dañe la tapa definitiva.
Dimensiones (mm) ancho interior ancho exterior Altura Profundidad
R550 550 600 790-880 75-150
R750 750 800 790-880 75-150
R950 950 1.000 790-880 75-150 R1150 1.150 1.200 790-880 75-150
Caja Blanca Empotrable R550
Caja Blanca Empotrable R750
Caja Blanca Empotrable R950
Caja Blanca Empotrable R1150

1 ud 1135007567 172,00 €/ud
1 ud 1135007568 190,00 €/ud
1 ud 1135007569 210,00 €/ud
1 ud 1135007570 245,00 €/ud
Para unir el tubo al colector. Incluye racor loco hembra ¾”, anillo opresor y tetina de soporte con eurocono y junta tórica. Opcionalmente se puede colocar el racor doble para instalar 2 circuitos de similar longitud utilizando una única salida de colector.
Racor 11 x 1,3 mm - ¾”
Racor 16 x 2 mm - ¾"
Racor 20 x 2 mm - ¾"



Racor doble ¾” - ¾”
Codo guía
Accesorio para doblar el tubo en ángulo de 90º hacia el colector o protegerlo en esquinas, rozas, etc. Válido para tubo Ø 16 y Ø 20 mm.

Codo guía para tubo Ø16
Codo de plástico rígido para doblar el tubo Ø 16 mm con seguridad y precisión en ángulo de 90º hacia el distribuidor o protegerlo en esquinas, rozas, etc.
Diseñado para ocasiones en las que se ha dañado la tubería y no es posible retirar el circuito completo. Formado por manguito macho-macho y 2 racores para tubo Ø 11, Ø 16 o Ø 20 según modelo.
Kit de reparación Ø 11
Kit de reparación Ø 16
Kit de reparación Ø 20
Tapón de cierre para circuitos
En caso que un circuito de colector no vaya a ser utilizado, cerrarlo desde su válvula y colocar este tapón para evitar posibles goteos de agua.
Válvulas de corte de esfera 1” con termómetro para colector HKV-CL
Juego de 2 válvulas de esfera de corte para colector de ida y retorno, fabricadas en latón, con rosca macho 1” y racor loco de unión con rosca hembra. Incluyen termómetros de medición tanto en ida como en retorno.
Válvula de corte de esfera 1” sin termómetro para colector HKV-CL
Válvula de corte de esfera para colector de ida o retorno, fabricada en latón, con rosca hembra 1” y racor loco de unión con rosca hembra.
Válvulas de corte de esfera para colector plástico
Juego de 2 válvulas de corte de esfera para colector plástico, fabricadas en latón, con rosca de unión macho 1” y rosca de salida hembra 1”. Compatible con colector plástico modular y colectores Thermaset.
Válvula de zona gran caudal sin actuador
1 ud 1135006677 11,90 €/ud
Bolsa 10 ud 1135005189 3,85 €/ud
Bolsa 10 ud 1135005201 3,85 €/ud
Bolsa de 2 ud 1135004001 37,16 €/ud
1 ud 4013010415 2,24 €/ud


1 ud 4310300032 1,81 €/ud


Conjunto formado por una electroválvula de 2 vías de 1" y válvula de corte 1" manual. Combinando la electroválvula con un actuador, permite controlar la apertura/cierre de suministro de agua a un colector de suelo radiante completo mediante un termostato. No incluye actuador. Incluye adaptador VA80.

1 ud 1135003446 24,93 €/ud
1 ud 1115007910 22,00 €/ud
1 ud 1135000279 21,53 €/ud
1 ud 1135000354 3,40 €/ud


1 juego (2 ud) 1150008821 79,00 €/ juego
1 ud 1135006454 28,00 €/ud
1 juego (2 ud) 4310586298 42,00 €/ juego
1 ud 4310206691 98,00 €/ud
Aditivo para el mortero AD 10
Proporciona una gran eficacia fluidificante y plastificante al mortero del suelo radiante. No ataca al plástico ni al metal.
Dosificación: mezclar el aditivo previamente con el agua (1 litro aditivo en 200 litros de agua) y remover bien. Utilizar esta mezcla para preparar el mortero con cemento y arena. Rendimiento aprox. 1 bidón de 10 litros para 250 m² de mortero (45 mm de espesor por encima del tubo). Por cada 50 kg de cemento utilizar 0,1 kg de aditivo AD 10.
Aditivo para mortero AD 25 Plus
Aditivo de elevada eficacia fluidificante y plastificante especialmente diseñado para morteros de capa fina. No ataca al plástico ni al metal.
Dosificación: añadir directamente a la mezcla cementoarena en una proporción de 5% del peso del cemento. Rendimiento aprox. 1 bidón de 25 litros para 30 m² de mortero (30mm de espesor por encima del tubo). Añadir fibra de vidrio si fuese necesario (200 gramos por hormigonera de 200 litros).
Aditivo para limpieza
Producto limpiador/desincrustante, para instalaciones de calefacción/refrigeración por suelo radiante. A base de ácidos orgánicos biodegradables, incorpora un aditivo de protección que asegura una perfecta limpieza del sistema sin dañar los metales presentes en el circuito. Elimina las incrustaciones calcáreas y los óxidos de hierro así como la biocapa existente y los lodos.

Dosificación: 1 a 2 kg por cada 200 l de volumen del circuito, en función del grado de limpieza que se necesite. Dejar actuar durante 2 semanas manteniendo la temperatura del sistema entre 35 - 60 ºC, después vaciar por completo el circuito y enjuagar con agua (desionizada y prefiltrada), llenar de nuevo el circuito, es aconsejable incorporar el aditivo protector/anticorrosivo Roth.
Aditivo protector/anticorrosivo
Contra la corrosión e incrustaciones en circuitos cerrados de calefacción-refrigeración. Gracias al biocida que incorpora, impide el crecimiento de bacterias y microorganismos en el circuito. Asegura el buen estado de los metales que normalmente se utilizan en estas instalaciones, incluyendo el cobre, acero, hierro fundido, latón, aluminio etc. En instalaciones con óxido en el circuito, usarlo sólo después de haber efectuado la limpieza con el aditivo de limpieza.
Dosificación: entre el 1% y el 1,5% del volumen del circuito.
Bidón 10 litros 4013010061 102,00 €/ud
Bidón 25 litros 4013010062 325,00 €/ud
Aditivo protector/anticongelante GLR-20




Anticongelante refrigerante altamente concentrado que evita la formación de incrustaciones en el circuito. En instalaciones con síntomas de óxido o antiguas, proceder previamente a una limpieza con el aditivo de limpieza.
Dosificación: 1 garrafa por cada 200 l de volumen de circuito. Diluir en agua descalcificada o destilada.
Bote 2 kg 2000550006 60,00 €/ud
Bote 2 kg 2000550002 38,00 €/ud
Garrafa 20 litros 6020100344 155,00 €/ud
Tabla de precios orientativa. Solicite de forma gratuita su estudio y presupuesto personalizado enviando planos a escala a tecnico@roth-spain.com
Sistema original de placa lisa
Sistema de placa de nopas
Sistema ClimaComfort
Tubo X-PERT S5
Acabado plastificado Acabado termoconformado
Lisa 25 (Resist. térmica 0,75 m2K/W)
Lisa 26 (Resist. térmica 0,70 m2K/W)
Lisa 30 (Resist. térmica 0,85 m2K/W)
Lisa 30 en rollo (Resist. térmica 0,75 m2K/W)
Lisa 44 (Resist. térmica 1,25 m2K/W)
Nopas 23 Térmica (Resist. térmica 0,75 m2K/W)
Nopas 38 Térmica (Resist. térmica 1,25 m2K/W)
Nopas Stark 13 (Resist. térmica 0,35 m2K/W)
Nopas Stark 27 (Resist. térmica 0,75 m2K/W)
ClimaComfort Compact 17 mm Ø Paso
€/m2 50,05 €/m2 58,72 €/m2 20 cm 43,48 €/m2 48,49 €/m2 47,40 €/m2 43,27 €/m2 51,75 €/m2 22,5 cm 43,88 €/m2 52,54 €/m2 16 mm
7,5 cm 64,99 €/m2 73,66 €/m2 10 cm 55,92 €/m2 60,93 €/m2 59,84 €/m2 55,71 €/m2 64,20€/m2 59,35 €/m2 62,91 €/m2 71,09 €/m2 15 cm 46,99 €/m2 51,99 €m2 50,90 €/m2 46,78 €/m2 55,26 €/m2 46,73 €/m2 55,40 €/m2 46,95 €/m2 53,13 €/m2 55,65 €/m2 20 cm 42,16 €/m2 47,16 €/m2 46,07 €/m2 41,31 €/m2 50,42 €/m2 47,90 €/m2 51,46 €/m2 59,64 €/m2
22,5 cm 42,83 €/m2 51,49 €/m2
Precios sin IVA ni transporte
Zonificación de suelo radiante Termostatos con cable frío/calor pág. 74

Zonificación de suelo radiante Sistema inalámbrico Touchline SL8 frío/calor pág. 76






Zonificación de suelo radiante y climatización por aire Sistema Rothaclima pág. 78
Grupos de impulsión frío/calor y bombas pág. 82
Otros componentes pág. 84

¿Encenderías todas las luces de casa desde un solo interruptor?
Con los últimos cambios de normativa RITE, los edificios de nueva construcción deberán tener instalados, en la medida que sea viable económica y técnicamente, dispositivos que permitan controlar por separado la temperatura ambiente de cada estancia. De esta manera se garantiza el confort en el 100% de las estancias y el usuario tendrá la posibilidad de conectar la climatización solo en las estancias que desee.
Para este requerimiento, es posible instalar termostatos con cable DayLine o cronotermostatos con cable WeekLine por cada estancia. Ambos permiten el control del suelo radiante tanto en calefacción como en refrescamiento con un diseño atractivo y un fácil manejo para el usuario final.


Se alimentan a pilas y se conectan al dispositivo a controlar mediante 2 hilos.
El Termostato DayLine incorpora display de gran formato y dos niveles de temperatura de selección manual. El Cronotermostato WeekLine permite programar horarios de funcionamiento con dos niveles de temperatura y el cambio frío/calor se realiza mediante un selector en la parte superior para facilitar el uso por parte de propietario. Incorpora pantalla de tinta electrónica E-Ink de muy bajo consumo.
La curva gris muestra cómo un termostato general en la Estancia 1, que controla todas las estancias, reduce por debajo del 50% el nivel de confort del resto de estancias y cómo al instalar un termostato en cada estancia, todas ellas consiguen el 100% de confort (zona roja).
Zonificación por estancias, con módulo de conexiones C6
3 A bomba
1 1 2
Descripción
Cantidad x instalación
1 Termostato DayLine o Cronotermostato WeekLine 1 x habitación 2 Actuador 230 V, 1 W sin corriente cerrado 1 x circuito 3 Módulo de conexiones C6 Basicline 230 V 1 x colector





Control de temperatura de impulsión no incluido. Consultar página 82
Zonificación por estancias, con actuadores de 4 hilos (con final de carrera)
Descripción
1 1 2 2 3 3
Cantidad x instalación
1 Termostato DayLine o Cronotermostato WeekLine 1 x habitación
2 Actuador 230 V, 1 W sin corriente cerrado total circuitos - nº termostatos
3 Actuador 230 V, 1 W NC con final de carrera NA 1 x termostato
4 Adaptador para actuador M30 x 1'5 VA90 Rojo 1 x termostato
Control de temperatura de impulsión no incluido. Consultar página 82
Zonificación por colector, con actuadores de 4 hilos (con final de carrera)
Descripción
Cantidad x instalación
1 Termostato DayLine o Cronotermostato WeekLine 1 x colector
2 Válvula de zona sin actuador 1 x colector
3 Actuador 230 V, 1 W NC con final de carrera NA 1 x colector
Control de temperatura de impulsión no incluido. Consultar página 82
Zonificación por estancias, con módulo de conexiones C10 y sonda anticondensación
Descripción
Cantidad x instalación
1 Termostato DayLine o Cronotermostato WeekLine 1 x habitación 2 Actuador 230 V, 1 W sin corriente cerrado 1 x circuito 3 Módulo de conexiones C10 Basicline 230 V 1 x colector
4 Transformador 230 Vac - 24 Vac 1 x colector
5 Sonda anticondensación 24V 1 x colector
Control de temperatura de impulsión no incluido. Consultar página 82
Esquemas y componentes para la zonificación de suelo radiante Modelo Referencia PVP €/ud
Actuador 230 V, 1 W NC con final de carrera NA (no incluye adaptador) 4310227046 39,50
Adaptador para actuador M30 x 1’5 VA90 Rojo (para colectores HKV-CL y plástico) 1135007497 3,40
Válvula de zona gran caudal sin actuador (incluye adaptador VA80) 4310206691 98,00 Módulo de conexiones C6 Basicline 230 V 1135007708 138,00 Módulo de conexiones C10 Basicline 230 V 1135008500 148,00
Transformador 230 Vac - 24 Vac 2100000001 86,00 Sonda anticondensación 24V para módulo C10 Basicline 6466540206 148,50


Control eficiente de sistemas de suelo radiante para frío y calor para el máximo ahorro y confort

El termostato de ambiente es uno de los componentes más importantes de un sistema de climatización. En el mercado encontraremos termostatos bimetálicos simples, normalmente de ruleta, y termostatos electrónicos. Dentro de estos últimos existen sistemas inteligentes que gestionan la temperatura de una manera más eficaz, como Roth Touchline SL8, que suponen ahorros importantes respecto a los simples. Nuestro sistema incluye un módulo de conexiones al que se sincronizan de manera inalámbrica
hasta 8 termostatos con un diseño minimalista, controles táctiles y una sencilla integración con el entorno. Permiten un control extremadamente preciso de la temperatura ambiente por estancia y consigue elevados ahorros respecto a otros termostatos del mercado. Además permite configurar programas horarios y así adaptar el sistema a nuestro estilo de vida. Con Roth Touchline SL8 podemos controlar eficazmente sistemas de suelo radiante para calefacción y refrescamiento. Cada termostato mide la temperatura interior y

la humedad relativa. En caso de que la estancia supere un grado de humedad fijado por el usuario, el termostato de esa estancia cerrará el paso de agua fría a esos circuitos de suelo radiante. Para el control de instalaciones grandes con varias plantas o varios colectores de distribución es posible configurar una comunicación “Maestro-Extensiones” de hasta 5 módulos de conexiones de forma inalámbrica.
Con este sistema evitamos cablear el termostato hasta el colector de distribución. Únicamente necesitamos colocar las 2 pilas incluidas en el suministro y el termostato estará preparado para sincronizarse. Gracias a este sistema, los termostatos Touchline SL8 son ideales para rehabilitaciones en las que no queremos realizar rozas en las paredes para pasar cables.
Si desea que el sistema pase totalmente desapercibido, puede colocar mini sondas interiores en lugar de termostatos. Estas sondas no necesitan cableado eléctrico, se alimentan a pilas, son casi invisibles (37 x 37 x 16 mm) y se controlan desde el Módulo de conexiones o desde la App para Smartphone.

Puesta en marcha rápida e intuitiva
La configuración de los termostatos Touchline SL8 es totalmente intuitiva. En apenas unos segundos podemos sincronizarlos con la estancia que queremos climatizar. Además, podemos interconectar hasta 40 termostatos a través de 5 módulos sin cables para crear grandes instalaciones y adaptarnos a cualquier requerimiento.


 Zonificación de suelo radiante
Zonificación de suelo radiante
Calefacción y refrescamiento. Confort todo el año

El sistema Roth Touchline SL8 se puede utilizar tanto para calefacción como para refrigeración por suelo radiante. Un solo sistema de control para verano e invierno.
Sensor de humedad Además del control de la temperatura, el termostato Roth Touchline SL8 Standard incorpora un sensor de humedad. A partir de determinados niveles, la circulación de agua fría se detendrá en la estancia para evitar condensación en el suelo.



ErP Clase IV
Los sistemas de control se dividen en 8 grupos según el porcentaje de eficiencia que aportan al sistema de climatización. Roth Touchline SL8 se clasifica como clase IV y aporta un +2%.



La eficiencia y la eficacia de un sistema de climatización que combina suelo radiante y aire dependen en gran parte del sistema de control que los gestione. Además de ser fiables, su uso ha de ser sencillo para ofrecer una buena experiencia de uso.

El nuevo sistema Rothaclima combina todos esos aspectos para garantizar el confort durante todo el año con facilidad para los usuarios ya que podrán elegir la temperatura ambiente deseada en cada zona. El sistema se ocupará de conseguirla mediante el suelo radiante o mediante el aire de forma automática.

Todos los componentes del sistema se interconectan mediante módulos y pasarelas de comunicación para un funcionamiento organizado y coordinado. Además, todo puede ser controlado a distancia mediante App para Smartphone y asistentes de voz como Alexa o Google Home.
Un termostato por zona para un control total
El termostato híbrido Rothaclima permite el control del suelo radiante en calefacción y en refrescamiento así como el control de la climatización por aire mediante rejillas motorizadas, fancoil o splits de apoyo. Dos configuraciones disponibles: centralita para control de una sola zona de aire y suelo radiante refrescante o centralita para zonificación con varios termostatos.


Control de caudales de aire y humedad
El termostato de cada zona regulará la velocidad del ventilador proporcionalmente al tamaño de cada estancia. Además, al integrar sensor de humedad, cada termostato se asegurará de que no que se producen condensaciones en el suelo cuando esté en marcha el suelo refrescante.
Integración con domótica y fotovoltaica Todo el sistema Rothaclima es integrable mediante pasarelas a sistemas domóticos KNX, Loxone y Fibaro. Además, es posible aprovechar los excesos de producción de un sistema fotovoltaico y utilizar el suelo de la casa como una batería de calor o frío.


NOVEDAD
Suelo Radiante

El sistema Rothaclima controlará todo sistema de climatización por zonas que combine suelo radiante frío/calor y aire frío/calor garantizando un óptimo funcionamiento. Esta versátil solución puede ser integrada en cualquier tipo de instalación residencial, así como edificios de uso terciario. Utilizando el módulo de suelo



radiante, controlará cada circuito de manera independiente, y con las diferentes pasarelas de comunicación disponibles podrá controlar el equipo de aire acondicionado de la instalación: fancoil tipo cassete, fancoil por conductos con rejillas motorizadas, equipos de expansión directa...Además, podrá enviar órdenes de arranque/
paro y modo de funcionamiento frío/calor al equipo de producción (bomba de calor, aerotermia, equipos VRF, enfriadoras...) de manera que se garantice el óptimo funcionamiento del equipo adaptando las prestaciones a las necesidades reales del usuario.
Termostato híbrido Rothaclima
Central Rothaclima 7 zonas suelo frío calor
Actuadores 230 V



Según RITE, siempre que sea posible, los sistemas de climatización deben estar equipados con dispositivos que regulen separadamente la temperatura ambiente en cada espacio interior
con el fin de garantizar el confort del usuario y reducir el consumo energético. El sistema Rothaclima le permitirá zonificar cada estancia y controlar tanto el suelo radiante como el aire
Central Rothaclima 7 zonas aire frío calor y pasarelas para ventilador
Rejillas motorizadas de impulsión
Termostato híbrido Rothaclima
acondicionado, ambos en modo frío o calor, para asegurar el confort en toda la vivienda aprovechando al máximo el equipo de producción.
Modulo Rothaclima 1 zona suelo y fancoil 3V
Centralita encargada de gestionar una zona suelo radiante refrescante y fancoil de 3 velocidades mediante un único termostato híbrido Rothaclima. Incorpora salidas adicionales para bomba de suelo radiante, bomba de fancoil, modo de funcionamiento (frío/calor) y equipo en funcionamiento (suelo radiante/fancoil).
Termostato híbrido Rothaclima
Termostato táctil Roth con pantalla capacitiva a color de 3,5" muy intuitivo para el usuario final. Con lectura de temperatura ambiente y humedad relativa. Permite elegir entre 5 modos de funcionamiento automáticos para combinar suelo radiante frío/calor y aire frío/calor. Posibilidad de crear hasta 6 programaciones horarias para adaptarse a su estilo de vida. Con función parada total del sistema y control remoto del resto de termostatos de la instalación. Disponible en dos colores
Termostato híbrido Rothaclima color negro
4410400123 168,00
4410400202 168,00
Termostato híbrido Rothaclima color blanco 4410400101 168,00
Cable bus Rothaclima 3x0,25 mm² (rollo 100m)
Apantallado y libre de halógenos. Apto para conectar entre sí el termostato híbrido Rothaclima con el Modulo Rothaclima 1 zona suelo y fancoil 3V. Importante: este cable no debe ser instalado junto a cableado eléctrico para evitar pérdidas de comunicación.
4410403025 102,80
Central Rothaclima 7 zonas aire frío calor Módulo de control central con bus de comunicación para 7 termostatos híbridos Rothaclima. Posibilidad de conectar hasta 2 centrales Rothaclima 7 zonas suelo radiante frío calor. Bus de comunicación para conectar hasta 14 pasarelas para ventilador directo de 3 velocidades o hasta 2 pasarelas de ventilador de 3 velocidades para sistema por conductos (conexiones para 7 rejillas motorizadas). Salidas on aire enfrío/on aire en calor para control de la producción y/o bomba de fancoil. Apto para integración domótica KNX, Loxone y Fibaro con la pasarela adecuada. Posibilidad de aprovechar los excedentes de una instalación fotovoltaica para aumentar la eficiencia energética.







Central Rothaclima 7 zonas suelo radiante frío calor Controla los actuadores 230V de un colector de suelo radiante. Conectado a la central Rothaclima 7 zonas aire frío calor, permite la gestión total de un sistema de climatización por suelo radiante y aire de hasta 7 zonas. Incorpora salida para bomba de suelo radiante y doble salida adicional de suelo radiante on calor / on frío para control de la producción. Posibilidad de configurar un termostato para control de hasta 3 zonas al mismo tiempo.
Actuador 230 V, 1 W sin corriente cerrado Diseñados para permitir el control independiente de cada circuito de suelo radiante. Ajuste NC de dos hilos
Termostato híbrido Rothaclima
Termostato táctil Roth con pantalla capacitiva a color de 3,5" muy intuitivo para el usuario final. Con lectura de temperatura ambiente y humedad relativa. Permite elegir entre 5 modos de funcionamiento automáticos para combinar suelo radiante frío/calor y aire frío/calor. Posibilidad de crear hasta 6 programaciones horarias para adaptarse a su estilo de vida. Con función parada total del sistema y control remoto del resto de termostatos de la instalación. Disponible en dos colores
4410400201 241,50
4410400105 120,75
1135007412 36,00
Termostato híbrido Rothaclima color negro 4410400202 168,00
Termostato híbrido Rothaclima color blanco 4410400101 168,00

 Modelo Referencia PVP €/ud
Modelo
Referencia PVP €/ud
Modelo Referencia PVP €/ud
Modelo
Referencia PVP €/ud
Pasarelas Rothaclima para ventilador Aptas para gestión y control de equipos aire-agua. Disponibles varias opciones en función del equipo a controlar y del tipo de control deseado.
Pasarela Rothaclima ventilador 3 velocidades 4410400003 105,00

Pasarela Rothaclima ventilador 1-10 V 4410400110 147,00

Pasarela Rothaclima expansión directa o VRF Consultar
Módulo WIFI Rothaclima Conectado al Modulo Rothaclima 1 zona suelo y fancoil 3V o a la Central Rothaclima 7 zonas aire frío calor, permite controlar todos los termostatos y por lo tanto todo el sistema desde una App para Smartphone o Tablet y tambien desde navegador web.

Módulo Rothaclima integración KNX
4410400109 94,50
Permite integrar el sistema Rothaclima a un sistema domótico mediante protocolo KNX. 4410400111 168,00



Rejillas motorizadas de impulsión Compatibles con sistema Rothaclima. Fabricadas en aluminio. Lamas delanteras verticales y orientables. Lamas traseras motorizadas. Color blanco. Fijación con clip.
Rejilla motorizada Rothaclima 300x150 mm 4410403150 161,96
Rejilla motorizada Rothaclima 400x150 mm 4410404150 163,43
Rejilla motorizada Rothaclima 500x150 mm 4410405150 169,89

Otras dimensiones y formatos Consultar
Rejillas simples de retorno Fabricadas en alumnio. Lamas horizontales y orientables. Color blanco. Fijación con clip. Necesario instalar una de las mismas dimensiones por cada rejilla motorizada.
Rejilla retorno Rothaclima 300x150 mm 4410413150 10,24
Rejilla motorizada Rothaclima 400x150 mm 4410414150 11,76
Rejilla motorizada Rothaclima 500x150 mm 4410415150 13,34
Otras dimensiones y formatos Consultar
Marco de montaje para rejillas Fabricados en chapa de acero galvanizada (estampada).Combinar largueros con las longitudes necesarias para formar el marco. Ejemplo para rejilla 300x150: 2 largueros 300mm y 2 largueros 150mm.
Larguero 150 mm para montaje de rejilla 4410400150 0,52


Larguero 300 mm para montaje de rejilla 4410400300 0,99
Larguero 400 mm para montaje de rejilla 4410400400 1,26
Larguero 500 mm para montaje de rejilla 4410400500 1,64
Otras dimensiones Consultar
Bobinas de cable
Aptos para conectar entre sí todos los elementos de un sistema Rothaclima. El cable bus de 3 hilos (apantallado libre de halógenos) se usa para comunicar los termostatos, pasarelas y central de suelo radiante con la central de aire. El modelo de dos hilos se usa para conectar las rejillas motorizadas con la central de aire. Para una buena comunicación este cable no debe instalarse junto a cableado eléctrico.
Cable bus Rothaclima 3x0,25 mm² (rollo 100m)
4410403025 102,80
Cable Rothaclima 2x0,75 mm² (rollo 100m) 4410402075 71,03
Conexiones grupo hidráulico DN25
Modelo de bomba Wilo Yonos Para SC 25/1-7,5*
Carcasa aislante EPP
Sonda temperatura impulsión PT1000 Rango de temperaturas (ºC) 0-99ºC


*El modelo de bomba suministrado con el grupo podría variar, sin afectar al rendimiento
Funcionamiento en calor
Funcionamiento en frío
Conjunto formado por un grupo hidráulico con carcasa aislante y mezcladora de 3 vías con servomotor autónomo (sin necesidad de centralitas externas). El usuario podrá elegir la temperatura de impulsión tanto en calefacción como en refrescamiento.
Ideal para instalaciones de suelo radiante refrescante donde la bomba de calor no incorpore control de temperatura de impulsión o para

instalaciones combinadas de suelo radiante refrescante y airea condicionado por fancoil. También donde exista un depósito de inercia que almacene agua a la temperatura requerida un depósito de inercia que almacene agua a la temperatura requerida por el fancoil y sea necesario controlar la temperatura de impulsión al suelo radiante en calefacción y en refrescamiento de una manera sencilla.
Grupo hidráulico frío calor sin servomotor 4410300756 795,00

Diseñado para conectar directamente al colector Roth y así quedar ambos elementos dentro de la caja empotrable. Se encarga de reducir la temperatura de agua que suministra el generador de calor y bombearla hacia los circuitos de suelo radiante. Incluye todos los componentes y elementos hidráulicos necesarios para facilitar su instalación. Válvula mezcladora de 3 vías con accionador termostático. Termostato de seguridad con rearme automático incluido (temperatura de desconexión: 58 ºC).
Temperatura máx. de trabajo (ºC) 90
Presión máx. de trabajo (bar) 6 bar
Potencia máxima (kW) 14
Rango de temperaturas (ºC) 20 - 50
Profundidad mínima de caja (mm) 150
Servomotor electrónico para grupo hidráulico frío calor 4410300332 395,00 Modelo

Grupo de impulsión AE Horizontal 1135007401 825,00
Grupo de impulsión a punto fijo* 4410300055 825,00
*Hasta fin de existencias.
7
Circuladores de rotor húmedo de alto rendimiento y diseño ultraligero ideales para su uso en instalaciones de suelo radiante tanto en calefacción como en refrescamiento.
Con 3 modos de bombeo (presión proporcional, presión constante y velocidad constante) y 3 curvas por modo. Una pulsación en el botón cambia de la primera curva (azul) a la segunda (verde) y luego a la tercera (naranja). Después de alcanzar la tercera curva y presionar nuevamente el botón, el modo de bombeo cambia y se selecciona la primera curva de ese modo.
Tensión de conexión 1-230 V
Potencia nominal Mín. 1 W, máx. 50 W
EEI 0.18
Protección IP 44 DN 25 mm (roscas G 1"1/2)

Distancia entre ejes 130 mm
1
5
2
3
11
8
Velocidad constante
Pérdida de carga (m) 1,5 2 3 3,5 4 4,5 5 2,5
6
4
9 0,5 1
10
proporcional Presión constante
Disponibles dos modelos (25-80 y 25-100) para adaptarse al tamaño de la instalación. Ambas incluyen carcasa aislante y racores de conexión. 0 0
Caudal (m3/h)
Velocidad constante
Presión proporcional Presión constante 5,5 6
Válvulas mezcladoras 3 vías de asiento con servomotor Conjunto compuesto por válvula 3 vías, 3 racores y servomotor eléctrico 230V a 3 puntos.
DN 20 (¾") Kvs 6,3
4410000010 430,00
DN 25 (1") Kvs 10 4410000008 460,00
DN 32 (1 ¼") Kvs 16 4410000011 530,00
Recambios servomotor válvulas mezcladora de asiento
Recambio servomotor AVM para mezcladora DN20, DN25 y DN32 4410000006 255,00


Recambio servomotor AVM para mezcladora DN40, DN50 4410000007 275,00
Recambio servomotor SSC para mezcladora DN20, DN25 y DN32 4410500057 255,00
Separador hidráulico con aislamiento 1”
En instalaciones en las que es necesario instalar una bomba adicional a la bomba del generador de calor porque ésta no es suficiente para mover el caudal requerido por el suelo radiante, se recomienda colocar este dispositivo separador para evitar anomalías en el sistema hidráulico. Formado por un cuerpo de acero inoxidable de 2” y cuatro conexiones hembra 1”. Incluye purgador, válvula de vaciado y carcasa termoaislante.
Actuadores para colectores y válvulas Diseñados para permitir el control independiente de cada circuito de suelo radiante. Ajuste NC, normalmente cerrado (sin tensión, circuito cerrado). Disponibles modelos de 2 hilos para conexión a termostato mediante Módulo de conexiones Basicline o Touchline SL8 y modelos de 4 hilos con final de carrera NA. El modelo de 2 hilos incorpora adaptador VA90 para colectores de latón HKV-CL o colector plástico modular. El modelo de 4 hilos no incorpora adaptador (seleccionar el adaptador necesario).


4410000026 262,00
Actuador 230 V, 1 W sin corriente cerrado 1135007412 36,00
Actuador 24 V, 1 W sin corriente cerrado 1135007413 36,00
Actuador 230 V, 1 W NC con final de carrera NA 4310227046 39,50
Adaptador para actuador 1 W M28 x 1’5 VA16 Rojo Válido para colectores Roth de latón antiguos con mecanismo termostático M28. 4310108468 5,30

Adaptador para actuador 1 W M28 x 1’5 VA64 Gris Válido para colectores Roth de plástico antiguos con mecanismo termostático M28. 4310102815 5,30


Adaptador para actuador 1 W M30 x 1’5 VA80 Blanco Válido para válvula de zona 4310206691 con mecanismo termostático M30 1135007498 3,40

Adaptador para actuador 1 W M30 x 1’5 VA90 Rojo Válido para colectores Roth de latón HKV-CL y plástico modulares actuales con mecanismo termostático M30. 1135007497 3,40

Suelo Radiante
conformescon UNEUNE-ENISO22391-1:2010 -ENISO22391-2:2010 MarcaComercial ROTHIBERICA



para instalaciones de agua calientey fría




años

por un


El uso eficiente del agua es el mayor reto al que la humanidad se enfrenta en el siglo XXI. Entre otros efectos, el cambio climático está provocando un acceso más irregular a este recurso. Por este motivo, acumular y reutilizar el agua es ya una necesidad en muchas zonas de nuestro país para poder continuar con el crecimiento y desarrollo económico.
Para ello, Roth le ofrece la mayor oferta de depósitos y equipos para la acumulación y reutilización de aguas potables, grises y pluviales. Estos
depósitos están fabricados en polietileno de alta densidad (PEAD) mediante el sistema de extrusión soplado, sin costuras ni soldaduras y de una sola pieza, garantizando su estanqueidad.
La materia prima utilizada está homologada y autorizada por la dirección general de sanidad. El PEAD es un material ligero, con alta resistencia a golpes e impactos lo que facilita su transporte y manipulación. Este material se caracteriza por una ausencia total de poros y rugosidades, presentando una superficie completamente lisa.
De este modo su mantenimiento y limpieza se simplifican enormemente facilitando la eliminación de suciedad.

El PEAD tiene una larga vida útil, además es 100 % reciclable lo que le convierte en un aliado indispensable para un desarrollo sostenible.
Roth presenta una amplia gama de equipos diseñados para facilitar la instalación y adaptarse al espacio disponible, con modelos para instalación tanto enterrados como en superficie.



Este método permite fabricar los depósitos de una sola pieza, sin costuras ni soldaduras, obteniendo un producto de la más alta calidad.
La conservación y el uso eficiente del agua son imprescindibles para el desarrollo sostenible del planeta.
El sistema de fabricación, la alta calidad de los materiales utilizados y los exhaustivos controles en fábrica aseguran una estanqueidad total del sistema.



Fácil limpieza y mantenimiento Gracias al sistema de fabricación por extrusión soplado, a la alta calidad de los materiales utilizados y al diseño exclusivo de Roth, los depósitos no presentan poros ni rugosidades, facilitando enormemente su limpieza y precisando un mantenimiento mínimo para ofrecer las mejores condiciones sanitarias.
Sistema brida Roth
Sistema exclusivo de Roth que asegura la calidad en todas las conexiones de sus depósitos. Este componente se integra en la estructura del depósito durante el proceso de fabricación, asegurando una estanqueidad total del sistema sin debilitar el depósito.
En numerosas ocasiones, el almacenamiento del agua potable es la única manera de acceder a este recurso de forma continua, segura y sostenible. En estos escenarios es fundamental contar con un depósito que nos garantice conservar la calidad de este agua antes de su consumo final. Para ello, Roth pone a su disposición la gama de depósitos Rothagua Cerrado, la más amplia del mercado gracias a su variedad de capacidades y dimensiones. Los depósitos Rothagua Cerrado están fabricados en polietileno de alta densidad (PEAD) de una sola pieza sin costuras ni soldaduras, mediante el sistema extrusión soplado. El PEAD es un material que impide la corrosión y evita la transmisión de olores y sabores Gracias al sistema de fabricación, la calidad de los materiales empleados y los exhaustivos controles en producción, obtenemos un depósito robusto, completamente estanco, de gran calidad, económico y con la fiabilidad y garantía de la marca Roth. Así mismo, gracias a esta filosofía de trabajo, conseguimos que las paredes interiores sean completamente lisas, sin poros ni rugosidades, lo que evita la formación de incrustaciones, facilitando su limpieza y mantenimiento En la instalación, sus asas y su peso ligero facilitan su transporte y manipulación. Los depósitos pueden unirse formando baterías hasta alcanzar los volúmenes de acumulación deseados,lo que unido al carácter modular de estas baterías nos permite adaptarnos al espacio disponible y los volúmenes demandados en cualquier situación.





Sistema brida Roth, único en el mercado Esta brida se integra en la estructura del depósito durante el proceso de fabricación asegurando una estanqueidad total sin poros ni fisuras. Proporciona una salida inferior roscada para conexión y vaciado del depósito. Se incluye junta de santoprene para asegurar estanqueidad. Las partes metálicas del conjunto no entran nunca en contacto con el agua. Modelos disponibles con una o dos bridas.
Todos los depósitos Rothagua Cerrado incluyen el Registro Sanitario y su certificado de producto de construcción en contacto con agua de consumo humano, garantizando su seguridad y la de su familia.
El sistema brida asegura la calidad del agua potable en todo momento ya que en ningún momento entra en contacto el agua con la parte metálica interna. Internamente la brida dispone de pared en PEHD y su estructura metálica sirve solamente para asegurar un mayor par de apriete de sus roscas, asegurando la estanqueidad de la conexión del accesorio de vaciado al depósito.



Amplia gama de depósitos para la acumulación y gestión del agua potableVideo montaje contrabrida Interior del depósito Pared del depósito en PEAD Exterior del depósito Brida metálica con roscas





Proteja su vivienda o negocio contra cortes de suministro y disponga de suficiente acumulación de agua, instalando baterías de depósitos Rothagua Cerrado.
Nuestros depósitos están fabricados de una sola pieza, sin costuras ni soldaduras, mediante el sistema de extrusión soplado. El polietileno de alta densidad utilizado en su fabricación impide la corrosión y evita la transmisión de olores y sabores, convirtiéndolo en un material idóneo para el almacenamiento de agua. Depósitos ro-
bustos y estancos que le proporcionan la mayor seguridad en los momentos más importantes, con la fiabilidad y garantía de la marca Roth. La solución más rápida y sencilla de instalar del mercado. De fácil manipulación gracias a sus asas y a su peso ligero y sin necesidad de obra civil, reduciendo los costes y tiempos de instalación Además, la disposición modular de estas baterías le permiten adaptarse al espacio disponible en su instalación. Posibilidad de formar baterías con cualquier depósito Rothagua cerrado.
Para garantizar un caudal óptimo de aspiración, las Baterías Rothagua 12.000 litros disponen de una doble salida roscada inferior 2” Gas en cada depósito, lo que nos permite aumentar la capacidad de aspiración y el diámetro máximo del colector, adaptándose a las exigencias legales. Consulte con nuestro Departamento Técnico si precisa instalar elementos para la recirculación del agua durante las pruebas de funcionamiento o si requiere mayores volúmenes de acumulación.


La mejor solución incluso para edificios de gran altura

La versatilidad de estas baterías permite su adaptación a edificios que, por sus características estructurales, precisan de instalaciones modulares para adaptar los aljibes a su instalación.

Solución
Las Baterías Rothagua son la solución más sencilla y rápida de instalar debido a su cómoda manipulación, adaptabilidad al espacio disponible y las dos salidas inferiores de 2” Gas.
Las Baterías Rothagua proporcionan seguridad a su instalación garantizando el almacenamiento de agua necesario para cubrir contingencias.

Solución modular y versátil para formar baterías con todos los modelos de depósitos Rothagua
El carácter modular de la Batería Rothagua 12000 facilita su instalación en la obra. De esta forma, las baterías se adaptan a las características y morfología de la instalación.
Para baterías con otros modelos de Rothagua Cerrado o calcular accesorios de conexión entre depósitos consultar con nuestro departamento técnico.








Sistema de suministro continuo de agua potable con control automático de presión y caudal

El agua es un bien preciado y escaso. El cambio climático nos avoca a escenarios donde la disponibilidad de este recurso se ve afectada. Hoy en día, esta limitación en la disponibilidad de agua se deja notar especialmente en zonas rurales, sin acceso a infraestructuras, y turísticas, donde el exceso de población disminuye notablemente la disponibilidad del recurso. Gracias al sistema Rothidráulico aseguramos un suministro de agua potable ininterrumpido en el hogar. El conjunto se intercala entre la acometida de agua potable y la red interna de distribución. Se suministra premontado de fábrica e incluye control automático de bombeo y by-pass


El conjunto está fabricado con los más altos estándares de calidad del mercado. Confort y seguridad a su alcance con la garantía de la marca Roth.
El conjunto Rothidráulico es un sistema compacto, de fácil instalación y mínimo mantenimiento, por lo que un profesional con herramientas básicas puede montarlo sin esfuerzo. Todos los elementos necesarios para su montaje y correcto funcionamiento están incluidos. Su bomba sumergible es silenciosa y eficiente.
Además, el sistema automático permite que la bomba trabaje solo cuando es necesario dar suministro a la vivienda. Esto se traduce en un ahorro económico y energético
El conjunto Rothidráulico nos permite disfrutar de duchas con presión y sin cortes. Un sencillo paso para obtener el máximo confort en el hogar.
de alta densidad turística y zonas rurales y aisladas



El conjunto Rothidráulico le permite disponer agua de forma segura en zonas con escasa infraestructura y en situaciones de baja presión en la red o cortes de suministro.
El conjunto Rothidráulico incluye todos los elementos necesarios para su montaje. Instalación sencilla de un equipo compacto y premontado de fábrica que disminuye el tiempo de puesta en marcha.
Hogar Disponer de un suministro ininterrumpido de agua potable es un requisito indispensable para convertir una vivienda en un hogar.







Los depósitos Rothagua EcoCompact son la solución ideal para el almacenamiento de agua en viviendas unifamiliares, hoteles, talleres, granjas, etc. Su tamaño compacto requiere de poco espacio en la instalación. Dispone de medidas especiales para paso por puertas, pasillos y zonas estrechas. Todo esto hace de este depósito la opción más sencilla de instalar en buhardillas, sótanos y cualquier lugar de difícil acceso o con limitaciones de espacio Depósitos diseñados especialmente para mimetizarse en instalaciones exteriores Reduce el impacto visual de la instalación gracias a su color, diseño y dimensiones.


Depósitos fabricados con polietileno de alta densidad (PEAD) alimentario, en una sola pieza, sin costuras ni soldaduras. Al PEAD utilizado en este proceso se le añade aditivo con estabilizante UV, lo que, unido a su opacidad, permite mantener las condiciones organolépticas del agua. Debido a la gran resistencia química del PEAD, el depósito EcoCompact puede utilizarse de forma segura en procesos y tratamientos industriales, tratamientos de aguas, almacenamiento de aguas de lluvia y, en general, para el almacenamiento de todo tipo de líquidos compatibles con el PEAD. El innovador diseño interno, cóncavo y sin huecos. Permite un vaciado máximo del depósito sin

Depósito discreto
La gama EcoCompact ha sido diseñada para pasar inadvertida en cualquier instalación, tanto exterior como interior, costa o montaña. El diseño del depósito le permite pasar desapercibido.
Diseño higiénico

Roth ha desarrollado un exclusivo diseño para el vaciado completo consiguiendo un sistema más higiénico.
 PEAD alimentario Depósitos idóneos para el almacenamiento de agua.
Permite el almacenamiento de agua en espacios reducidos Su altura y anchura reducidas permiten instalaciones paso por puerta.
PEAD alimentario Depósitos idóneos para el almacenamiento de agua.
Permite el almacenamiento de agua en espacios reducidos Su altura y anchura reducidas permiten instalaciones paso por puerta.
generar zonas de acumulación de sólidos o agua estancada, garantizando unas condiciones higiénicas óptimas. Por su parte, el diseño externo y su robusta estructura permiten el apilamiento en vacío, optimizando el espacio y disminuyendo los costes de transporte y almacenamiento.

Los depósitos disponen de asas para facilitar su manejo, de tres insertos para el llenado y vaciado, además de una boca roscada de 225 mm en su parte superior. Junto a esta boca, se presenta un inserto metálico de 1” para instalar accesorios de llenado. En la cara principal del depósito se incluyen dos insertos inferiores para la instalación de accesorios de conexión y vaciado (1” y ¾”).



Estructura reforzada para mayor robustez
Depósito fabricado en PEAD alimentario con tinte anti UV. Su diseño permite apilarlo reduciendo los costes de transporte. Este depósito dispone de escala exterior graduada y zonas planas para colocar accesorios. Es apto para almacenar líquidos compatibles con el PEAD y con una densidad máxima de 1,3 kg/l.



Depósitos

Anillos nervados
Constituyen una estructura más robusta y resistente.
Torre de realce
Totalmente retráctil para facilitar el transporte y el almacenamiento. En el momento del enterrado del depósito, la torre se extrae con facilidad y se instala a la altura deseada. La torre está provista de una tapa plástica de alta resistencia capaz de soportar el paso de personas.
Todos los depósitos Rothagua Enterrado Twinbloc® incorporan sistema de rebosadero DN 110 con barrera anti-roedores.




RLL 3500
Sistema de almacenamiento de agua pluvial para su posterior uso en riego de jardines, limpieza de vehículos, llenado de piscinas, etc.

Los depósitos Rothagua Twinbloc son completamente impermeables y totalmente estables tras su enterrado.
Depósitos fabricados en PEAD, ligeros, que no se oxidan ni agrietan.
• Anillos nervados que constituyen una estructura más robusta y resistente.
Los depósitos Rothagua Twinbloc® disponen de zonas planas específicas en su parte inferior para poder taladrar y colocar racores pasamuros roscados o juntas DN110 para tuberías de PVC.

Ahorro en costes de instalación: gracias a su innovador diseño con torre de realce retráctil y su forma apaisada de bajo perfil, la familia de depósitos Rothagua Twinbloc® pueden ser
instalados en áreas con alto nivel freático, ya que no se requiere una excavación profunda para su instalación.
• Los depósitos Rothagua Twinbloc® son fabricados en una sola pieza, sin uniones ni costuras, por el método de extrusión soplado, garantizando un grosor de pared homogéneo y evitando zonas débiles asociadas a depósitos fabricados por partes y unidos por medio de soldaduras, tornillos o abrazaderas.

Rothalert Alfa
Indicador de nivel inalámbrico especialmente diseñado para depósitos enterrados. Se compone de un emisor, que se coloca encima de los depósitos, un repetidor externo y un receptor para enchufar (220 V). El emisor y el repetidor están unidos por un cable de 10 m. El emisor no puede estar sumergido en agua. Adaptable a cualquier tipo de depósito de gasóleo y de agua estándar (plástico), enterrado (altura de medida hasta 3 metros). No apto para gasolina ni líquidos corrosivos. Alcance máximo de comunicación hasta 200 m. El receptor inalámbrico se puede adquirir por separado.
1540600083 353,00
Rothalert
Indicador de nivel electrónico inalámbrico. No necesita cables ni sondas para su funcionamiento. Se compone de un emisor, que se coloca encima de los depósitos, y de un receptor para enchufar (220 V). El emisor no puede estar sumergido en agua. Adaptable a cualquier tipo de depósito de gasóleo y de agua estándar (plástico), de superficie (altura de medida hasta 3 metros). No apto para gasolina ni líquidos corrosivos. Alcance máximo de comunicación hasta 200 m. El receptor inalámbrico se puede adquirir por separado.
Rothalert 1540600043 205,00
Receptor inalámbrico Rothalert (recambio) 1540600246 91,70

Cuadro eléctrico para bombeo Control de una bomba monofásica hasta 2,2 kW IP-56. Protección contra sobretensiones, sobrecarga y bajacarga. Inmune a tormentas. Dimensiones 150 x 200 x 78 mm. Peso 950 g. 1540500277 529,00


Bombas para Rothidráulico Bombas sumergibles Inox. que actúan como grupo de presión en los Sistemas Rothidráulico permitiendo suministrar agua a la instalación de forma continua y silenciosa.
Estándar Hidro Gran Volumen Hidro Caudal máx (l/h) 4.800 4.800 Altura manométrica máx. (m.c.a.) 33,1 54,1 Potencia (kW/HP) 0,45/0,6 0,75/1,0 Peso (kg) 13 16 Tubería impulsión (pulgadas) 1”1/4 1”1/4


Dimensiones (altura en mm) 513 539
Bomba Estándar Hidro para depósitos Rothidráulico KHR 500, 700 y 1100 1541100274 739,00
Bomba Gran Volumen Hidro para depósito Rothidráulico KHR 2000 1541100275 1.095,00
Regulador para mantener la presión constante en la instalación mientras exista consumo. Comanda el funcionamiento del grupo de presión en función de las necesidades de la instalación.
Presión de arranque (bar): 1,5 Presión de paro (bar): máx. de la bomba Dimensiones (mm): 180 x 180 x 155 Peso (kg): 1,4 Conexión a red hidráulica: M 1”
1540600276 138,00
Interruptor de nivel horizontal Para todos los depósitos. Abre y cierra un circuito eléctrico según el nivel de agua en el depósito. Se instala en una de las paredes del depósito. La altura de conmutación viene dada por la altura a la que se instale el interruptor. Idóneo para electroválvula, alarma o bomba. Conectar por medio de cuadro eléctrico. Tensión: 220 Vca, intensidad máxima: 0,5 A.
Interruptor de nivel vertical regulable Para todos los depósitos. Abre y cierra un circuito eléctrico según el nivel alto de agua en el depósito. Se regula la altura de conmutación por medio de la cuerda. Idóneo para ósmosis inversa y pequeños caudales. Conectar por medio de cuadro eléctrico. Tensión: 220 Vca, intensidad máxima: 6 A.
1540800024 99,50
Boya contacto eléctrico
Accesorio para comandar la marcha y el paro de un equipo electromecánico en función del nivel de llenado del depósito. Incluye 3 m de cable. Dimensiones: 81 x 131 x 41,5 mm. Material: PP. Características interruptor: 16(4)A 250 V y 10(6) A 400 V.


1540800006 51,00
1540800154 29,70
Interruptor de nivel vertical
Cuando el flotador sube o baja por el tubo guía se activan o desactivan los contactos REED instalados en el interior de dicho tubo. Se instala en tapones con rosca hembra de 2” (bocas de Ø 72 mm). Idóneo para electroválvula, alarma o bomba. Conectar por medio de un cuadro eléctrico con protección eléctrica, a diseñar e instalar por un profesional en función de cada aplicación (cuadro no incluido). Tensión: 220 Vca, intensidad máxima: 3 A. Para más información, ver instrucciones correspondientes

IN1A. Interruptor de 1 contacto (nivel máximo). Para todos los depósitos. 1540800007 338,00
IN2A. Interruptor de nivel vertical de 2 contactos conmutados. Para todos los depósitos. 1540800008 395,00
IN3A. Interruptor de nivel vertical de 3 contactos (nivel mínimo, máximo y seguridad). Para los depósitos RC 1000 Compact y RDB 1100. 1540800026 568,00

IN3B. Interruptor de nivel vertical de 3 contactos (nivel mínimo, máximo y seguridad). Para depósitos RC 750, RB 3000, RDB 2000 y RDBA 3000. 1540800027 568,00
IN3C. Interruptor de nivel vertical de 3 contactos (nivel mínimo, máximo y seguridad). Para depósitos RB 700, RC 1000 y Twinbloc® RLL 5000. 1540800028 560,00
IN3D. Interruptor de nivel vertical de 3 contactos (nivel mínimo, máximo y seguridad). Para depósitos RB 500 y Twinbloc® RLL 3500. 1540800029 560,00
Contrabrida
Contrabrida, exclusiva de Roth, de PP (Ø 115 mm) con rosca hembra de distintas medidas. Permite instalar una tubería en la base del depósito con total seguridad. Video montaje contrabrida
Contrabrida 1" 1540600086 35,90
Contrabrida 1”¼ 1540100098 35,90

Contrabrida 1”½ 1540100099 35,90
Contrabrida 2" 1540600087 35,90
Conjunto de accesorios para primer depósito. Consta de: Enlace Acodado 90º, válvula, enlace mixto, machón de unión y tramo de tubería.
Unidad Base 1" 1540800132 62,00
Unidad Base 2" 1540800200 127,50


Conjunto de accesorios para segundo depósito y siguientes. Consta de: enlace mixto en Te, válvula, machón de unión y tramo de tubería.
Unidad Fila A 1".
1540800134 71,20
Unidad Fila A 2". 1540800137 140,50
Unidad Fila B 1”. 1540800135 71,20
Unidad Fila B 2”. 1540800138 140,50
Unidad Fila C 1". 1540800136 76,50
Unidad Fila C 2". 1540800139 147,80
Unidad Fila D 1". 1540800141 76,20
Unidad Fila D 2". 1540800142 147,80
Conjunto de contrabrida con codo
Codo + contrabrida 1" 1563013204 39,80
Codo + contrabrida 2" 1540800209 66,40



Conjunto de contrabrida con Te
Te + contrabrida 1" 1563013205 47,30
Te + contrabrida 2" 1563013215 84,20
Reguladores de nivel mecánico con acople
RSA 1" con acople 1563011126 99,80
RSA 1”½ con acople 1540100085 124,60
Reguladores de nivel mecánico Cuerpo y boya de PC y ABS. Cierre instantáneo (todo o nada). En caja, premontado. Para todos los depósitos. Presión de trabajo: 0,2 - 6 bares.
RSA 1" 1540800002 44,00
RSA 1”½ 1540800003 59,70
Acople de 1" 1540800004 62,00
Acople de 1”½ 1540800005 72,00
Rebosadero DN 50
Evita inundaciones en caso de avería del sistema de llenado automático del depósito. Se instala en la pared plana vertical del depósito. 1540800013 38,80
Seta de aireación
Seta de aireación (PEAD) con rosca macho de 2” y filtro anti insectos. 1540800015 18,20
Conjunto grifo de 1”
Este conjunto incluye una contrabrida de PP (Ø 150 mm) con racor de empalme hembra de 1” y un grifo de PP de 1” con entronque. Para instalar este accesorio se debe quitar la contrabrida ciega del depósito que viene instalada desde fábrica.
Indicadores de nivel mecánicos
Indica la altura de agua disponible en el depósito (en %). Se instala en tapones con rosca hembra de 2” (bocas de Ø 72 mm). No apto para gasóleo.
Indicador de nivel mecánico A (RB 500)
1540800140 54,50
1540700047 24,80
Indicador de nivel mecánico B (RB 700 y RC 1000) 1540700048 24,80
Indicador de nivel mecánico C (RC 1000 Compact y RDB 1100) 1540700049 24,80





Indicador de nivel mecánico D (RC 750, RB 3000, RDB 2000 y RDBA 3000) 1135000165 24,80

Kit tapón
Kit tapón a perforar de dos piezas (PEAD y EPDM). Para todos los depósitos. Permite disponer de más bocas con tapones a perforar, en la parte superior del depósito, en el caso de querer instalar accesorios con rosca 2” macho. No es hermético



Tapón y junta para boca 72 mm Necesario para el montaje de accesorios. Con rosca interior hembra de 2”. Para los depósitos Rothagua Cerrado.
Tapón perforado de tres piezas y junta
1540800153 29,80
1910200026 20,70
Tapón a perforar de dos piezas y junta 1064020155 20,30
Tapón y junta para boca de 150 mm Tapón de PEAD. Válido para los depósitos RC-750, RC-1000 y RC-1000 Compact. 50003239 9,30
Tapa para boca de hombre
Tapa y fleje para boca de hombre ovalada 500 x 400 mm 1540200027 34,30
Tapa y fleje para boca de hombre circular Ø 400 mm 1540200026 31,20




Racores de depósitos
Permite instalar cualquier elemento con tubería roscada (hasta 2”) por dentro y/o fuera del depósito.

Racor depósitos 1" macho y ¾" hembra
1540800016 63,50
Racor depósitos 2" macho y 1" ½ hembra 1540800017 75,20
Racor depósitos ½" macho y hembra 1540800018 37,50
Sistema de anclaje para Rothagua Sistema de anclaje recomendado para la protección y estabilidad del depósito ante las inclemencias del tiempo. Ideales para instalaciones de depósito en tejados y superficies altas que facilitan su vaciado por gravedad. Compuesto de cincha, tensor y kit de anclaje.
1560600238 63,30

GLOBAL PLASTIC, S.A , empresa inscrita en registro mercantil de Navarra tomo 645 folio 38 hoja Nº Na-13 377
scripción 1ª- C.I.F. A-31639792 registro General Sanitario de alimentos con el número 39 03197/NA el polietileno de alta densidad utilizado en la fabricación de los depósitos


CERTIFICADO DE PRODUCTO contacto con agua de consumo humano

® cerrado cumple con la legislación vigente relativa a los materiales y
ástico destinados a entrar en contacto con productos alimenticios.
La teoría de las 3 Erres (Reducir, Reciclar y Reutilizar) nos conciencia de la importancia en la gestión de los recursos naturales. La reutilización de los recursos hídricos es una tarea imprescindible para la protección del medio ambiente. Por ello, Roth presenta una gama especializada en la reutilización de aguas grises y pluviales para dar solución en esta materia. A su vez, la proliferación e intensidad de las normativas nacionales y locales en materia de reutilización
fomentan esta conciencia y en muchos casos obligan a su puesta en práctica. En este sentido, las Certificaciones en Construcción Sostenible se han adaptado para combatir el problema de la escasez de agua fomentando la incorporación de equipos de reutilización de aguas. Esta gama incluye 4 sistemas para la reutilización de aguas:
• RothRain, sistema de reutilización de aguas pluviales
• AquaServe, sistema de reutilización de aguas grises domésticas
• EcoStep Pro, sistema de reutilización de aguas grises en grandes instalaciones
• EcoSal HP, sistema de desalación para la reutilización de aguas marinas
• EcoSal LP, sistema de potabilización de agua salobre
Rentabilidad y ecología
Consiga con estos equipos grandes ahorros en la factura del agua de la forma más ecológica ayudando al medio ambiente.
Sostenibilidad y Ecología

La reutilización de aguas es un beneficio para ti y para los que te rodean. Roth ofrece soluciones ecológicas para preservar los recursos hídricos que disponemos sin poner en riesgo las generaciones venideras.


Roth certifica la sostenibilidad
Como socio Breeam, reforzamos nuestro compromiso con la Construcción sostenible. Esta alianza promueve instalaciones energéticamente eficientes incrementando el confort, la seguridad y la salud. Nuestro compromiso con el medio ambiente y el uso eficiente de los recursos naturales nos lleva a desarrollar sistemas de reutilización de aguas que facilitan la obtención del certificado Breeam.
Tecnología novedosa y contrastada Roth aplica sistemas de micro y ultrafiltración para conseguir aguas de muy alta calidad con el fin de asegurar el éxito del tratamiento. Reutilizar agua es una práctica ecológica y segura al alcance de todos nosotros.


Año tras año vemos como las lluvias son cada vez más torrenciales y los periodos de sequía más largos. Esto hace que el acceso al agua sea cada vez más difícil.
El conjunto RothRain nos permite paliar esta situación almacenando agua pluvial en las épocas más lluviosas para su utilización posterior cuando el recurso escasea. De este modo, reducimos nuestra huella ecológica protegiendo el planeta.
El agua recuperada en el conjunto RothRain es agua de gran calidad que puede ser reutilizada en el riego de jardines, inodoros, etc.

Roth pone a su disposición este conjunto compacto y económico, de instalación sencilla, sin necesidad de grandes obras civiles y que incluye todos los accesorios para la recogida y reutilización del agua pluvial.

El conjunto se presenta con dos configuraciones y tres capacidades distintas para adaptarse a sus necesidades e incluye depósitos para instalación enterrada fabricados en PEAD mediante la técnica de extrusión soplado. Los depósitos Twinbloc soportan las cargas laterales e inferiores del empuje del agua, siendo la mejor opción en lugares
con alto nivel freático. El sistema automático de entrada de agua de red incluido en el modelo Plus, nos permite mantener en todo momento un nivel mínimo de agua en el depósito, permitiendo su utilización incluso durante los períodos de sequía más prolongados
El carácter ecológico del producto lo convierten en un aliado inmejorable a la hora de obtener su certificación de construcción sostenible Aporte valor añadido a su vivienda y combata el cambio climático con la calidad y garantía de la marca Roth.
Gracias a su contribución a la protección del medio ambiente, el conjunto RothRain le permite obtener créditos para los diferentes certificados de construcción sostenible.

El agua de lluvia acumulada en un conjunto RothRain, puede ser reutilizada en riego de jardines, lavado de coches, etc., reduciendo nuestra factura de agua potable.

El conjunto RothRain nos permite disfrutar de un agua de alta calidad de forma gratuita, conservando las reservas de agua potable y reduciendo el impacto que el ser humano tiene sobre el planeta.






Las nuevas formas de edificación permiten, además de un ahorro energético, un mejor aprovechamiento de los recursos de los que disponemos. El equipo AquaServe es la solución perfecta para ahorrar agua y reducir la huella ecológica en instalaciones con consumos moderados. AquaServe recoge las aguas grises de duchas, bañeras y lavamanos para su reutilización en descarga de inodoros, riego de jardines y lavado de vehículos. La tecnología aplicada consiste en un biorreactor con membrana (MBR) de ultrafiltración generando aguas de alta calidad cumpliendo con las exigencias legales en materia de reutilización de aguas grises. Es un equipo destinado para casas unifamiliares, bloques de viviendas, oficinas, turismo rural, pequeños hoteles, etc.

Sistema de filtración por membranas biológicas Separa los sólidos suspendidos, materia orgánica, jabones, etc., de las aguas grises domésticas consiguiendo importantes ahorros en la factura del agua. El paso de membrana del equipo AquaServe es de 20 nanómetros, lo cual otorga al equipo un rendimiento del 99,99% de eliminación de E. coli y huevos de nemátodos.

La gama AquaServe son elementos diferenciadores con alto valor social y ecológico. Ayudan a la consecución de Certificados de Construcción Sostenible. Se trata de un equipo muy fácil de instalar y conectar. Mínimo mantenimiento al estar programado de fábrica.



La alta calidad
tratamiento permite que riegue su jardín con agua regenerada con la máxima tranquilidad y confianza.

Certificados de Construcción Sostenible Obtenga la máxima puntuación con los sistemas de reutilización de aguas grises para viviendas y pequeñas comunidades de vecinos.

Sistema de ultrafiltración por membrana para la reutilización de aguas grises domésticasViviendas unifamiliares, bloques de viviendas, oficinas AquaServe reutiliza las aguas grises en instalaciones con consumos moderados como edificios de viviendas y unifamiliares. Agua de duchas y bañeras para riego e inodoros El sistema AquaServe recoge y reutiliza las aguas de duchas y bañeras haciendo de tu vivienda un lugar más sostenible y confortable. del


Combatir la escasez de agua es una lucha constante que nos obliga a agudizar nuestro ingenio. La reutilización de agua es una forma de evitar el agotamiento hídrico a la vez que promueve el crecimiento económico sostenible y solidario con el medio ambiente. La gama Roth EcoStep Pro reutiliza las aguas grises de duchas, lavamanos y sobrantes de piscinas para su posterior uso en la descarga de inodoros, riego de jardines y lavado de vehículos. Por su capacidad, estos equipos son adecuados para su instalación en hoteles, campings, edificios de oficinas, complejos deportivos, piscinas municipales, universidades y en general, instalaciones

con grandes consumos de agua potable. La planta EcoStep Pro somete al agua bruta a un tratamiento donde primeramente se le adiciona desinfectante y floculante para posteriormente tratarla mediante microfiltración. De esta forma se consiguen calidades acordes con la legislación vigente sobre reutilización de aguas grises. Todos los componentes se instalan sobre un bastidor de acero inoxidable, dándole al equipo un aspecto compacto, elegante y robusto. El grado de automatización es tal (tanto para el filtrado como para el lavado) que el mantenimiento se reduce a la adición de producto químico de las garrafas
El uso de EcoStep Pro permite ahorrar en la factura del agua. Gracias a sus bajos periodos de retorno de la inversión, supone una actividad económica en sí misma generando importantes ahorros económicos en poco tiempo. Este sistema puede aprovecharse como elemento diferenciador dando un valor añadido a la instalación. Es importante tener en cuenta que la reutilización de aguas tiene un peso importante en la consecución de Certificados de Construcción Sostenible. Desde el Departamento Técnico realizamos estudios individualizados para cada proyecto.


Grandes consumos en aguas de duchas
En grandes instalaciones el consumo de agua potable en duchas es muy alto. Esto la convierte en un recurso perfecto para su reutilización dentro de la misma instalación. Así se consiguen importantes ahorros.
La EcoStep Pro da solución a todo aquel hotel costero con obligación legal de reutilización aguas.

El ahorro en el coste del agua potable en instalaciones de grandes dimensiones hace que la inversión se amortice rápidamente.

Solución ecológica para mejorar la rentabilidad de su instalación. Reutiliza las aguas grises en instalaciones con grandes consumos

La EcoStep Pro es una solución perfecta para los campings, al tratarse de un equipo con sensibilidad medioambiental en unas instalaciones donde el respeto al medio y el confort prima sobre todas las cosas.


El sistema recoge las aguas de duchas y piscinas para su reutilización en descarga de inodoros y riego de jardines, consiguiendo plazos de amortización de hasta 2 años.


La versatilidad de tratamiento de la EcoStep Pro es muy amplia. El equipo es capaz de tratar las aguas sobrantes de piscinas, incluso rechazo de sus depuradoras, para su posterior reutilización.

La EcoStep PRO genera importantes ahorros económicos en hoteles reduciendo sus facturas de agua potable en la recarga de inodoros y riego de jardines.

Las situaciones de déficit hídrico que vivimos sobre todo en las zonas más explotadas turísti camente generan un daño irreparable tanto para el cliente como para la imagen de la propia insta lación. Contar con sistemas alternativos que nos permitan abastecernos de agua en situaciones de crisis hídricas es fundamental para el devenir de nuestro negocio. Instalaciones como hoteles, campings o conjuntos de viviendas situadas en la costa deben asegurar el suministro hídrico constante y sin interrupciones.


emplearse tratamientos de desalación con bajos consumos energéticos. El sistema consta de un conjunto de automatismos que desalan y depuran el agua del mar previamente almacenada y la envía a un depósito lista para su uso.


multitud de veces cada litro de agua que entra en la instalación.



Para dar solución a la grave situación de sequía y problemas de calidad del agua que sufrimos debido al cambio climático, Roth ha desarrollado sistemas compactos de potabilización de aguas salobres combinando tecnologías de tratamientos de agua por Ósmosis Inversa con filtración previa, remineralización, desinfección o automatización.


Partiendo de aguas salobres provenientes de pozos, embalses, etc. la gama EcoSal LP presenta equipos compactos y prefabricados desde 200 hasta 2.400 l/h para destinarla a diversos usos (industriales, turísticos, agrícolas y ganaderos e incluso directamente para consumo humano).
Debido a la versatilidad de los sistemas Roth EcoSal LP, podemos eliminar conductividad y contenido en sales del agua de red para reducir mantenimientos y consumos energéticos de las instalaciones. Ademas, el agua de red osmotizada permite ser usada en procesos que requieren de mayor calidad o pureza.

Sistema de tratamiento de Aguas Pluviales mediante desinfección por UV.

El aprovechamiento de las aguas de lluvia en una instalación es una de las medidas más ecológicas y sostenibles que podemos aplicar. El sistema EcoStep UV aplica un tratamiento de microfiltración y posteriormente una desinfección con luz UV para obtener una calidad de agua óptima para su uso en descarga de inodoros, riego de jardines, lavado de paneles fotovoltaicos, etc. sin añadir productos químicos.
Sistema automático y con control propio. Ideal para comunidades de vecinos, hoteles, campings, edificios de oficinas y toda instalación con requerimiento de Certificación de Construcción Sostenible.



remoto de sistemas de Tratamientos de Aguas Roth. Su versatilidad y simple interfaz permite controlar y monitorizar el funcionamiento de EcoStep, AquaServe, EcoSal, etc a través de smartphone, PC, etc. Facilita la monitorización del funcionamiento de varias instalaciones y equipos al mismo tiempo. Protocolos de comunicaciones: ModBus, BACnet, CAN Bus, conexión a red de datos ethernet, entre otros.

Medidor de cloro en continuo
Sistema de ajuste de cloro en continuo formado por una sonda de cloro y una bomba que mide y ajusta el nivel de cloro dentro del depósito de acumulación de aguas tratadas de forma continua. Todo el sistema, compuesto de bomba, medidor y automatismos, viene montado sobre un panel de PP.
Sistema para completar la instalación de reutilización de aguas con una poscloración. Este equipo se compone de una bomba dosificadora analógica, un contador por impulsos y un depósito dosificador. El contador se instala a la salida de la bomba de servicio comandando la bomba dosificadora para la inyección de cloro en el agua producida. Modelo para 1” y 2”.
1541400323 5.993,00
Kit cloración AquaServe 1240400180 1.297,00
Kit cloración EcoStep Pro 1240400181 1.518,00

Sistema automático entrada de agua de red
Sistema automático de entrada de agua de red al depósito de aguas pluviales o grises regeneradas para evitar su vaciado total y evitar sacrificar la instalación. Consta de una boya de nivel con 3 m de cable, caja de conexiones y electroválvula (posibilidad de ½” y 1”).


Sistema automático entrada de agua de red 1/2" 1540500263 269,00
Sistema automático entrada de agua de red 1" 1540500264 386,00
Bomba para agua pluvial
Ideal para introducir en depósitos Rothagua para agua destinada al riego de jardines, lavado de vehículos, fuentes ornamentales, etc. Bomba de presión y succión sumergible con conexión de 1”.
Caudal máx. 5.700 l/h

Altura manométrica máx. 48 m.c.a.
Potencia 1,1 kW

Peso 11 kg
Ø tubería de impulsión 1” Longitud cable 15 m.
Bomba para agua pluvial
1541100218 886,00
Bomba para agua pluvial con accesorio para aspiración 1541100219 938,00
Juntas labiadas
Juntas de EPDM. Necesarias para asegurar la estanqueidad al instalar accesorios o tuberías en depósitos Roth.
Junta labiada DN 50
1540600001 7,70
Junta labiada DN 110 1540600002 36,00
Kit de unión Rothagua Twinbloc® 1560800225 66,40
Filtro con cesta para interior del depósito Filtro para agua pluvial. Dimensionado para tejados con una superficie máxima de 250 m2. Cesta con red de 1 mm para integrar en el interior de la torre de realce y que impide la entrada de sólidos al interior del depósito. La cesta-filtro deberá ser limpiada regularmente por el usuario. Conexiones DN110.

Filtro Horizontal
Filtro para agua pluvial. Dimensionado para tejados con una superficie máxima de 150 m2. Debido a su disposición inclinada necesita poco mantenimiento. Conexiones DN110.
Filtro de Gran Volumen
Filtro para agua pluvial. Dimensionado para tejados con una superficie máxima de 350 m2. Alto rendimiento independientemente del flujo de agua. Ideal para integrar en el interior de la torre de realce del Rothagua Twinbloc®. Conexiones DN110.
1540600221 419,00
1540600223 535,00
Filtro para agua de lluvia Para tejados con una superficie máxima de 60 m2 por bajante. Se instala en la bajante. Elimina hojas y restos de suciedad del agua de lluvia, almacenando así agua más limpia. De PP, con malla de inoxidable y tubería de salida adaptable a DN 32 y DN 50.
1540600222 856,00
1540600068 155,00
Kit aspiración agua de lluvia Dispositivo para aspiración de agua pluvial en el depósito. Consta de una boya de Ø 150 mm, filtro, válvula de retención de 1”, tubo de aspiración flexible de Ø 36 mm y contrabrida de conexión al depósito con rosca hembra de 1”. Para instalar en todos los depósitos de la gama Rothagua.

Kit aspiración agua de lluvia conexión bomba 1540600099 225,00
Kit aspiración agua de lluvia con contrabrida 1540600095 247,00






Conjunto antirremolino RothRain Conjunto compuesto de accesorio antirremolino, tubería y accesorios de conexión DN110 para su instalación en depósitos RothRain. La función del accesorio antirremolino es hacer que el depósito de aguas pluviales se llene de forma suave y sin generar turbulencias al manar el agua de abajo hacia arriba. De esta forma se protege el grupo de presión de abrasiones y atascos.
El accesorio antirremolino se instala en el fondo del depósito, con posibilidad de conexión a tubos de DN 125 o DN 110 (no incluidos). Hace que la entrada de agua en el depósito sea muy suave, evitando que los sedimentos se remuevan. Fabricado en PE.
Conjunto antirremolino RothRain
1540600100 129,00
Accesorio antirremolino 1540600092 107,00
Rebosadero DN 110
Evita inundaciones en caso de sobrellenado del depósito. Su forma sifónica, que debe permanecer llena de agua, impide la entrada de insectos y de olores. Se debe conectar a un sistema de desagüe. Se instala en la pared plana vertical del depósito. La pared se taladra con una broca de corona (ver instrucciones). Tubo de PE de Ø 110 mm. Incluye junta labiada.
1540800014 99,80


Tarifa de precios 2023
Válida desde 01.02.2023

Toda actividad humana genera una serie de residuos, los cuales pueden llegar a contaminar las aguas continentales y marinas si no son sometidos a un correcto tratamiento. Por este motivo, y para evitar los graves perjuicios que producen los vertidos, es necesario y de obligado cumplimiento la instalación de equipos para tratamientos de depuración de las aguas residuales domésticas. Una necesidad que los gobiernos llevan ya
tiempo aplicando mediante la elaboración de leyes y normas a este respecto. Esto se traduce en una legislación cada vez más exigente con los requisitos medioambientales , aplicando el principio "el que contamina, paga". Roth proporciona una amplia experiencia y un servicio técnico experto en el campo de la depuración haciendo de sus equipos una solución perfecta para este tipo de vertidos. Su amplia variedad
de gama y tecnología permiten al usuario final tener una infinidad de soluciones sea cual sea la instalación. En las siguientes páginas, Roth muestra sistemas de depuración certificados con el marcado CE según las diversas normas de fabricación europeas (EN 1825, EN 12566-1, EN 12566-3, etc.).

Compromiso con el medio ambiente
El vertido de aguas residuales debe ser inocuo para el medio que lo recibe. La protección del entorno en el que vivimos debe ser una prioridad absoluta para todos.

Un equipo para cada necesidad Cualquier tipo de instalación encuentra en ROTH su equipo idóneo para el tratamiento de las aguas residuales que genera.
Roth apuesta por las tecnologías más novedosas Los equipos ROTH permiten al usuario disponer de la más alta tecnología en pro de conseguir las mayores eficiencias de depuración.
La gama de productos Roth es muy amplia abordando desde soluciones domésticas hasta instalaciones industriales como EESS, lavaderos de vehículos, parkings, etc.

 Rothagras Rothafos Rothepur BioStep MicroStar T MicroStar Rothidro
Evitar riesgos potenciales en la salud La depuración de aguas residuales es fundamental para prevenir enfermedades y cuidar de los que nos rodean. No debemos comprometer las generaciones venideras.
Rothagras Rothafos Rothepur BioStep MicroStar T MicroStar Rothidro
Evitar riesgos potenciales en la salud La depuración de aguas residuales es fundamental para prevenir enfermedades y cuidar de los que nos rodean. No debemos comprometer las generaciones venideras.
Los sistemas de alcantarillado y depuradoras municipales ven su capacidad y eficiencia mermadas por los excesos de aceites y grasas que vertemos. Los separadores de grasa Rothagras realizan el pretratamiento necesario antes de verter las aguas a la red de saneamiento. Retienen jabones y flotantes, restos de comida, aceites y grasas de origen animal y vegetal, tanto de cocinas como de duchas y lavabos. Equipos fabricados en Polietileno de alta densidad por el método de extrusión soplado en una sola pieza, sin costuras ni soldaduras. Esto les confiere le capacidad de ser totalmente estancos además de una gran robustez lo que permite su instalación tanto enterrado como en superficie
Sistema compacto y de gran eficacia diseñado para la eliminación de aceites y grasas en grandes comedores.
Enterrables sin apenas obra civil Los separadores de grasa Rothagras pueden instalarse enterrados sin necesidad de grandes obras civiles, simplemente excavar, conectar y enterrar.

El funcionamiento del equipo se basa en la diferencia de densidades entre el agua y el aceite. Dentro del Rothagras los sólidos decantan mientras que los aceites flotan quedando como sobrenadante. De esta forma, el agua sale pretratada y libre de estos contaminantes.

La legislación obliga al tratamiento de aguas residuales de cocinas, bares y restaurantes con alto contenido en aceites y grasas.



Rothagras Bio Pack
Producto biológico
los aceites acumulados en el separador minimizando el mantenimiento.


Separador de grasas para el tratamiento de aguas residuales de cocinasque degrada




Depuración de Aguas Residuales


Roth presenta la solución adecuada para el vertido de viviendas aisladas o sin red de saneamiento. El equipo de depuración Bio le permite tratar las aguas de origen doméstico de forma fácil y sencilla antes de verterlas mediante una zanja de filtración. De esta forma, podemos evitar situaciones de insalubridad y deterioro del medio ambiente. La Rothepur Bio es un equipo compacto y autónomo (sin consumo de energía) con decantador primario y filtro biológico
anaeróbico integrado. Su instalación es muy sencilla al no precisar de grandes obras civiles, basta con excavar la zanja y enterrar. Fabricado en Polietileno de Alta densidad por el método extrusión soplado en una sola pieza sin costuras ni soldaduras, lo que le confiere una gran resistencia a golpes y esfuerzos. La Rothepur BIO ofrece un rendimiento teórico en eliminación de M.E.S. del 80 % y de DBO5 del 50 %.
Depuración de aguas residuales domésticas Equipo para el tratamiento de las aguas residuales generadas en una vivienda para ser devueltas a la naturaleza mediante zanjas de infiltración o sistema de depuración natural.

Preservación del medio ambiente El tratamiento de aguas residuales domésticas es fundamental para la preservación de la naturaleza.

Tratamiento biológico anaerobio En una primera etapa los lodos y los aceites se separan por diferencia de densidades. A continuación, en una segunda etapa, el agua pasa a través de un prefiltro biológico donde crecen colonias bacterianas que producen la degradación anaerobia de los contaminantes, consiguiendo altos rendimientos de depuración sin consumo de energía.
 Zonas rurales Diseñado para gestionar efluentes en instalaciones del mundo rural sin poner en riesgo el medio ambiente.
Zonas rurales Diseñado para gestionar efluentes en instalaciones del mundo rural sin poner en riesgo el medio ambiente.
del prefiltro



Los vertidos a dominio público hidráulico cauce público o zonas sensibles deben adecuarse al medio receptor y, por tanto, debemos ser más exigentes con su tratamiento. Además, la legislación es muy restrictiva y tajante en estos casos exigiendo efluentes de alta calidad. La planta de tratamiento MicroStar es un sistema de tratamiento de aguas residuales domésticas de alto rendimiento de depuración mediante la tecnología SSB® (tratamiento aeróbico estabilizador secuencial). Esta técnica ofrece una alta tasa de

eliminación de nitrógeno con baja generación de lodos minimizando el mantenimiento de la planta. Los resultados de los ensayos de eficiencia de depuración están muy por encima de los mínimos exigidos para cualquier punto de vertido (con eficiencias del 99%) ofreciendo una gran protección al medio ambiente y tranquilidad al usuario final. Equipos fabricados en PEAD, de fácil instalación pudiendo ser tanto aérea como enterrada.




El equipo incluye producto biológico en base de bacterias liofilizadas especialmente seleccionadas. Activa y ayuda en la puesta en marcha de la planta y reduce de forma drástica la formación de lodos.



Tecnología avanzada SSB®
Proceso secuencial de estabilización de lodos activados. El tratamiento consta de cuatro etapas: fase de decantación (desnitrificación), aireación –oxidación, clarificación y fase de bombeo (donde se expulsa el agua ya tratada y depurada).

Rendimiento acreditado en laboratorio Eficiencia de depuración certificada por laboratorio acreditado.
Vertido a Dominio Público Hidráulico
La alta calidad del vertido permite su vertido a cualquier punto del Dominio Público Hidráulico.
Planta de tratamiento de alto rendimiento de aguas residuales urbanas
Opciones del sistema
La modularidad del conjunto ofrece una gran versatilidad para su instalación. Se adapta a cualquier espacio disponible pudiendo instalarse en serie, en batería, etc.



Todo incluido
El equipo incluye autómata, soplante, difusores, mangueras y accesorios de conexión.
Resultado de ensayos realizados por laboratorio externo Tabla comparativa de los valores de eficiencia de depuración exigidos para vertido a DPH según RD 606/2003 y directiva 91/271/CEE con los resultados obtenidos por la MicroStar en laboratorio acreditado.

Roth ha desarrollado la nueva gama MicroStar Twinbloc como apuesta por la alta tecnología. Esta nueva gama de plantas de tratamiento de alto rendimiento permite el vertido de las aguas residuales domésticas de grandes colectividades a Dominio Público Hidráulico o zonas sensibles. Roth combina alta tecnología en depuración, tecnología SSB®, con el modelo Twinbloc de depósitos de máxima calidad:
depósitos robustos y de alta resistencia incluso en zonas de nivel freático alto. Los depósitos son apilables en vacío y la instalación precisa poca obra civil gracias a su baja altura, lo que permite un gran ahorro en costes de instalación. Esta gama permite tratar mayores caudales de vertido con unas eficiencias máximas de depuración gracias a la tecnología de tratamiento SSB®, de mayor rendimiento que la oxidación
total convencional y con menor generación de lodos, lo que permite disminuir los costes de mantenimiento. El equipo se envía premontado de fábrica para facilitar su instalación. Incluye todos los elementos necesarios para su instalación y puesta en marcha: depósitos, difusores, autómata programado, tubería, soplantes y producto biológico.
Instalación rápida y sencilla
El material se suministra premontado de fábrica para optimizar su instalación. El diseño del depósito facilita su almacenamiento y transporte.
Tecnología avanzada SSB®
Proceso secuencial de estabilización de lodos activados. El tratamiento consta de cuatro etapas: fase de decantación (desnitrificación), aireación –oxidación, clarificación y fase de bombeo (donde se expulsa el agua ya tratada y depurada).




Vertido cumpliendo las máximas exigencias legales El efluente de la MicroStar Twinbloc es de tal calidad que cumple con los máximos legales de depuración permitiendo su vertido a Dominio Público Hidráulico. Además, su alta eficiencia en eliminación de nitrógeno hace que sea una solución perfecta para su uso en zonas medioambientalmente sensibles.

Planta de tratamiento de aguas residuales domésticas de alto rendimiento para grandes colectividades




La protección del medio ambiente es uno de los grandes retos a los que nos enfrentamos como sociedad. Por un lado, la sobreexplotación de recursos, como el agua, hacen que cada vez tengamos menos cantidad del recurso disponible. Este problema se agrava cuando devolvemos al medio, tras su uso, el agua en mal estado. Para paliar esta problemática, Roth pone a su disposición el equipo MicroStep Compact. Un equipo compacto y ecológico, que nos permite devolver con total

garantía el agua al medio ambiente, cumpliendo con las exigencias legales más exigentes. El sistema MicroStep Compact incluye todos los elementos necesarios para una instalación estándar (depuradora, cuadro de control, realce, mangueras, etc).

Los costes totales de cualquier proyecto deben ser bien estudiados y para rentabilizar las instalaciones es preciso tener todos ellos en cuenta (transporte, instalación, manipulación,
mantenimiento, etc.). Por todo ello, Roth ofrece esta solución doméstica, solución con formato compacto y de bajo consumo energético, para conseguir una de las plantas de alto tratamiento más eficientes del mercado, ya que ahorra costes de transporte, instalación y manipulación, a la vez que ofrece altos rendimientos sin apenas costes de operación.

Compacto

Planta de tratamiento de alto rendimiento compacta y ecológica
Sequencing Batch Reactor o Tratamiento secuencial que proporciona magní cos rendimientos de depuración incluso en momentos de alta sobrecarga hidráulica.
Tratamiento de aireación prolongada de fancos activos con recirculación de lodos. Es una de las tecnologías más extendidas para tratar aguas residuales urbanas mediante tratamientos biológicos. El crecimiento de biomasa formando óculos en el biorreactor ofrece rendimientos estables altos con bajos costes. Estos procesos incluyen una etapa de Desnitri cación para completar el tratamiento de depuración.

Moving Bed Bio lm Reactor, el relleno biológico móvil ubicado en el interior del equipo, incrementa la capacidad de tratamiento aumentando los tratamientos de depuración. Además, se consigue reducir el tamaño del equipo para obtener altos rendimientos.
El movimiento de relleno biológico se produce durante los procesos de aireación forzada y oxigenación del licor de mezcla. De esta forma se consiguen crecimientos óptimos de microorganismos adaptados al e uente a tratar en forma de película.
La planta de tratamiento de alto rendimiento MicroStep Compact combina tecnologías de aireación prolongada de fangos activos y desnitri cación, SBR y MBBR.


Eficiencias de rendimiento de depuración La tecnología utilizada en la MicroStep es el tratamiento de oxidación total con recirculación de fangos activados. Es el tratamiento clásico de oxidación total de alto rendimiento con eficiencias de depuración muy por encima de lo exigido en la normativa. La tabla muestra las eficiencias de depuración del equipo testado en laboratorio acreditado e independiente (rendimiento conseguido sin la adición de producto biológico).









Rothidro DUO Estándar Depuración industrial. Clase I NOVEDAD


Los separadores de hidrocarburos Rothidro DUO depuran las aguas contaminadas con aceites minerales e hidrocarburos y las aguas provenientes de limpiezas. Para estaciones de servicio, parkings, talleres...
SHR DUO 30 3 1.550 430 1.530 1.000 1,220 160 1220600457 2.419,00
Rothidro DUO con By-pass Depuración industrial. Clase I

Los separadores de hidrocarburos Rothidro DUO depuran las aguas contaminadas con aceites minerales e hidrocarburos y las aguas provenientes de limpiezas y escorrentías. El equipo incorpora un by-pass para que las aguas torrenciales no entren en la cámara de acumulación de hidrocarburos, ya que son aguas que no precisan de tratamiento. Para parkings, lavaderos de vehículos...

Separadores de grasa compactos para instalación bajo encimeras, fabricados en acero inoxidable. Incluyen cesta extraíble para recoger los restos sólidos que contengan las aguas.

Los depósitos de acumulación están destinados a almacenar todo tipo de aguas compatibles con el PEAD. No precisan de costosas obras civiles para su instalación. Depósitos totalmente estancos y muy resistentes a golpes y sustancias químicas. Se recomienda la instalación de un sistema indicador de nivel de llenado, p.e. Rothalert.

Conjunto autónomo de depuración biológica aeróbica de aguas residuales domésticas Consta de una decantación primaria y un filtro percolador. Productos biológicos incluidos para la puesta en marcha. Rendimientos teóricos de eliminación de M.E.S del 90% y de DBO5 del 76% Producto biológico incluido.


Liofilizado de enzimas. Producto biológico a base de algas, bacterias y enzimas de tipo celulasas y peptidasas. Reduce de forma drástica la formación de lodos y natas en fosas sépticas (Rothafos y Rothepur Bio) y separadores de grasa (Rothagras). Presentación en botes de 0,5 kg.


Dosificación: 1 bote por cada 1.000 l de aguas residuales cada 6 meses. Dosificar en decantador primario o desde inodoro.
Bac
Liofilizado de bacterias. Producto biológico a base de bacterias liofilizadas especialmente seleccionadas para depuraciones aeróbicas de aguas residuales (MicroStar, MicroStep y BioStep). Presentación en botes de 0,5 kg.
Dosificación: 1 bote por cada 1.000 l de aguas residuales cada 6 meses. Dosificar en digestor aeróbico durante la etapa de aireación.
Acti Clar
Apoyo al desarrollo bacteriano. Producto biológico a base de granulado de algas de mar y de bacterias para favorecer procesos de clarificación en depuración biológica (MicroStar y MicroStep). Presentación en botes de 0,5 kg.
Dosificación: 1 bote por cada 1.000 l de aguas residuales cada 6 meses. Dosificar en digestor aeróbico durante la etapa de aireación.
Start Pack
Conjunto compuesto de Likefian EVO, Bac Plus EVO y Acti-Clar, para la activación y puesta en marcha de estaciones de tratamiento de aguas residuales con tratamiento biológico aeróbico (MicroStar y MicroStep).
1135001917 71,70
1135001918 71,70
1135001916 71,70
1235000350 207,00
Rothagras Bio Pack
Biodegradador líquido para mantenimiento de separadores de grasas. Fórmula líquida basada en microorganismos para desatascos, eliminación de grasas y tratamientos de malos olores en las canalizaciones de cocinas, sifones, fregaderos y separadores de grasas. Presentación en botellas de 1 litro o garrafas de 25 litros.
Rothagras Bio Pack 1 l




1240300206 83,00
Rothagras Bio Pack 25 l 1240300230 1.397,00

Rothidro Bio Pack

Tratamiento totalmente biológico en forma de cómoda almohadilla absorbente diseñada para ser colocada en el interior de los separadores de hidrocarburos Rothidro, evitando la acumulación de hidrocarburos y eliminando sus posteriores gastos de gestión. Las almohadillas degradan de forma acelerada los aceites e hidrocarburos presentes en el agua. Las bacterias metabolizan los aceites e hidrocarburos a través de procesos biológicos produciendo CO2 y agua, de manera que los residuos dejan de ser tratados como residuos industriales especiales. En un período de cuatro meses transformará más de 30 Kg de aceites en CO2 y agua.
1240300204 553,00
Conjunto fotovoltaico Conjunto fotovoltaico para suministro de energía eléctrica a las plantas de tratamiento convirtiendo su equipo en autónomo y libre de consumo de la red eléctrica. Incluye módulos solares, regulador y baterías.
Conjunto fotovoltaico 58 W 1240100181 Consultar

Conjunto fotovoltaico 115 W 1240100182 Consultar
Armarios cuadro eléctrico MicroStar Armarios de protección para el cuadro de control de MicroStar. Modelo Dimensiones
Armario pared MicroStar 4-20 415 x 615 x 230 mm.
Armario intemperie MicroStar 6-20 400 x 1.275 x 320 mm.
Armario intemperie MicroStar 25-38 400 x 1.275 x 250 mm.
Armario intemperie MicroStar 45 820 x 1.743 x 320 mm.
Armario intemperie MicroStar 4 1240800410 781,00
Armario pared MicroStar 4-20 1240800333 663,00
Armario intemperie MicroStar 6-20 1240800332 783,00

Armario intemperie MicroStar 25-38 1240800334 1.117,00
Armario intemperie MicroStar 45 1240800335 3.091,00
Soplante eléctrico para insuflar aire.
Presión máx. Caudal aire Modelo de trabajo (mbar) (l/min/mbar) Equipo Roth JDK 50 250 80/150 MicroStep D - E XP 80 250 80/150 MicroStar 4-6-8 AP 120 250 125/200 MicroStar 10 HP 150 300 150/200 MicroStar 15-25-30 HP 200 300 200/200 MicroStar 20-38-45
Soplante JDK 50
1240200303 361,00
Soplante XP 80 1240800313 670,00
Soplante AP 120 1240800312 1.158,00
Soplante HP 150 1240200368 2.198,00

Soplante HP 200 1240200369 2.529,00
Alarma para Rothidro y Rothagras
Para separador de hidrocarburos Rothidro y separador de grasas Rothagras. Sistema automático que avisa del nivel predeterminado de hidrocarburos o grasas acumulados por medio de un indicador luminoso y sonoro. Según norma EN 858 el separador de hidrocarburos debe incorporar un sistema de aviso automático que determine el nivel máximo de hidrocarburo acumulado. Distancia máxima al equipo: 15m.
Contador de aguas residuales
Contador DN 100 Caudal máximo 250 m3/h
Presión máxima de trabajo 16 bar
Peso 16 kg
Longitud 250 mm Conexión mediante bridas según norma PN-ISO-7005 PN 1,6 MPa.



1240400120 1.068,00
1240400252 743,00
Sistema modular para zanjas filtrantes. El sistema Hidrobox conforma una geoestructura plástica de alta resistencia que permite ejecutar elementos de captación pluvial, acumulación, drenaje y evacuación de aguas residuales y transporte subterráneo de forma modular y sencilla. Su modularidad ofrece gran flexibilidad durante el diseño del proyecto ya que permite la instalación de cualquier configuración dependiendo del área disponible. Soporta tránsito rodado. 728 x 445 x 495 mm.
Seta de desodorización
Accesorio que permite la ventilación de las instalaciones a la vez que absorbe los malos olores provenientes de fosas sépticas, cañerías, depósitos de combustible, etc. Incluye cartucho de filtro intercambiable. Con protección UV para instalación a la intemperie. DN 70/90/100.
1240100253 92,00
Seta de desodorización 1240100251 205,00 Cartucho de filtro (recambio) 1240100261 82,40
Medidor altura de lodos
Dispositivo de control de altura de lodo de planta de tratamiento. Para visualizar el nivel de lodos y gestionar el mantenimiento de la depuradora. Altura máxima: 2 m. Ø = 1”.
1240400334 221,00
Difusor tubular 950





Conjunto aireación para todo tipo de digestores de aireación prolongada. Diseño para facilitar el mantenimiento e instalación. Incluye difusor de microburbuja y base hormigonada.
Sifón DN 110
Sifón con registro macho-hembra DN110 con junta labiada. Accesorio que precede a todo sistema de depuración evitando el retorno de malos olores al interior de la vivienda o instalación.
Relleno biológico
Material que sirve de soporte a las colonias de microorganismos involucrados en los procesos de depuración biológica. Permite la oxigenación y biodegradación de los contaminantes orgánicos contenidos en el agua. Suministrado en sacos de 4,2 kg.
1240800311 219,00
1240100208 107,00
Tapa y fleje boca de hombre ovalada de PEAD
Válida para: FR-1000, FR-1500, FR-2000, FR-3000, FR-Bio-1000, FRBio-1500, FR-Bio-2000, FR-Bio-3000, RG-1000, RG-1500 y depósitos de los conjuntos MicroStep. Dimensiones: 500 x 400 mm. Incluye fleje.
1210000010 109,00
1540200027 32,70
Torre de realce ovalada Sistema de realce para acceder al interior de equipos de depuración que disponen de boca de hombre ovalada 400x500 mm. Cuando el equipo queda totalmente enterrado, el realce permite el acceso al interior para realizar trabajos de mantenimiento e inspección. Instalación machihembrada para agilizar su montaje. Además, la torre de realce puede usarse como arqueta. Dimensiones: Ø 325 x altura 950 mm

Torre de realce con tapa transitable Realce para acceder a través de la boca de hombre al interior del deposito y facilitar así los trabajos de mantenimiento e inspección. Instalación machihembrada. Incluye tapa transitable hasta 200 kg. Dimensiones Ø 690 x 585 mm.
1240100455 221,00
Torre de realce con tapa transitable 1240100314 559,00 Prolongación Boca de Hombre 1135000340 249,50
Tapas Torre de realce transitable Tapa de polietileno de alta densidad para hacer transitable la torre de realce. Dos modelos en función de la resistencia al peso.
Tapa transitable peatonal PN 200 1240100315 119,80 Tapa transitable tránsito rodado PN600 1240100179 257,00
Torres de realce
Se instala mediante tornillos de acero inoxidable o roscándola DN255 (según modelo). Permite: Alargar la arqueta RPA 500 y conseguir una altura máx. de 1.130 mm.
• Acceder desde la superficie al primer compartimento y/o al prefiltro de las fosas sépticas rectangulares (Rothafos, Rothepur BIO, Rotharena, etc.)
Dimensiones Ø 325 x 630 mm.
Torre de realce 1240100011 117,40
Tapa de torre de realce 1240100012 22,00
Torre de realce EVO 325 para Rothepur BIO 1000, 1500 y 2000 1240100276 205,00


Tapa roscada para torre de realce EVO 325 1240400200 22,80

Arqueta de desbaste RPA 200 litros
Arqueta de pretratamiento con reja de desbaste para la eliminación de gruesos (papel, plástico, etc.) antes de entrar al sistema de depuración. DN ent./sal. 160 mm.
Dimensiones Ø 790 x 625 mm.

Arqueta RPA 500
Arqueta tomamuestras. Viene ciega de fábrica, se taladran los agujeros de entrada y salida(s) según necesidad. Se puede usar como arqueta de registro y tomamuestra a la salida de la fosa (1 entrada y 1 salida) o como arqueta de repartición para el sistema de Depuración Natural (1 entrada y 2 ó 3 salidas). DN ent./sal. 110 mm.
Modelo
Dimensiones
Arqueta RPA 500 Ø 325 x 500 mm.

Arqueta RPA 650 Ø 325 x 650 mm.
1540100231 1.337,00
Arqueta RPA 500 1240100010 173,00
Arqueta RPA 650 1240100174 199,40
MARCADO CE (REGLAMENTO 305/2011)
Ensayos tipo realizados por: MFPA número D-PL-11143-01-00
FABRICANTE DEL PRODUCTO: ROTH UMWELTTECHNIK ROTH IBÉRICA S.A. POL. IND. MONTES DE CIERZO A-68 – KM. 86 E-31500 TUDELA (NAVARRA) ESPAÑA
Marcado CE fijado en el año 2010
DECLARACIÓN DE PRESTACIONES NÚMERO: DP-DIV III-002 Norma: EN 12566-3
DECLARA BAJO SU RESPONSABILIDAD QUE EL PRODUCTO: MICROSTEP APLICACIONES: PLANTA DE TRATAMIENTO PARA PEQUEÑAS INSTALACIONES DE DEPURACIÓN
MARCADO CE (REGLAMENTO 305/2011)
Ensayos tipo realizados por: Aimplas número 1842 FABRICANTE DEL PRODUCTO: ROTH IBERICA, S.A. (nueva denominación social de Global Plastic, S.A.) POL. IND. MONTES DE CIERZO A-68 KM. 86 E-31500 TUDELAESPAÑA(NAVARRA)
Marcado CE fijado en el año 2010
DECLARACIÓN DE PRESTACIONES NÚMERO: DP-DIV III-001 Sistema de evaluación y verificación de la constancia de las prestaciones: Sistema 3. Norma: EN 12566-1/A1 DECLARA BAJO SU RESPONSABILIDAD QUE EL PRODUCTO: ROTHAFOS Y ROTHEPUR USO PREVISTO FOSA SÉPTICA PARA PEQUEÑAS INSTALACIONES DE DEPURACIÓN DE AGUAS RESIDUALES PARA POBLACIÓN DE HASTA 50 HABITANTES EQUIVALENTES CONDICIONES ESPECÍFICAS: SEGÚN RECOMENDACIONES DESCRITAS EN LA ETIQUETA DEL PRODUCTO Y EN SUS INSTRUCCIONES. Tabla de las características esenciales exigidas en la norma EN 12566-1/A1 y que deben de cumplir los productos: Estanquidad a líquidos Conforme Ensayo realizado por AIMPLAS
Eficacia hidráulica 0,8754 g de bolas Comportamiento Estructural Conforme Durabilidad Conforme Thomas Reis (Gerente de la empresa Roth Ibérica) Número de revisión: 12 C.G-07 Página 8

DECLARACIÓN DE CONFORMIDAD A LA NORMA UNE EN 1825 parte 1 y 2 FABRICANTE DEL PRODUCTO: ROTH IBÉRICA, S.A. (nueva denominación social de Global Plastic, S.A.) DIRECCIÓN: POL. IND. MONTES DE CIERZO A-68 KM. 86 E-31500 TUDELAESPAÑA(NAVARRA) DECLARA BAJO SU RESPONSABILIDAD QUE EL PRODUCTO: ROTHAGRAS CUMPLE LOS REQUISITOS DE LA NORMA: UNE EN 1825 parte 1 y 2
APLICACIONES: SEPARADORES DE GRASAS Y ACEITES DE ORIGEN VEGETAL Y ANIMAL DE TAMAÑO NOMINAL MAYOR DE 1, DE AGUAS RESIDUALES DOMÉSTICAS PARA PROTEGER LOS SISTEMAS DE ALCANTARILLADO Y AGUAS

En Roth llevamos más de 70 años innovando por un futuro sostenible.


Tarifa de precios 2023
Válida desde 01.02.2023

La civilización actual no puede entenderse sin el papel fundamental que el gasóleo ha jugado en su desarrollo.
A día de hoy, este combustible continúa teniendo un papel clave en el funcionamiento de la sociedad. El gasóleo es esencial en sectores como la agricultura, la ganadería, el transporte, la generación de energía, etc. Así mismo, es la alternativa más económica y limpia para la calefacción de segundas residencias y lugares con déficit de infraestructuras.
Este combustible aporta seguridad, permitiendo un normal funcionamiento ante cortes de energía eléctrica en instalaciones clave como hospi-
tales, industria, centros comerciales, recintos deportivos, etc. Además, con el desarrollo de los nuevos combustibles ecológicos (e-diésel, biocombustibles, carbon-neutral fuel, etc.) se obtienen altos rendimientos energéticos respetando el medio ambiente.
Para contribuir al desarrollo sostenible con la máxima seguridad, Roth pone a su disposición su gama de depósitos de gasóleo. Esta amplia gama incluye tres modelos, Roth Duo System, Rothalen Plus y Rothalen. Los depósitos internos de los modelos Roth Duo System y Rothalen Plus, así como el depósito Rothalen, están fabricados en polietileno de alta densidad (PEAD) por el
sistema de extrusión soplado, sin costuras ni soldaduras y de una sola pieza.
El PEAD utilizado es un material inocuo y totalmente reciclable al final de su vida útil. Además, gracias a las características de este material, los depósitos son ligeros, lo que facilita su manipulación.
Al ser depósitos modulares, se adaptan al espacio disponible en su instalación. De este modo, la amplia gama de modelos, volúmenes y dimensiones permite encontrar un depósito Roth para cada instalación
Todos los depósitos están adaptados para cumplir con la legislación vigente y disponen del marcado CE. Roth pone a su servicio asesoramiento técnico profesional.
Todos nuestros depósitos están fabricados en nuestra planta de Navarra. El PEAD utilizado para su fabricación es un material de larga vida útil y fácil reciclaje al nal de la misma.
El carácter modular de los depósitos facilita su adaptación al espacio disponible en su instalación.
Depósitos de fácil manipulación y transporte diseñados para optimizar el espacio. Los modelos con contención secundaria disminuyen los costes de instalación al no precisar cubeto de obra.
Depósitos fabricados de una sola pieza sin costuras ni soldaduras, para asegurar una perfecta estanqueidad. Modelos con la más alta clasi cación de reacción al fuego (A1) según UNE-EN 13501-1.
Aportando seguridad a la sociedad Gracias al gasóleo aseguramos que infraestructuras esenciales como los hospitales funcionen con normalidad ante un corte de suministro eléctrico, aportando seguridad en nuestros momentos de mayor necesidad.

Disfrutar del ocio
Desde la infancia, los momentos de ocio son fundamentales para desarrollarnos como personas. El gasóleo nos permite disfrutar con normalidad de estos momentos en centros comerciales, instalaciones deportivas, etc., permitiendo su funcionamiento de forma ininterrumpida ante cualquier eventualidad en el suministro eléctrico.

Seguridad alimentaria
Gracias a la utilización de este combustible, podemos asegurar una producción estable y suficiente de alimentos que garantice el bienestar en nuestra sociedad. Además, con el desarrollo de los nuevos combustibles ecológicos (e-diésel, biocombustibles, carbonneutral fuel, etc.) se obtienen altos rendimientos energéticos respetando el medio ambiente.

Transporte de mercancías

La gran mayoría de los productos que consumimos en nuestro día a día llega a nuestras casas gracias al gasóleo. Este combustible nos facilita disponer de ropa en las tiendas, alimentos en el supermercado, medicamentos en las farmacias, etc.


Calefacción en el hogar
El gasóleo es sin duda una alternativa económica y limpia para la calefacción de segundas viviendas y lugares sin infraestructura.

Para acumular gasóleo previo a su consumo en cualquier tipo de instalaciones, Roth pone a su disposición el depósito Roth Duo System, el cual se compone de un depósito interno fabricado por el sistema de extrusión soplado en polietileno de alta densidad (PEAD) y un envolvente fabricado en chapa de acero galvanizado que ejerce de cubeto y refuerzo.
Este envolvente es ignífugo. Tiene la más alta clasificación en reacción al fuego, A1 según UNE EN 13501-1 (Euroclases) , aportando la máxima seguridad al usuario.
Además, nuestro exclusivo ensamblaje sin soldaduras, la altísima calidad de los materiales
empleados y el soporte metálico que evita el contacto con el suelo, hacen del Roth Duo System el depósito con mayor resistencia a la corrosión del mercado
Estas características lo convierten en la mejor opción para acumular gasóleos y biocombustibles, ya que la contención secundaria en acero galvanizado asegura la máxima protección frente a la luz UV manteniendo la calidad del biocombustible almacenado con el paso del tiempo. Un depósito robusto y estanco con la experiencia, calidad y garantía de la marca Roth.
Este depósito se presenta en cuatro modelos con capacidades entre 400 y 1.500 litros. Es-

tas capacidades pueden aumentarse uniendo hasta cinco depósitos en batería mediante los accesorios de unión FüllStar o Gran Caudal de Roth. Esta versatilidad, nos permite adaptarnos a cualquier instalación, sin importar los consumos o el espacio disponible.
Así mismo, el diseño de los depósitos y accesorios nos proporciona una instalación rápida y sencilla, lo que unido al envolvente metálico, que evita la construcción de un cubeto de obra, hacen que los costes de instalación disminuyan drásticamente.

El gasóleo es la alternativa más limpia y económica para la calefacción de segundas residencias y lugares aislados. Tal y como nuestra dilatada experiencia confirma, estos sistemas son sencillos, seguros, cómodos y fiables.

El gasóleo asegura que una instalación pueda funcionar con normalidad en casos de interrupción del suministro eléctrico.
La agricultura es un sector clave para el desarrollo de la sociedad. El uso del gasóleo nos permite producir alimentos en cantidad suficiente para satisfacer nuestra demanda.

Depósito ignífugo y estanco para gasóleo con contención secundaria en acero galvanizado
Sistema exclusivo de fabricación con la mejor materia prima

La altísima calidad de la chapa de acero galvanizado utilizada y el exclusivo sistema de fabricación Roth con juntas moleteadas, sin soldaduras, aseguran una perfecta estanqueidad del envolvente metálico y la más alta resistencia a la corrosión del mercado.


Accesorios para la instalación Füll-Star Roth le proporciona los accesorios para unir hasta cinco depósitos en batería e incrementar la capacidad de almacenamiento de su instalación.


Depósito de gasóleo con contención secundaria en polietileno de alta densidad. Apto para instalación a la intemperie

Para instalaciones exteriores o en ambientes agresivos y corrosivos, como son las cercanas al mar, industria con productos químicos, etc. Roth pone a su disposición el depósito Rothalen Plus, depósito con cubeto incorporado, ambos fabricados en polietileno de alta densidad (PEAD) por el procedimiento de extrusión soplado.
En este proceso de fabricación, Roth emplea el novedoso PEAD PLUS, lo que permite a estos depósitos soportar las inclemencias meteoroló-

Ambientes agresivos y corrosivos

El uso del novedoso PEAD PLUS convierten al modelo Rothalen Plus en la mejor elección para acumular gasóleo en ambientes agresivos y corrosivos, tales como instalaciones cercanas al mar e industria con productos químicos.

gicas e instalarse a la intemperie y le dota de una excelente resistencia a la corrosión. Un depósito robusto y estanco con la experiencia y la garantía de la marca Roth.
Este depósito se presenta en cuatro modelos con capacidades entre 700 y 2.000 litros. Estas capacidades pueden aumentarse uniendo hasta cinco depósitos en batería mediante los accesorios de unión FüllStar o Gran Caudal de Roth. Esta versatilidad, nos permite adaptarnos a

cualquier instalación, sin importar los consumos o el espacio disponible. Además, el diseño de los depósitos y accesorios nos proporciona una instalación rápida y sencilla, que unido al cubeto de contención secundaria, que evita la construcción de un cubeto de obra, disminuyen drásticamente los costes de instalación.
Disoluciones de urea Depósitos de PEAD compatibles con el almacenamiento de disoluciones de urea que reducen las emisiones al medio ambiente.
Alternativa limpia y económica El gasóleo es la alternativa más limpia y económica para la calefacción de segundas residencias y lugares aislados.



Depósitos para Gasóleo
Para contribuir al desarrollo sostenible, Roth pone a su disposición el depósito para almacenamiento de gasóleo Rothalen. Estos depósitos están fabricados en polietileno de alta densidad por el procedimiento de extrusión soplado. Mediante este sistema, el depósito se fabrica en una sola pieza, sin costuras ni soldaduras, logrando un producto robusto y estanco
Para garantizar estas cualidades, el producto está sometido a los más rigurosos controles de calidad, avalados por prestigiosas entidades como el TÜV alemán, AIMPLAS y el Laboratoire National d´Essais francés. Además, todos los depósitos cuentan con el Marcado CE bajo la norma europea EN 13341, de acuerdo al reglamento de productos de la construcción 305/2011. Un depósito con la calidad y garantía de la marca Roth.
El modelo Rothalen se presenta como la gama de depósitos más amplia del mercado. Capacidad desde 500 hasta 2.000 litros y con gran variedad de modelos y dimensiones, incluyendo depósitos estrechos para paso por puerta, lo que siempre permite encontrar la solución que mejor se adapte a su instalación.

Fácil instalación y manipulación
La gran variedad de modelos permite encontrar un depósito para cada instalación. De este modo disminuimos tiempos y costes de instalación.

Todos los accesorios Roth se enroscan en las bocas de los depósitos, simplificando el proceso. Además, el tamaño ligero y las asas facilitan la manipulación de los depósitos en obra.
Segundas residencias y lugares aislados


El gasóleo es la alternativa más limpia y económica para la calefacción de segundas residencias y lugares aislados. Tal y como nuestra dilatada experiencia confirma, estos sistemas son sencillos, seguros, cómodos y fiables.
La gama más amplia del mercado Roth pone a su disposición la gama de depósitos más amplia del mercado, incluyendo depósitos de ancho especial para paso por puerta, permitiendo instalar los depósitos en obras ya finalizadas.

Depósito para gasóleo fabricado en polietileno de alta densidad. Amplia gama de modelos y dimensiones



Espuma interior de poliuretano de alta calidad
Plataforma de chapa de acero galvanizada
Indispensables para toda buena instalación Bases antivibraciones para calderas, grupos electrógenos, compresores, acumuladores solares (ACS), maquinaria de obra, grupos de aire acondicionado...

Instalación CON base Rothapac Absorbe los efectos molestos (ruido, vibraciones, etc.).


Las bases Rothapac están compuestas por una plataforma de chapa de acero galvanizado en la cual se inyecta una espuma de poliuretano. Fabricada con materiales imputrescibles, la base ofrece garantías en cuanto a su durabilidad y su capacidad para soportar cargas pesadas. La estructura molecular del poliuretano aporta a la
base Rothapac una estabilidad y un aislamiento acústico máximo, proporcionando un producto de aplicaciones múltiples para calderas, grupos electrógenos, compresores, grupos de aire acondicionado, motores, etc. Mayores ventajas:
• Resistencia puntual de carga de aproximada 75 kg/cm2
Instalación SIN base Rothapac Los ruidos, calor y vibraciones se propagan por el suelo.
Resistencia al calor hasta 110 ºC.
• Reducción del nivel de ruido en 15 dB (A).
• Protege la caldera de la humedad del suelo y de inundaciones.
Sustituye la bancada de obra.
• Fácil colocación.

Rothalert Alfa
Indicador de nivel inalámbrico especialmente diseñado para depósitos enterrados. Se compone de un emisor, que se coloca encima de los depósitos, un repetidor externo y un receptor para enchufar (220 V). El emisor y el repetidor están unidos por un cable de 10 m. El emisor no puede estar sumergido en agua. Adaptable a cualquier tipo de depósito de gasóleo y de agua estándar (plástico), enterrado (altura de medida hasta 3 metros). No apto para gasolina ni líquidos corrosivos. Alcance máximo de comunicación hasta 200 m. El receptor inalámbrico se puede adquirir por separado.
Rothalert
Indicador de nivel electrónico inalámbrico. No necesita cables ni sondas para su funcionamiento. Se compone de un emisor, que se coloca encima de los depósitos, y de un receptor para enchufar (220 V). El emisor no puede estar sumergido en agua. Adaptable a cualquier tipo de depósito de gasóleo y de agua estándar (plástico), de superficie (altura de medida hasta 3 metros). No apto para gasolina ni líquidos corrosivos. Alcance máximo de comunicación hasta 200 m. El receptor inalámbrico se puede adquirir por separado.
1540600083 353,00
Rothalert 1540600043 205,00 Receptor inalámbrico Rothalert (recambio) 1540600246 91,70

Interruptor de nivel vertical Cuando el flotador sube o baja por el tubo guía se activan o desactivan los contactos REED instalados en el interior de dicho tubo. Se instala en tapones con rosca hembra de 2” (bocas de Ø 72 mm). Idóneo para electroválvula, alarma o bomba. Conectar por medio de un cuadro eléctrico con protección eléctrica, a diseñar e instalar por un profesional en función de cada aplicación (cuadro no incluido). Tensión: 220 Vca, intensidad máxima: 3 A. Para más información, ver instrucciones correspondientes.



IN1A: 1 contacto (nivel máximo). Para todos los depósitos. 1540800007 338,00
IN2A: Interruptor de nivel vertical de 2 contactos conmutados. Para todos los depósitos. 1540800008 395,00
IN3A: 3 contactos (nivel máximo y dos conmutados). Para depósitos Duo System 1500, Rothalen Plus 1000 y 1500, Rothalen 1500, 2500 y Rothalen 1000 Estrecho y 1000 Compact. 1540800026 568,00
IN3B: 3 contactos (nivel máximo y dos conmutados). Para depósitos Rothalen 700 Compact, 2000 y Rothalen Plus 2000. 1540800027 568,00
IN3C: 3 contactos (nivel máximo y dos conmutados). Para depósitos Duo System 620 y 1000, Rothalen 700 Estrecho, Rothalen 1000 y Rothalen Plus 700. 1540800028 560,00
IN3D: 3 contactos (nivel máximo y dos conmutados). Para el depósito Duo System 400 y Rothalen 500 Estrecho. 1540800029 560,00
Unidad Base Füll-Star
Consta de sistema de llenado, kit de aspiración de gasóleo y Sistema de aireación. Para todos los modelos Rothalen, Rothalen Plus y Duo System. Accesorios destinados a la conexión de baterías de depósitos instalados sin bandejas.

1920100001 125,30
Unidad Fila Füll-Star
Consta de sistema de llenado, sistema de aspiración de gasóleo, y sistema de aireación. Accesorios destinados a la conexión de baterías de depósitos instalados sin bandejas. Video
Unidad Fila FS-700 Füll-Star 1920200001 93,80

Unidad Fila FS-700 XXL Füll-Star 1920200006 92,70
Unidad Fila FS-780 Füll-Star 1920200002 94,90
Unidad Fila FS-840 Füll-Star 1920200003 103,70
Unidad Fila FS-920 Füll-Star 1920200004 219,30
Kit A Gran Caudal
Consta de sistema de llenado, kit metálico de aspiración de gasóleo y Sistema de aireación. Para todos los modelos Rothalen, Rothalen Plus y Duo System. Adecuar longitud de manguera a la altura del depósito (ver instrucciones). Idóneo para suministro de gasóleo a grupos electrógenos y equipos de trasvase de gasóleo.
Kit B Gran Caudal
Consta de sistema de llenado, kit metálico de aspiración de gasóleo y Sistema de aireación. Para todos los modelos Rothalen, Rothalen Plus y Duo System. Adecuar longitud de manguera a la altura del depósito (ver instrucciones). Idóneo para suministro de gasóleo a grupos electrógenos y equipos de trasvase de gasóleo.
Kit C, D y E Gran Caudal
Consta de sistema de llenado, sistema de aspiración de gasóleo, y sistema de aireación. Idóneo para suministro de gasóleo a grupos electrógenos y equipos de trasvase de gasóleo.
1920400047 358,00
1920400048 474,70
Video montaje
Kit C Gran Caudal 1920400049 435,00



Kit D Gran Caudal 1920400050 453,00
Kit E Gran Caudal 1920400051 416,00
Combinación de los accesorios según gama
depósito
depósito y siguientes
Kit de aspiración de gasóleo Consta de sistema de aspiración de gasóleo con bridas-conexión, tubo flexible y válvula de cierre manual. Para caudales inferiores a 55 l/h. Conexión con tubería 8, 10 o 12 mm.


Kit Aspiración gasóleo. Válido para todos los depósitos Roth, salvo Rothalen 1000 Estrecho, Rothalen 1000 Compact y Rothalen Plus 1000. 1063012001 42,20
Kit XXL Aspiración gasóleo. Válido para los depósitos Rothalen 1000 Estrecho, Rothalen 1000 Compact y Rothalen Plus 1000. 1063012003 44,80
Kit Aspiración plástico negro 1920400021 38,90


Kit aspiración translúcido. Válido para todos los depósitos Roth 1910100077 43,40
Conjunto T de aspiración Consta de T de aspiración, tuercas plásticas negras, juntas tóricas de goma y tubo metálico de unión. Para caudales inferiores a 55 l/h.
Conjunto T 680 de aspiración para depósitos Rothalen 500 y 700 1920200030 47,20
Conjunto T 760 de aspiración para depósitos Duo System 400 y 620, Rothalen 700 Compact, 1000, 1500 y 2000 Estándar y Rothalen Plus 700. 1920200031 47,70
Conjunto T 820 de aspiración para depósitos Duo System 1000 T y 1500, Rothalen 1000 Compact y Rothalen Plus 1000 y 1500. 1920200032 48,30
Conjunto T 900 de aspiración para depósito Rothalen Plus 2000. 1920200033 48,90
Indicadores de nivel mecánicos
Indicador de nivel DS 400 8020200035 25,60
Indicador de nivel DS 620 y RT 1000 Estándar 1920500019 25,60
Indicador de nivel RT+ 500 y RT 500 Estrecho 2150500001 25,60
Indicador de nivel RT+ 700/RT 700 Estrecho 2150500002 25,60
Indicador de nivel RT+ 1000/RT 1000 Estrecho y Compact 2150500003 25,60
Indicador de nivel DS 1000T 8020200006 25,60
Indicador de nivel DS/RT/RT+ 1500 1920500020 25,60
Indicador de nivel RT+ 2000/RT 2000/RT 750 Compact 2150500008 25,60

Seta de aireación
Seta de aireación (PEAD) con rosca macho de 2” y filtro anti insectos. Permite equilibrar la presión interior del depósito con la exterior en las operaciones de llenado y de vaciado, evitando deformaciones y ruptura del depósito. Se instala en tapones con rosca hembra de 2” (bocas de 72 mm).
Seta de aireación de 2"
1517010050 11,90
Seta de aireación de 2" con filtro anti insectos 1540800015 18,20
Filtro con retorno integrado gasóleo
Filtro para gasóleo con retorno integrado equipado con caperuza transparente. Conexiones para las mangueras de succión y retorno G 3/8 rosca macho con sección cónica interior. Conexión a depósito de G 3/8 rosca hembra. Caudal de retorno máximo 120 l/h.
Filtro con retorno integrado gasóleo
1910100030 79,60 Recambio de filtros (paquete con 5 unidades) 1910100037 20,80
Boca de carga tipo CAMPSA 2” y codo rosca macho 2” Boca para conectar la manguera del camión suministrador de gasóleo a los depósitos Roth y permitir el llenado automático.
1063028456 162,00

Cubierta de protección frente a la intemperie Con anclajes para cierre de seguridad y adaptador para conexión hidráulica con equipo de trasvase de gasoil. Altura 300 mm.
Cubierta para Duo System 400 y 620 1910100073 264,00
Cubierta para Duo System 1000 T 1910100075 249,00



Cubierta para Duo System 1500 1910100076 277,00
Sistema de anclaje Duo System, Rothalen y Rothalen Plus Cinchas de anclaje para depósitos Roth Duo System, Rothalen Plus y Rothalen recomendadas para garantizar la estabilidad del depósito ante las inclemencias meteorológicas.
Sistema de anclaje Rothalen y Rothalen Plus 1560600238 63,30
Conjunto cincha de anclaje para Duo System 1920700001 186,60
Modelo
Bandeja PE Rothalen 700 Compact
Dimensiones (mm) Volumen (l)
1.035 x 1.035 x 237 75
Bandeja PE Rothalen 500 y 700 Estrecho 1.325 x 925 x 255 73
Bandeja PE Rothalen 1000 Estándar y 1000 Estrecho 1.960 x 940 x 290 124
Bandeja PE Rothalen 700 Compact 1064020700 121,90



Bandeja PE Rothalen 500 y 700 Estrecho 1064020500 124,80
Bandeja PE Rothalen 1000 Estándar y 1000 Estrecho 1064021000 149,90
Tubo antiespumante 1064020030 8,80
Dispositivo avisador de llenado 1920500033 18,70
Tubo detector de fugas
Para Duo System 400 y Rothalen Plus 700 1150009226 23,80
Para Duo System 620 y Rothalen Plus 2000 1150010591 25,00
Para Duo System 1000 T y Rothalen Plus 1500 1135007461 32,80
Para Duo System 1500 y Rothalen Plus 1000 1150010628 32,80
Tapón y junta para boca 72 mm Necesario para el montaje de accesorios. Con rosca interior hembra de 2”. Para todos los depósitos.
Tapón perforado de tres piezas y junta 1910200026 20,70



En Roth llevamos más de 70 años innovando por un futuro sostenible.


Tarifa de precios 2023
Válida desde 01.02.2023

La optimización de costes en el transporte y manipulación de sustancias es un reto diario a nivel mundial. Roth presenta una serie de soluciones para la gestión de residuos industriales y combustibles que permiten optimizar su logística.
El almacenaje y transporte de combustibles mercancías peligrosas o residuos son desafíos presentes en cualquier actividad industrial. Debemos gestionarlo de la mejor manera posible y evitar así riesgos para la salud y el medio ambiente.
A lo largo de esta sección, encontrará soluciones para el transporte por tierra, mar y aire de sustancias peligrosas líquidas y sólidas, suministro y transporte de combustibles, etc. cumpliendo con todas las exigencias internacionales vigentes.
Combustibles tipo C y D, gasóleos y alquitranes.
Aceites hidráulicos y lubricantes, anticongelantes, productos de la industria fotográ ca, residuos de aceites.
bombillas, pilas y baterías, cenizas y taladrinas, virutas de cristal, plástico y latón, latas y envases contaminados materiales absorbentes después de su uso, trapos contaminados de talleres, etc.
Residuos de ganadería y pesca, material sanitario y de farmacia.
Sábanas y toallas de hoteles, hospitales y residencias. Ropa de trabajo de fábricas y talleres.
Agua potable, vino, aceite vegetal, etc.
Sustancias líquidas para uso en agricultura, ganaderia y pesca.
Tecnología en depósitos para el transporte de sustancias peligrosas
La apuesta de Roth por las más novedosas tecnologías en diseño y fabricación de depósitos para la gestión y transporte de sustancias peligrosas, se muestra en sus gamas de depósitos con contención secundaria estanca, ignífuga y sin soldaduras.

Soluciones industriales


La gestión y transporte de residuos y combustibles industriales encuentra solución en la gama de productos Roth.
Compromiso con la seguridad Los equipos Roth destinados a la acumulación y transporte de sustancias peligrosas cumplen con todas las exigencias vigentes a nivel internacional. Están certificados para el transporte de sustancias peligrosas líquidas y sólidas por tierra, mar y aire. Además, cumplen con lo dispuesto en la instrucción técnica complementaria ITC MIE-APQ 7 para “Almacenamiento de productos tóxicos”.

Cubeto de retención ignífugo y estanco. Clase A1 según norma EN 13501-1
La gama RothStation ofrece la solución completa para todas aquellas instalaciones que precisan suministrar gasóleo de forma autónoma Cuenta con un equipo de trasvase a 230 V, con una capacidad de suministro de 45 l/min y pistola automática, premontado sobre un armario de protección. El conjunto es apto para instalación a la intemperie utilizando el accesorio opcional “cubierta de protección frente a la intemperie”


(ver sección accesorios). Se incluyen así mismo todos los accesorios necesarios para su utilización (kit de aspiración, manguera de 5 metros, soportes, seta de aireación, etc.). Es la solución idónea para clientes con flota de vehículos propia (camiones, taxis, cooperativas agrícolas, constructoras de obra civil, etc.). El equipo es apto para la gestión de aceites industriales hasta 500 cSt.



Dentro de esta gama, Roth pone a su disposición el modelo RothStation Portable MT. Este modelo incluye un depósito Multitech Plus con certificación ADR para el transporte por carretera de sustancias peligrosas líquidas, lo que permite acercar el combustible de forma segura, cómoda y sencilla a zonas alejadas donde se encuentre operando la maquinaria.

Para completar la gama RothStation, Roth le ofrece el modelo RothStation In/Outdoor RP. Gracias al exclusivo PEAD + utilizado en la fabricación del depósito Rothalen Plus, este conjunto está especialmente diseñado para todas aquellas instalaciones de suministro a vehículos que precisan una resistencia adicional para poder emplazarse a la intemperie, ofreciendo una excelente resistencia a las inclemencias meteorológicas y a la corrosión.
El conjunto incluye, además del depósito Rothalen Plus, un equipo de trasvase a 230 V con pistola automática, contador y filtro integrados (capacidad de suministro 45 l/min) premontado sobre un armario de protección. Se incluyen así mismo todos los accesorios para su correcto funcionamiento (manguera de 5 metros, soporte específico para cada modelo, sistema de aspiración, etc.). Un sistema compacto y seguro para abastecimiento de vehículos








Depósito con contención secundaria ignífugo y estanco para el transporte de sustancias peligrosas líquidas
Los equipos Multitech están especialmente diseñados para el almacenamiento y transporte de sustancias peligrosas líquidas. Son depósitos de PEAD con contención secundaria de acero galvanizado, materiales con alta resistencia química y mecánica, para proteger de golpes y roces durante el transporte. La protección secundaria o cubeto está fabricada en acero galvanizado con protección anticorrosión. Asegura una estanqueidad del 100 % en el caso de una posible fuga del depósito interior además de aportar una mayor resistencia mecánica al sistema.




Están certificados para el transporte por carretera (European Agreement concerning the International Carriage of Dangerous Goods by Road - ADR), ferrocarril (Regulations concerning the International Transport of Dangerous Goods by Rail - RID), mar (International Maritime Dangerous Goods Code - IMDG) y aire (Interntational Civil Aviation Organization - ICAO) a nivel internacional. Debido a la alta calidad en su fabricación, el Multitech Plus cumple con lo dispuesto en la instrucción técnica complemen-
taria ITC MIE-APQ 7 para “Almacenamiento de productos tóxicos”.
El depósito cuenta con altas propiedades ignífugas, dándole una protección extra a su contenido. Además, el pallet que incluye el depósito, dispone de sistema antigolpes, protegiendo al depósito de golpes y roces en el transporte, a la vez que lo aísla del suelo y favorece su manipulación. Todos los depósitos incluyen indicador de nivel interno y detector de fugas
Depósitos estancos e ignífugos
La contención secundaria de acero galvanizado, estanca y sin soldaduras, permite conservar su estructura original tras un incendio. Esta característica ofrece una gran seguridad en la acumulación y transporte de sustancias peligrosas líquidas.

Alta compatibilidad química ante sustancias contaminantes
Alta resistencia química debido a su depósito interno fabricado con PEAD por el método de extrusión soplado, de una sola pieza, sin costuras ni soldaduras.
Residuos líquidos
de residuos líquidos para su posterior gestión, cumpliendo con las exigencias legales.






El Service Box es un equipo diseñado para el almacenamiento y transporte de estas sustancias peligrosas sólidas, fabricado en PEAD, dispone de dos ruedas y cierre de seguridad. Cuenta con los certificados pertinentes para el transporte de estos residuos por carretera, ferrocarril, mar y aire (ADR, RID, IMGD, ICAO). Supone una solución cómoda y segura para multitud de aplicaciones: almacenamiento de residuo sanitario, pilas, latas, envases contaminados, trapos manchados con aceites y taladrinas, virutas de plástico o latón, etc.
Formato para gestionar residuos hospitalarios de forma inocua. La facilidad de manipulación del Service Box mediante sus ruedas incorporadas, su tapa con cierre de seguridad que permite incluso almacenar residuos a la intemperie sin riesgo de que entre agua o insectos y su capacidad de apilado hacen del Service Box la solución ideal para transporte por pasillos, ascensores, etc. de forma estanca y segura.
Útil para almacenar trapos manchados con aceites y grasas

Almacenamiento y transporte de trapos con aceite, residuo generado en talleres y desguaces, concesionarios, lavaderos, etc. Las dimensiones compactas y sencillez de manipulación, hacen del Service Box un equipo muy versátil.
Puedes guardar las pilas y baterías al final de su vida útil de forma totalmente segura Almacenar y transportar pilas en desuso de forma adecuada. Su capacidad de contaminación es muy alta y sus efectos perduran en el medio ambiente durante generaciones.

Solución ágil para gestionar los residuos de talleres y desguaces de vehículos
Su diseño compacto con ruedas y su tapa con cierre de seguridad hacen del Service Box una solución ágil y segura para acumular todos aquellos residuos sólidos generados, tales como: filtros, piezas manchadas de lubricantes y combustibles, trozos de cristal, gomas, etc.


Útil para almacenar residuos hospitalarios, sanitarios, hoteleros Idóneo para gestionar los residuos de desinfección, limpieza, mantenimiento... Válido también para toallas, sábanas, EPI’s usados (mascarillas, guantes, batas, etc.)


Capacidad de apilado para ocupar menos espacio de almacenamiento y transporte

Su estructura hace que se puedan almacenar y transportar apilados rebajando costes. Además, optimiza la capacidad del pallet facilitando su manejo.



(European Agreement concerning the International Carriage of Dangerous Goods by Road) para el grupo de embalaje II, clasificación A III. RID (Regulations concerning the International Transport of Dangerous Goods by Rail).


IMDG (International Maritime Dangerous Goods Code). ICAO (International Civil Aviation Organization), incluido en los IATA (International Air Transportation Agency).

Cierre de seguridad y tapa estanca Incorpora tapa estanca con junta de PU resistente al fuego y cierre metálico de seguridad para un cierre perfecto y protección incluso a la intemperie.
Póngale color y personalice su Service Box Posibilidad de personalizar el producto con diferentes gamas de colores, use el logo y características singulares del branding de su empresa en el Service Box.
Dispone de ruedas integradas y asa para facilitar su manipulación
El Service Box dispone de dos ruedas integradas y un asa superior para facilitar su manejo incluso cuando está lleno.

Transportable mediante sistema “pinza”
El Service Box dispone de zonas de sujeción laterales para usar las púas de la carretilla u otro sistema de sujeción “pinza”, facilitando su manipulación tanto en el proceso de almacenaje como de transporte.

El equipo RothStation Portable ofrece una solución versátil para el suministro móvil de gasóleo. De esta manera permite ahorrar costes y tiempo en el repostaje de vehículos que se encuentran lejos de estaciones de servicio o centros de suministro. El conjunto RothStation Portable de 460 litros de capacidad, está fabricado en polietileno de alta densidad (PEAD)

con filtro UV, por lo que puede instalarse a la intemperie. Es idóneo para su uso en agricultura, construcción, obras civiles, etc. El depósito cuenta con homologación ADR para el transporte de combustibles por carretera.


Gracias a su diseño ligero y compacto, es fácil de manejar, práctico y cómodo. Su estructura permite transportarlo con carretilla y sujetarlo
tanto con cinchas al moverlo como con enganches para grúa, asegurando su sujeción y manejo. Apilable hasta tres alturas para ahorrar en costes de transporte y almacenamiento. Además del depósito, el conjunto incluye un grupo de trasvase eléctrico 12 V y pistola automática
Contador digital para boquerel (opcional) Complete su instalación con un cuenta litros digital diseñado para medir fluidos de baja viscosidad.
Rango de caudal 5-120 l/min, presión máxima 10 bar. Dimensiones: L=100 mm, A=75 mm, H=54 mm.
El surtidor incluye de serie un grupo de trasvase eléctrico (DC), una pistola automática con manguera de presión de 4 metros de longitud y 19 mm diámetro, un cable de 4 metros con pinzas de cocodrilo, un interruptor marcha/paro, una boca de llenado de 150 mm y una seta de ventilación.

Tapa de protección uso intemperie
Tapa compacta, abatible, con sistema para instalar cierre de seguridad y así proteger su instalación. Esta tapa permite el uso del equipo a la intemperie, protegiendo el sistema de suministro de gasóleo tanto de agentes climatológicos como de daños.

El RothStation Portable dispone homologación ADR por lo que cumple con los máximos estándares de seguridad para el transporte de gasóleo.
Aumente su autonomía en obra, reduzca costes

El equipo permite transportar gasóleo hasta el lugar donde se encuentra su vehículo y aumentar así su capacidad de trabajo. Reduce de este modo los costes de producción y aumenta su competitividad.



RothStation Portable 125 AdBlue Depósito para transporte de AdBlue


Sistema de suministro de AdBlue compuesto por depósito con cubeto incorporado, ambos fabricados en PEAD, equipo de trasvase para AdBlue y conjunto de accesorios para su completa instalación. El depósito Rothalen Plus se fabrica mediante PEAD

PLUS, lo que permite a estos depósitos instalarse a la intemperie
El equipo de trasvase para AdBlue incluye pistola automática con 4 metros de manguera ¾”, bomba de 230 V - 330 W, IP55 y caudal 35 l/min.


Sistema de depósito móvil para AUS32/ AdBlue®. Especialmente adaptado para el transporte de líquidos. Solución muy práctica para la recarga de vehículos con sistemas de catalizadores SCR en la propia obra, campo, etc.
No es necesaria la Certificación de ADR puesto que el AUS32 no está clasificado como producto peligroso. Componentes:
• Depósito en PEAD de 125 l con rebajes y asas para facilitar la sujeción durante el transporte.
Boquerel de suministro automático.
Soporte de boquerel integrado.
• Bomba eléctrica autocebante 12 V, con capacidad aproximada de 30 l/min y cable de conexión de 4 m de longitud. Boca de llenado DN 100 con tapón de rosca.


• Válvula de ventilación integrada.
• Interruptor de marcha/paro. Manguera de suministro de 4 m.
• Posibilidad de bomba tanto de 12 V como de 24 V.
• Cubierta abatible opcional.
Los depósitos Unitech han sido diseñados para el almacenamiento de aceites y otros líquidos contaminantes en las propias instalaciones donde se han generado. De este modo, se facilita el almacenamiento de los residuos y la gestión medioambiental interna. Este depósito cumple lo dispuesto en la instrucción técnica complementaria ITC MIE-APQ 7 para "Almacenamiento de productos tóxicos". Los depósitos Unitech incluyen en su interior un depósito de polietilieno de alta densidad (PEAD) fabricado por tecnología de extrusión soplado, en una sola pieza y sin soldaduras. La protección secundaria o cubeto, está fabricada en acero galvanizado y protección anticorrosión. Asegura una estanqueidad del 100% en el caso de una posible fuga del depósito interior además de aportar una mayor resistencia mecánica al sistema.
Un valor añadido de este producto es, sin duda, la reacción al fuego del material del cubeto del retención, la mejor clasificación de reacción al fuego, A1 según norma EN 13501-1. Esta clasificación ofrece un factor diferenciador en relación a otros productos que se encuentran actualmente en el mercado. Sustancias a almacenar: productos de la industria fotográfica usados o nuevos hasta una densidad máxima de 1,20 g/cm3, residuos de aceites correspondientes a los códigos 13 01, 13 02, 13 03, 13 05, 13 08 de la Lista Europea de Residuos (LER), aceites de lubricación y aceites hidráulicos, aceites nuevos o usados con punto de inflamación > 55 ºC, aceites vegetales en todas las concentraciones, anticongelantes, combustibles del grupo C (gasóleos), etc.
Modelo Capacidad (l) Longitud (mm) Anchura (mm) Altura (mm) Referencia PVP €/ud
Unitech 400 Plus 400 750 700 1.130 8030100013 669,90

Unitech 750 Plus 750 995 760 1.410 8020100021 785,40
Unitech 1000 Plus 1.000 1.290 760 1.410 8020100015 988,90
Unitech 1500 Plus 1.500 1.660 760 1.870 8030100016 1.443,20
*La altura no incluye indicador de nivel.
Depósito monobloque diseñado con forma horizontal para almacenamiento y transporte de líquidos (productos alimentarios, químicos*, ácidos, etc.). Moldeado de una sola pieza, sin pegamento ni soldadura, por lo tanto perfectamente estanco. Excelente resistencia a los choques, gran robustez de las cubas. Superficie
interior lisa que evita la incrustación de sedimentos y facilita su limpieza. Pared traslúcida que permite ver el nivel de contenido. Fabricado en PEAD alimentario y con tinte anti UV. Cumple con la normas vigentes en cuanto al almacenamiento y acumulación de productos alimentarios. Condiciones del producto contenido: temperatura
hasta 60 ºC, densidad < 1,3 kg/litro. El modelo de 5.000 litros incorpora un refuerzo tubular de acero atornillado a un soporte de madera. Incluye tapa superior roscada, llave de paso de 2" en la parte inferior y seta de ventilación *Para productos químicos, consultar con nuestro Departamento Técnico.

Equipo trasvase portable
• Pistola automática
• 4 metros de manguera 1” 4 metros de cable con pinzas de cocodrilo
• Interruptor marcha paro
• Bomba de 12 V (máx. 20 A), caudal 30 l/min (dimensiones: 160 mm longitud, Ø 56 mm), sumergible hasta 1,50 m


Equipo Trasvase Portable para gasóleo 8010020007 534,00

Equipo Trasvase Portable para AdBlue 8010020006 563,00
Contador digital
Cuenta litros digital diseñado para medir fluidos de baja viscosidad (Gasóleo, Agua, etc.) y AdBlue. Dimensiones: L=100 mm, A=75 mm, H=54 mm.
Contador digital para boquerel
8050100071 344,00
Contador digital para AdBlue 8010020005 368,00
Embudo plástico universal
Embudo para facilitar el llenado de depósitos de las gamas Unitech y Multitech. Gracias a su diseño facilita el escurrido de los envases trasvasados. Permite el control del trasvase sin rebosar. Medidas ø 560 x 280 mm

Bomba de trasvase manual
Bomba de caña manual para aceites hasta SAE 50, lubricantes, anticongelante sin diluir, combustible de calefacción, diésel. Capacidad 0,12 l por pulso (12 l/min).


Longitud del tubo de aspiración: 1.200 mm. Instalación mediante rosca G 2”.
8040100144 561,00
Equipo de trasvase AdBlue
Equipo de trasvase para AdBlue. Incluye pistola automática con 4 metros de manguera de suministro y bomba de 230 V – 330 W. Caudal de suministro 35 l/min. IP 55.
1863010070 112,00
8010203128 878,00
Cubierta de protección frente a la intemperie
Con anclajes para cierre de seguridad y adaptador para conexión hidráulica con equipo de trasvase de gasoil.
Cubierta protección para Unitech / Multitech 400 Plus 1910100073 264,00
Cubierta protección para Unitech / Multitech 750 Plus 1910100074 281,00
Cubierta protección para Unitech / Multitech 1000 Plus 1910100075 249,00
Cubierta protección para Unitech / Multitech 1500 Plus 1910100076 277,00
Equipo de trasvase de gasóleo con armario de protección Armario de protección metálico con sistema de cierre “bajo llave”. Incluye soporte para manguera, sistema de anclaje y equipo de trasvase de 230 V (posibilidad de 12 V consulte al departamento técnico). Características del equipo de trasvase: bomba autocebante volumétrica de paletas. Caudal 45 l/min. Contador volumétrico mecánico. Cartucho filtrante para agua y adaptador con indicador de taponamiento. Pistola automática con cierre de gatillo. Manguera de aspiración de depósito nodriza 1”. Manguera de 5 m con acoples engarzados para suministro. Conexión MM 1”-3/4”. Medidas: 700 x 500 x 300 mm.


Equipo de trasvase de gasóleo con contador 1920700046 884,00 Equipo de trasvase gasoil con armario 8092000004 1.148,00
Soporte armario de trasvase
Para adaptar el armario de protección con equipo de trasvase a los depósitos Rothalen Plus.
Soporte armario de trasvase RP 700, 1000, 1500 8092000002 52,40
Soporte armario de trasvase RP 2000 8092000003 49,50
Filtro de equipo de trasvase de gasoil Recambio para filtro de equipo de trasvase de gasoil. 1930500056 63,90
Contador para equipo de trasvase de gasoil
Permite medir el volumen de gasoil con precisión de litros. Conexiones de 1”. Caudal de funcionamiento 20-120 l/min 1863011355 196,00



Resistente a la intemperie. Capacidad pistola: 3.600 l/h. Pistola con sistema de paro automático y gatillo autosuministro. Manguera de 5 metros y diámetro de 20 mm especial gasóleo.

Pistola paro automático 1930200025 162,00 Manguera EVO de 5 m para RothStation M-M 1"-3/4" 1930100060 98,00
Bomba para suministro de gasóleo Grupo de presión para suministro de gasóleo a grupos electrógenos y sistemas de calefacción comunitarios. Caudal máx (l/min) 105 Altura máx. (m.c.a.) 15

DNA 1”1/4
DNI 1”
Peso (kg) 9,6 Potencia (kW) 1,18
1920700066 546,00
Abrazadera soporte HKV 1150008802 65
Accesorio antirremolino 1540600092 118
Accesorio de recirculación de ACS 1135007439 41
Acople de 1" 1540800004 103
Acople de 1”½ 1540800005 103
Acti Clar 1135001916 138
Actuador 230 V, 1 W sin corriente cerrado 1135007412 75, 77, 80, 84
Actuador 24 V, 1 W sin corriente cerrado 1135007413 84
Actuador Roth 230V 1W NC fin carrera NA 4310227046 75
Acumulador WWS-200 6030100335 42
Acumulador WWS-300 6030100336 42
Acumulador WWS-500 6030100337 42
Adaptador para actuador 1 W M28 x 1’5 VA16 Rojo 4310108468 84
Adaptador para actuador 1 W M28 x 1’5 VA64 Gris 4310102815 84
Adaptador para actuador 1 W M30 x 1’5 VA80 Blanco 1135007498 84
Adaptador para actuador 1 W M30 x 1’5 VA90 Rojo 1135007497 75, 84
AdBlue Station RP 1000 8010103005 174
AdBlue Station RP 1500 8010103006 174
AdBlue Station RP 700 8010103004 174
Aditivo 20 litros para termosifón RTS 200 6070200200 21
Aditivo 25 litros para termosifón RTS 300 6070200300 21
Aditivo anticongelante GLR20 6020100344 70
Aditivo caloportante azul para captadores planos 10 l 6020100006 19
Aditivo caloportante azul para captadores planos 210 l 6020100343 19
Aditivo caloportante azul para captadores planos 25 l 6020200002 19
Aditivo para el mortero AD 10 4013010061 70
Aditivo para limpieza 2000550006 70
Aditivo para mortero AD 25 Plus 4013010062 70
Aditivo protector/anticorrosivo 2000550002 70
Aerotermo 32 kW 6020700292 17
Aerotermo 8 kW 6020700291 17
Alarma para Rothidro y Rothagras 1240400120 139
Ánodo D 32 x 350 6030200342 43
Ánodo D 32 x 520 6030200343 43
AquaServe 1000 1221200326 111
AquaServe 2000 1221200327 111
AquaServe 400 1221200325 111
AquaServe 4000 1221200328 111
Equipo de trasvase gasoil con armario 8092000004 177
Armario intemperie MicroStar 25-38 1240800334 137
Armario intemperie MicroStar 4 1240800410 137
Armario intemperie MicroStar 45 1240800335 139
Armario intemperie MicroStar 6-20 1240800332 139
Armario pared MicroStar 4-20 1240800333 139
Arqueta de desbaste RPA 200 litros 1540100231 141
Arqueta RPA 500 1240100010 141
Arqueta RPA 650 1240100174 141
Bac Plus Evo 1135001918 138
Bandeja PE Rothalen 1000 Estándar y 1000 Estrecho 1064021000 159
Bandeja PE Rothalen 500 y 700 Estrecho 1064020500 159
Bandeja PE Rothalen 700 Compact 1064020700 159
Barrera antihumedad 1135000263 63
Base soporte galvanizado para HKV/HKV-CL 1150008801 65
Bastidor de aluminio 1 Rothpool® 1115010528 26
Bastidor de aluminio 2 Rothpool® 1115010527 26
Batería Rothagua 12000 1580100236 93
BioStep F4 1221000191 137
BioStep G8 1221000192 137
BioStep H13 1221000193 137
BioStep I20 1221000194 137
BioStep J25 1221000116 137
BioStep K36 1221000117 137
BioStep L56 1221000114 137
Referencia Página
BioStep M90 1221000115 137
Boca de carga tipo CAMPSA 2” y codo rosca macho 2” 1063028456 158
Bomba autoaspirante para piscinas 0,5 CV 6020400333 27
Bomba de alta eficiencia Roth 25-80 4310300001 83
Bomba de alta eficiencia Roth 25-100 4310300002 83
Bomba de trasvase manual 1863010070 176
Bomba Estándar Hidro para KHR 500, 700 y 1100 1541100274 100
Bomba Gran Volumen Hidro para KHR 2000 1541100275 100
Bomba para agua pluvial 1541100218 117
Bomba para agua pluvial con accesorio para aspiración 1541100219 117
Bomba para suministro de gasóleo 1920700066 177
Boya contacto eléctrico 1540800154 101
Cable bus Rothaclima 3x0,25 mm2 4410403025 80
Cable Rothaclima 2x0,75 mm2 4410402075 81
Caja Blanca Empotrable R1150 1135007570 68
Caja Blanca Empotrable R550 1135007567 68
Caja Blanca Empotrable R750 1135007568 68
Caja Blanca Empotrable R950 1135007569 68
Caja para grupo compacto CC Compact 1135006111 59
Carril portatubos Ø 16 mm (longitud 2,5 m) 1135004592 61
Carro de transporte 4011010006 63
Cartucho de filtro (recambio) 1240100261 140
Caudalímetro DN 20 - hasta 40 m2 de captadores 6040200143 16
Caudalímetro DN 32 - hasta 300 m2 de captadores 6040200144 16
Central Rothaclima 7 zonas aire frío calor 4410400201 80
Central Rothaclima 7 zonas suelo radiante frío calor 4410400105 80
Codo + contrabrida 1" 1563013204 103
Codo + contrabrida 2" 1540800209 103
Codo guía 4013010415 69
Codo guía para tubo Ø16 4310300032 69
Colector Compacto con caudalímetro HKV-CL 10 1115009804 64
Colector Compacto con caudalímetro HKV-CL 11 1115009805 64
Colector Compacto con caudalímetro HKV-CL 12 1115009806 64
Colector Compacto con caudalímetro HKV-CL 3 1115009797 64
Colector Compacto con caudalímetro HKV-CL 4 1115009798 64
Colector Compacto con caudalímetro HKV-CL 5 1115009799 64
Colector Compacto con caudalímetro HKV-CL 6 1115009800 64
Colector Compacto con caudalímetro HKV-CL 7 1115009801 64
Colector Compacto con caudalímetro HKV-CL 8 1115009802 64
Colector Compacto con caudalímetro HKV-CL 9 1115009803 64
Colector plástico modular - Kit base 4310586290 66
Colector Thermaset HK 10 1135008109 67
Colector Thermaset HK 11 1135008110 67
Colector Thermaset HK 12 1135008111 67
Colector Thermaset HK 2 1135008101 67
Colector Thermaset HK 3 1135008102 67
Colector Thermaset HK 4 1135008103 67
Colector Thermaset HK 5 1135008104 67
Colector Thermaset HK 6 1135008105 67
Colector Thermaset HK 7 1135008106 67
Colector Thermaset HK 8 1135008107 67
Colector Thermaset HK 9 1135008108 67
Combi Vitrif. 900/200 6030100132 42
Conjunto antirremolino RothRain 1540600100 118
Conjunto cincha de anclaje para Duo System 1920700001 159
Conjunto grifo de 1” 1540800140 103
Conjunto T 680 de aspiración 1920200030 158
Conjunto T 760 de aspiración 1920200031 158
Conjunto T 820 de aspiración 1920200032 158
Conjunto T 900 de aspiración 1920200033 158
Connect-TA 1541400339 116
Contador de aguas residuales 1240400252 139
Contador digital para AdBlue 8010020005 176
Contador digital para boquerel 8050100071 176
Contador para equipo de trasvase de gasoil 1863011355 177
Contrabrida 1" 1540600086 102
Contrabrida 1”½ 1540100099 102
Contrabrida 1”¼ 1540100098 102
Contrabrida 2" 1540600087 102
Cronotermostato frío calor Weekline 4310004040 74
Cuadro eléctrico para bombeo 1540500277 105
Cubierta para Duo System 1000 T 1910100075 159
Cubierta para Duo System 1500 1910100076 159
Cubierta para Duo System 400 y 620 1910100073 159
Cubierta protección para Unitech / Multitech 1000 Plus 1910100075 176
Cubierta protección para Unitech / Multitech 1500 Plus 1910100076 176
Cubierta protección para Unitech / Multitech 400 Plus 1910100073 176
Cubierta protección para Unitech / Multitech 750 Plus 1910100074 176
DAC 10000 1220700186 136
DEC T 1500 1220700224 136
DEC T 3500 1220700225 136
DEC T 5000 1220700226 136
Depósito Transportable Multiusos 3000 8070100006 175
Depósito Transportable Multiusos 5000 8070100007 175
Desbobinador plegable para tubo 4310100006 63
Detector de fugas DS1000 T 1135007461 159
Difusor tubular 950 1240800311 140
Dispositivo avisador de llenado 1920500033 159
Dosificador RF-50 ER 1520050304 98
Dosificador RF-120 ER 1520050305 98
Dosificador RF-200 ER 1520050306 98
Dosificador RF-300 ER 1520050307 98
Dosificador RF-500 ER 1520050308 98
Dosificador RF-1000 ER 1520050309 98
EcoCompact 1000 1520500271 97
EcoCompact 500 1520500270 97
EcoSal HP 3,3 1221200371 114
EcoSal HP 6,6 1221200372 114
EcoSal LP 0,2 1221200446 115
EcoSal LP 0,4 1221200447 115
EcoSal LP 0,6 1221200448 115
EcoSal LP 0,8 1221200449 115
EcoSal LP 1,0 1221200450 115
EcoSal LP 1,2 1221200451 115
EcoSal LP 1,6 1221200452 115
EcoSal LP 2,4 1221200453 115
EcoStep Pro 10 1221200319 113
EcoStep Pro 4 1221200317 113
EcoStep Pro 6 1221200318 113
EcoStep UV 1221200435 116
Embudo plástico universal 8040100144 176
Acumulador EPS-200 6030100338 42
Acumulador EPS-300 6030100339 42
Acumulador EPS-500 6030100340 42
Equipo de trasvase de gasóleo con contador 1920700046 177
Equipo Trasvase Portable para AdBlue 8010020006 176
Equipo Trasvase Portable para gasóleo 8010020007 176
Espiga PVC Ø 25 con racor loco 25 x 1” 6060000010 26
Espiga PVC Ø 40 con racor loco 40 x 1” ½ 6060000011 26
FC 10000 1220100088 137
FC 5000 1220100090 137
FC BIO 10000 1220700103 127
FC BIO 5000 1220700102 127
Filtro con cesta para interior del depósito 1540600221 118
Filtro con retorno integrado gasóleo 1910100030 158
Filtro de equipo de trasvase de gasoil 1930500056 177
Filtro de Gran Volumen
Referencia Página
1540600222 118
Filtro Horizontal 1540600223 118
Filtro para agua de lluvia 1540600068 118
Forro para Quadroline® TQ 325 1135007441 41
Forro para Quadroline® TQ 500 1135007440 41
Forro para Quadroline® TQ 850 1135007594 41
Forro térmico clase A para Quadroline® TQ 325 1135007443 41
Forro térmico clase A para Quadroline® TQ 500 1135007444 41
FR 1000 1220110000 137
FR 1500 1220115000 137
FR 2000 1220120000 137
FR 3000 1220130000 137
FR BIO 1000 1220210001 127
FR BIO 1500 1220215001 127
FR BIO 2000 1220220001 127
FR BIO 3000 1220700111 127
Goma insonorización abrazadera soporte HKV 1150008941 65
Grapadora Roth Speedstar 1115010582 51, 63
Grapa para sujeción de tubo a mallazo 4-5mm 4310114205 63
Grapa para sujeción de tubo a mallazo 6 mm 4310114206 63
Grapadora para mallazo 4310101420 63
Grifos de llenado/vaciado + purgador 1150008823 65
Grupo compacto CC Compact A.E. (máx. 2 circuitos) 1135004000 59
Grupo de impulsión a punto fijo 4410300055 82
Grupo de impulsión AE Horizontal 1135007401 82
Grupo hidráulico DrainBack AE 6020400348 15
Grupo hidráulico frío calor sin servomotor 4410300756 82
Grupo hidráulico solar UPM3/7,5 6020400334 15
IN1A 1540800007 101, 155
IN2A 1540800008 101, 155
IN3A 1540800026 101, 155
IN3B 1540800027 101, 155
IN3C 1540800028 101, 155
IN3D 1540800029 101, 155
Indicador de nivel DS 1000T 8020200006 158
Indicador de nivel DS 400 8020200035 158
Indicador de nivel DS 620 y RT 1000 Estándar 1920500019 158
Indicador de nivel DS/RT/RT+ 1500 1920500020 158
Indicador de nivel mecánico A 1540700047 103
Indicador de nivel mecánico B 1540700048 103
Indicador de nivel mecánico C 1540700049 103
Indicador de nivel mecánico D 1135000165 103
Indicador de nivel RT+ 1000/RT 1000 Estrecho y Compact 2150500003 158
Indicador de nivel RT+ 2000/RT 2000/RT 750 Compact 2150500008 158
Indicador de nivel RT+ 500 y RT 500 Estrecho 2150500001 158
Indicador de nivel RT+ 700/RT 700 Estrecho 2150500002 158
Interruptor de nivel horizontal 1540800024 101
Interruptor de nivel vertical regulable 1540800006 101
Juego bastidor CP vertical 1 captador Rothsol 207 6070200360 14
Juego bastidor CP vertical 2 captadores Rothsol 207 6070200361 14
Juego bastidor ST vertical 1 captador Rothsol 207 6070200358 14
Juego bastidor ST vertical 2 captadores Rothsol 207 6070200359 14
Junta labiada DN 110 1540600002 117
Junta labiada DN 50 1540600001 117
KHR 1100 1540600165 95
KHR 2000 1540600234 95
KHR 500 1540600163 95
KHR 700 1540600164 95
Kit A Gran Caudal 1920400047 157
Kit ampliación 8 litros DrainBack AE 6020400349 15
Kit anclaje sobre tejado - Teja mixta 1135004075 26
Kit aspiración agua de lluvia con contrabrida 1540600095 118
Kit aspiración agua de lluvia conexión bomba 1540600099 118
Modelo
Kit Aspiración gasóleo 1063012001 158
Kit Aspiración plástico negro 1920400021 158
Kit aspiración translúcido 1910100077 158
Kit B Gran Caudal 1920400048 157
Kit bypass presión diferencial colector modular Roth 4310580839 66
Kit C Gran Caudal 1920400049 157
Kit cloración AquaServe 1240400180 117
Kit cloración EcoStep Pro 1240400181 117
Kit D Gran Caudal 1920400050 157
Kit de reparación Ø 11 1135003446 69
Kit de reparación Ø 16 1115007910 69
Kit de reparación Ø 20 1135000279 69
Kit de unión Rothagua Twinbloc® 1560800225 117
Kit E Gran Caudal 1920400051 157
Kit tapón 1540800153 104
Kit tapones 6020400025 26
Kit unión Ø 25 6020400023 26
Kit unión Ø 40 6020400024 26
Kit XXL Aspiración gasóleo 1063012003 158
Lámina de aislamiento acústico Rothsilent 4310300030 63
Larguero 150 mm para montaje de rejilla 4410400150 81
Larguero 300 mm para montaje de rejilla 4410400300 81
Larguero 400 mm para montaje de rejilla 4410400400 81
Larguero 500 mm para montaje de rejilla 4410400500 81
Likefian Evo 1135001917 138
Llave reguladora de caudal 1150008815 65
Manguera EVO de 5 m para RothStation M-M 1"-3/4" 1930100060 177
Medidor altura de lodos 1240400334 140
Medidor de cloro en continuo 1541400323 117
MicroStar 10 1221400004 129
MicroStar 15 1221400005 131
MicroStar 20 1221400006 131
MicroStar 25 1221400007 131
MicroStar 30 1221400008 131
MicroStar 38 1221400009 131
MicroStar 4 1221400001 129
MicroStar 45 1221400010 131
MicroStar 6 1221400002 129
MicroStar 8 1221400003 129
MicroStep Compact 5 1220300469 132
MicroStep D 20 1220300006 134
MicroStep E 25 1220300007 134
Mini sonda interior inalámbrica Touchline SL8 1135010165 77
Módulo de conexiones C10 Basicline 230V 1135008500 75
Módulo de conexiones C6 Basicline 230V 1135007708 75
Módulo de ida + retorno 1 salida 4310586301 66
Módulo extensión 8 canales Touchline SL8 1135010148 77
Módulo internet Touchline SL8 1135010150 77
Módulo master 8 canales Touchline SL8 1135010147 77
Módulo Rothaclima 1 zona suelo y fancoil 3V 4410400123 80
Módulo Rothaclima integración KNX 4410400111 81
Módulo WIFI Rothaclima 4410400109 81
Multitech 1000 Plus 8020100012 169
Multitech 1500 Plus 8020100010 169
Multitech 400 Plus 8020100007 169
Multitech 750 Plus 8020100013 169
Pasarela Rothaclima ventilador 3 velocidades 4410400003 81
Pasarela Rothaclima ventilador 1-10 V 4410400110 81
Perfil junta dilatación CC Compact 40 x 8 mm 1135003443 59
Perfil para junta de dilatación 4310100003 63
Pistola paro automático 1930200025 177
Placa ClimaComfort Compact 1072 x 772 x 14 mm 1115007104 59
Placa de nopas 23 térmica 4025000023 53, 57
Placa de nopas 38 térmica 4025000038 53, 57
Placa de nopas 13 térmica Stark 4024000013 53, 57
Placa de nopas 27 térmica Stark 4024000027 53, 57
Placa de nopas 44 térmica Stark 4024000044 53, 57
Placa lisa 25 4061010525 51, 56
Placa lisa 26 1115001222 51, 56
Placa lisa 30 4061010530 51, 56
Placa lisa 30 en rollo 1135001581 51, 56
Placa lisa 44 4061010544 51, 56
Prolongación Boca de Hombre 1135000340 141
Protector para resistencia/termostato más racor* 6070300027 43
Purgador solar 6020400111 18
Purgadores automáticos para colector plástico 4310586297 66
Quadroline® TQ-K 500 1115009471 33, 40
Quadroline® TQ-K 850 1115009995 33, 40
Quadroline® TQ-T 325 1115009463 33, 36
Quadroline® TQ-T 500 1115009468 33, 36
Quadroline® TQ-T 850 1115009992 33, 36
Quadroline® TQ-TW 325 1115009464 33, 37
Quadroline® TQ-TW 500 1115009469 33, 37
Quadroline® TQ-TW 850 1115009996 33, 37
Quadroline® TQ-TWK 500 1115009952 33, 39
Quadroline® TQ-TWK 850 1115009994 33, 39
Quadroline® TQ-TWS 325 1115009466 33, 38
Quadroline® TQ-TWS 500 1115009682 33, 38
Quadroline® TQ-TWS 850 1115009997 33, 38
RA E 1000 1521000249 98
RA E 1500 1521500250 98
RA E 2000 1522000251 98
RA E 3000 1523000252 98
RA E 500 1520500248 98
Racor 11 x 1,3 mm - ¾" 1135006677 59, 69
Racor 16 x 2 mm - ¾" 1135005189 69
Racor 20 x 2 mm - ¾" 1135005201 69
Racor conexión 1 ¼” 1135007394 41
Racor depósitos 1" macho y ¾" hembra 1540800016 104
Racor depósitos ½" macho y hembra 1540800018 104
Racor depósitos 2" macho y 1" ½ hembra 1540800017 104
Racor doble ¾” - 11 x 1,3 mm 1135006678 59
Racor doble ¾” - ¾” 1135004001 69
Racor macho 11 x 1,3 mm - ½" CC Compact 1135003447 59
Racor reducción 1 ¼” - 1" 1135007681 41
RB 3000 1561017230 91
RB 500 1520500040 91
RB 700 1520700041 91
RC 1000 1561017210 91
RC 1000 Compact 1520900043 91
RC 750 2561013204 91
RDB 1100* 1521000063 91
RDB 2000* 1522000070 91
RDBA 3000* 1523000074 91
Rebosadero DN 110 1540800014 118
Rebosadero DN 50 1540800013 103
Recambio de filtros (paquete con 5 unidades) 1910100037 158
Recambio detentor colector HKV 1150010163 65
Recambio mecanismo termostático superior 1150010164 65
Recambio regulador con caudalímetro para colector 1150010161 65
Recambio servomotor AVM para mezcladora 4410000006 84
Recambio servomotor AVM para mezcladora 4410000007 84
Recambio servomotor SSC para mezcladora 4410500057 84
Receptor inalámbrico Rothalert 1540600246 100, 155
Refractómetro 6020700161 18
Regulador solar BW/H Confort AE 1135007151 16
Modelo
Regulador solar Ex BW v2 6040100331 16, 26
Regulador solar Ex BW/H v3 6040100332 16
Rejilla motorizada Rothaclima 300x150 mm 4410403150 81
Rejilla motorizada Rothaclima 400x150 mm 4410404150 81
Rejilla motorizada Rothaclima 500x150 mm 4410405150 81
Rejilla retorno Rothaclima 300x150 mm 4410413150 81
Rejilla retorno Rothaclima 400x150 mm 4410414150 81
Rejilla retorno Rothaclima 500x150 mm 4410415150 81
Relé de conexión 12 A con zócalo 6020400341 27
Relleno biológico 1210000010 140
Repetidor Touchline SL8 1135010034 77
Resistencia 1,5 kW. Dimensiones: 32 x 300 mm. 6070300025 43
Resistencia 2 kW D 32 x 300 6070300023 21, 43
Resistencia 2 kW. Dimensiones: 32 x 300 mm. 6070300023 21, 43
Resistencia 2,5 kW. Dimensiones: 32 x 320 mm. 6070300026 43
RG 1000 1220410000 125
RG 1500 1220415000 125
RG 2000 1220420000 125
RG 3000 1220430000 125
RG 500 1220400031 125
RG Mini 120 1220400169 125
RG Mini 50 1220400168 125
RGIM 200 1220600061 136
RGIM 360 1220600062 136
RGIM 500 1220600063 136
RGIM 75 1220600060 136
RLL 3500 1523500180 99
RLL 5000 1525000224 99
Roth Duo System 1000 T 1821000004 149
Roth Duo System 1500 1821500001 149
Roth Duo System 400 1820400001 149
Roth Duo System 620 1820600001 149
Roth Hidrobox 1240100253 138
Rothagras Bio Pack 1 l 1240300206 138
Rothagras Bio Pack 25 l 1240300230 138
Rothalen 1000 Compact 1061011109 153
Rothalen 1000 Estándar 1021000002 153
Rothalen 1000 Estrecho 1021000001 153
Rothalen 1500 Estándar 1021500001 153
Rothalen 2000 Estándar 1022000001 153
Rothalen 500 Estrecho 1020500001 153
Rothalen 700 Compact 1115011354 153
Rothalen 700 Estrecho 1020700001 153
Rothalen Plus 1000 2021000001 151
Rothalen Plus 1500 2021500001 151
Rothalen Plus 2000 2022000003 151
Rothalen Plus 700 2020700001 151
Rothalert 1540600043 100, 155
Rothalert Alfa 1540600083 100,155
Rothapac tipo A 7061010100 45, 154
Rothapac tipo B 7061010101 41, 43, 154
Rothapac tipo C 7061010102 41, 154
Rothapac tipo D 7061010103 154
Rothapac tipo E 7061010104 41, 154
Rothidro Bio Pack 1240300204 138
Rothpool® 1.2 1115010974 23
Rothpool® 2.2 1135004070 23
RothRain 10000 Eco 1580200005 109
RothRain 10000 Plus 1580200006 109
RothRain 3500 Eco 1580200001 109
RothRain 3500 Plus 1580200002 109
RothRain 5000 Eco 1580200003 109
RothRain 5000 Plus 1580200004 109
Rothsol 207
Referencia
6070200353 13
RothStation In/Outdoor RP 1000 8091020002 167
RothStation In/Outdoor RP 1500 8091020003 167
RothStation In/Outdoor RP 2000 8091020004 167
RothStation In/Outdoor RP 700 8091020001 167
RothStation Portable 125 AdBlue 8010010004 174
RothStation Portable 460 8070100009 173
RothStation Portable MT 1000 8091010003 166
RothStation Portable MT 1500 8091010004 166
RothStation Portable MT 400 8091010001 166
RothStation Portable MT 750 8091010002 166
RSA 1" 1540800002 103
RSA 1" con acople 1563011126 103
RSA 1”½ 1540800003 103
RSA 1”½ con acople 1540100085 103
Salida colector conexión cónica 1150010162 65
Salida colector tipo II conexión cónica 1150010165 65
Separador hidráulico con aislamiento 1” 4410000026 84
Service Box 170 8011700001 171
Service Box 250 8012500003 171
Servomotor eléctrónico para grupo hidráulico frío calor 4410300332 82
Set 2 soportes colector plástico modular 1135009141 66
Set 2 termómetros colector plástico modular 4310586299 67
Seta de aireación 1540800015 103
Seta de aireación de 2" 1517010050 158
Seta de aireación de 2" con filtro anti insectos 1540800015 158
Seta de desodorización 1240100251 140
Sifón DN 110 1240100208 140
Sistema automático entrada de agua de red 1" 1540500264 117
Sistema automático entrada de agua de red 1/2" 1540500263 117
Sistema de anclaje para Rothagua 1560600238 104
Sistema de anclaje Rothalen y Rothalen Plus 1560600238 159
SHR-30 DUO 1220600457 135
SHR-40 DUO 1220600458 135
SHR-60 DUO 1220600459 135
SHR-80 DUO 1220600460 135
SHR-100 DUO 1220600461 135
SHR-150 DUO 1220600462 135
SHRY-30 DUO con By-Pass 1220600463 135
SHRY-40 DUO con By-Pass 1220600464 135
SHRY-60 DUO con By-Pass 1220600465 135
SHRY-80 DUO con By-Pass 1220600466 135
SHRY-100 DUO con By-Pass 1220600467 135
SHRY-150 DUO con By-Pass 1220600468 135
Sonda anticondensación 24 V 6466540206 75
Sonda inmersión PT1000 1135002271 16, 26
Soplante AP 120 1240800312 139
Soplante HP 150 1240200368 139
Soplante HP 200 1240200369 139
Soplante JDK 50 1240200303 139
Soplante XP 80 1240800313 139
Soporte armario de trasvase RP 2000 8092000003 177
Soporte armario de trasvase RP 700, 1000, 1500 8092000002 177
Start Pack 1235000350 138
Tapa de torre de realce 1240100012 141
Tapa roscada para torre de realce EVO 325 1240400200 141
Tapa transitable peatonal PN 200 1240100315 141
Tapa transitable tránsito rodado PN600 1240100179 141
Tapa y fleje boca de hombre ovalada de PEAD 1540200027 140
Tapa y fleje para boca de hombre circular Ø 400 mm 1540200026 104
Tapa y fleje para boca de hombre ovalada 500 x 400 mm 1540200027 104
Tapón a perforar de dos piezas y junta 1064020155 104
Tapón cierre circuito 1150010166 65
Tapón de cierre para circuitos 1135000354 69
Tapón perforado de tres piezas y junta 1910200026 104
Tapón perforado de tres piezas y junta 1910200026 159
Tapón y junta para boca de 150 mm 50003239 104
Te + contrabrida 1" 1563013205 103
Te + contrabrida 2" 1563013215 103
Termosifón RTS Selectivo 200 - Cubierta plana 6070102200 21
Termosifón RTS Selectivo 200 - Sobre tejado 6070101200 21
Termosifón RTS Selectivo 300 - Cubierta plana 6070102300 21
Termosifón RTS Selectivo 300 - Sobre tejado 6070101300 21
Termostato frío calor Dayline 4310008120 74
Termostato híbrido Rothaclima color negro 4410400202 80
Termostato híbrido Rothaclima color blanco 4410400101 80
Termostato inalámbrico T/HR Touchline SL8 blanco 1135010149 77
Termostato inalámbrico T/HR Touchline SL8 negro 4310000181 77
Termostato para resistencia 6070300024 21, 43
Tijera cortatubos monocorte 1400214026 63
Tira perimetral aislante doble autoadhesivo 1135002831 61
Tira perimetral autoadhesiva ClimaComfort 1135003442 59
Toldo Universal Roth 6020100008 17
Tornillo fijación abrazadera soporte HKV 1150008951 65
Torre de realce 1240100011 141
Torre de realce con tapa transitable 1240100314 141
Torre de realce EVO 325 1240100276 141
Torre de realce ovalada 1240100455 141
Transformador 230Vac - 24Vac 2100000001 75
Tubo antiespumante 1064020030 159
Tubo Multicapa Roth Alu-LaserFlex 16 x 2,0 mm 1135004584 51, 53, 61, 62
Tubo Roth X-PERT S5 - 11 x 1,3 mm 1135003441 59, 62
Tubo Roth X-PERT S5 - 16 x 2,0 mm 1345161210 51, 53, 61, 62
Tubo Roth X-PERT S5 - 16 x 2,0 mm 1345161316 51, 53, 61, 62
Tubo Roth X-PERT S5 - 20 x 2,0 mm 1345201217 51, 53, 62
Tubo Roth X-PERT S5 - 20 x 2,0 mm 1345201326 51, 53, 62
Unidad Base 1" 1540800132 102
Unidad Base 2" 1540800200 102
Unidad Base Füll-Star 1920100001 156
Unidad Fila A 1". 1540800134 102
Unidad Fila A 2". 1540800137 102
Unidad Fila B 1”. 1540800135 102
Unidad Fila B 2”. 1540800138 102
Unidad Fila C 1". 1540800136 102
Unidad Fila C 2". 1540800139 102
Unidad Fila D 1". 1540800141 102
Unidad Fila D 2". 1540800142 102
Unidad Fila FS-700 Füll-Star 1920200001 156
Unidad Fila FS-700 XXL Füll-Star 1920200006 156
Unidad Fila FS-780 Füll-Star 1920200002 156
Unidad Fila FS-840 Füll-Star 1920200003 156
Unidad Fila FS-920 Füll-Star 1920200004 156
Unión para bastidores Rothpool® 1115010544 26
Unitech 1000 Plus 8020100015 175
Unitech 1500 Plus 8030100016 175
Unitech 400 Plus 8030100013 175
Unitech 750 Plus 8020100021 175
Vaina acero inoxidable para sonda inmersión 6020700252 16, 26
Válvula de corte de esfera 1” sin termómetro 1135006454 69
Válvula de corte de esfera para colector plástico 4310586298 69
Válvula de corte para purgador 6020400128 18
Válvula mezcla DN 20 (¾") Kvs 6,3 4410000010 84
Válvula mezcla DN 25 (1") Kvs 10 4410000008 84
Válvula mezclaDN 32 (1 ¼") Kvs 16 4410000011 84
Válvula de seguridad 3 bar 6020400126 18, 41, 43
Válvula de seguridad 6 bar 6020400127 18, 43
Referencia Página
Válvula de seguridad 8 bar 6040200117 18, 41, 43
Válvula de zona gran caudal sin actuador 4310206691 69, 75
Válvula diversora motorizada 3V - 1" Kvs 7,7 6020700289 18
Válvula diversora motorizada 3V - ¾" Kvs 7 6020700290 18
Válvula mezcladora termostática ¾” para ACS 6020700330 18
Válvulas de corte de esfera 1” con termómetro 1150008821 69
Vaso expansión 100 l Ø 450 mm/ H 850 mm 6020400091 19
Vaso expansión 12 l Ø 270 mm/ H 304 mm 6020400080 19
Vaso expansión 12 litros para RTS 300 6070300325 21
Vaso expansión 200 l Ø 485 mm/ H 1400 mm 6020400092 19
Vaso expansión 24 l Ø 270 mm/ H 405 mm 6020400081 19
Vaso expansión 35 l Ø 360 mm/ H 615 mm 6020400089 19
Vaso expansión 50 l Ø 360 mm/ H 750 mm 6020400090 19
Vaso expansión 8 litros para RTS 200 6070300324 21
WaterControl 1540600276 100
Toda relación comercial entre Roth Ibérica, S.A.U. y sus clientes se regirá por las siguientes condiciones generales de Venta que se entenderán aceptadas por el comprador en el momento de cursar su pedido.
Nuestras Condiciones de Venta se dirigen exclusivamente a su destinatario y contienen información confidencial. En caso de llegar a nuestro conocimiento su divulgación y/o copia sin autorización expresa, Roth Ibérica, S.A.U. se reserva el derecho de anular las presentes condiciones de venta quedando a nuestra discreción el elaborar una nueva oferta, si se estima oportuno.
Todas las indicaciones, fotografías, datos técnicos o de otra índole que se facilitan en nuestros folletos y publicaciones son sólo a título orientativo, reservándonos el derecho de modificarlos sin previo aviso. Dichas modificaciones serán comunicadas a nuestros clientes por el medio más rápido posible, quedando exentos de toda responsabilidad cuando dicha comunicación no fuese efectiva.
- La presente tarifa de precios entra en vigor a partir de la fecha indicada en portada. Consecuentemente, queda anulada cualquier tarifa anteriormente vigente.
- Si por cualquier motivo hubiera importantes oscilaciones en los precios de compra, Roth Ibérica, S.A.U. se reserva el derecho de modificar los precios de venta de la presente tarifa sin previo aviso.
- Los precios incluidos en esta tarifa no incluyen IVA ni transporte.
- Todos los impuestos actualmente en vigor y los que en el futuro pudieran gravar el producto serán a cargo del comprador.
- Cualquier condición consignada por el comprador en el pedido, que no se ajuste a la presente tarifa o a las condiciones generales de venta, se considerará nula, salvo nuestra explícita conformidad que deberá constar por escrito.
- Nuestros productos se expedirán en la forma indicada en la presente tarifa.
- El precio del embalaje está incluido en el precio de las mercancías; en cambio, cualquier embalaje especial solicitado por el comprador, será facturado aparte.
- La responsabilidad de Roth Ibérica, S.A.U. con respecto al transporte de los productos viene ligada a las condiciones de entrega acordadas previamente entre ambas partes, por lo que cualquier menoscabo o deterioro de los mismos no amparado bajo dichas condiciones, quedará a nuestra discreción el asumirlos como gesto comercial o rechazarlos. El hecho de que contratemos el transporte de los productos en nombre del cliente, no supondrá en ningún caso la aceptación por nuestra parte de los riesgos del mismo.
- Los plazos de entrega notificados en nuestras confirmaciones de pedido por parte de nuestro personal serán solamente orientativos, por lo que los retrasos en las entregas ocasionados por causas ajenas a Roth Ibérica, S.A.U. o bien por causa mayor (fenómenos atmosféricos, accidentes, huelgas de transportes, etc…) no serán motivo de reclamación por parte del comprador ni causa justificada para la anulación del pedido.
Atenderemos las reclamaciones justificadas de posibles anomalías en el material en base al siguiente criterio:
• Daños evidentes: se deberán detallar a la firma del albarán en el momento de la entrega.
• Daños ocultos: se harán por escrito a nuestra central en Tudela en el plazo de 24 horas siempre que conste la firma en el albarán y la anotación "pendiente de revisión”.
- Los pedidos aceptados no podrán ser anulados una vez que se haya contratado el servicio de transporte correspondiente.
- En caso de materiales de fabricación especial, el pedido no podrá ser anulado una vez emitida la orden de fabricación.
- Roth Ibérica, S.A.U. se reserva el derecho de anular pedidos pendientes de entrega, en caso de que el comprador no cumpla, total o parcialmente, anteriores contratos.
- No se admitirá ninguna devolución de material que no haya sido autorizada expresamente y por escrito a Roth Ibérica, S.A.U.
- Toda devolución de material llevará consigo la obligación de presentar copia de las facturas y/o albaranes originales.
- Se establece un plazo máximo de 2 meses a partir de la fecha de suministro de la mercancía para solicitar una devolución, la cual deberá ser autorizada por Roth Ibérica, S.A.U. Transcurrido dicho plazo en ningún caso se admitirá una devolución.
- En ningún caso se admitirá la devolución de material descatalogado o Fuera de la gama de nuestros productos y que hayan sido expresamente Solicitados por el cliente.
- Toda devolución devengará en una deducción en el importe de un 15% En concepto de gastos de recepción, inspección y demérito.
- Además, el transporte de devolución del material a Roth Ibérica, S.A.U. correrá a cargo del comprador.
El pago de las facturas emitidas y enviadas al comprador se deberán abonar en los plazos y forma pactados previamente con Roth Ibérica, S.A.U. Si a la recepción de una solicitud de pedido se produjeran o se conocieran hechos o circunstancias que pudieran dar a pensar que el comprador podría incumplir su obligación de pago, Roth Ibérica, S.A.U. se reserva el derecho de suspender el envío de los productos solicitados y de solicitar que éstas sean abonadas anticipadamente.
Por otro lado, transcurrido el vencimiento convenido para el pago de las facturas, en caso de incumplimiento, Roth Ibérica, S.A.U. estará autorizada a incrementar los intereses financieros correspondientes. Asimismo, el comprador perderá el derecho a la percepción de cualquier bonificación concedida por descuentos especiales, abonos, etc. que sobre los precios de la presente tarifa se concedan, si se incurre en impago o morosidad.
Las presentes condiciones Generales de Venta se regirán por el Fuero Navarro. Las partes, con expresa renuncia al Fuero que les correspondiese, se someterán a los Juzgados y Tribunales de la Ciudad de Tudela para dirimir cualquier diferencia que pudieran derivarse de estas Condiciones Generales de Venta.
Todos los productos poseen una garantía por posibles defectos de fabricación.
Cualquier aviso o notificación de defectos ha de hacerse de forma inmediata y por escrito a nuestro Servicio Posventa en Tudela (Navarra), remitiendo al mismo tiempo el certificado de Garantía correspondiente, y no podrá ser desinstalado sin la expresa autorización del técnico de Roth Ibérica. En los casos de obligación de garantía, quedará a nuestra discreción cumplir el compromiso de garantía en forma de una indemnización o una prestación sustitutiva o de reparación efectuada por nosotros o por terceros excluyendo cualquier otro gasto.
Roth Ibérica, S.A.U. ofrece a sus clientes la puesta en marcha por teléfono, online o presencialmente (a determinar en cada caso).
Sólo podrá realizarse la puesta en marcha una vez que todos los elementos hayan sido conectados hidráulicamente.
No se realizará ninguna puesta en marcha si la instalación está incompleta, es de difícil acceso, o si sus características no se corresponden con los esquemas facilitados por nuestro departamento técnico.
En el caso de no poderse hacer la puesta en marcha y la instalación por motivos ajenos a Roth Ibérica S.A.U. se reclamarán los gastos ocasionados.
En el Grupo Roth llevamos 75 años innovando y fabricando por un futuro sostenible. Desde 1947 hemos acompañado a nuestros clientes desde los almacenes hasta sus hogares en todo el mundo.
Avalados por clientes y hogares de todo el mundo. Somos una empresa familiar de origen alemán con presencia en más de 60 países. En Roth Ibérica trabajamos desde hace más de 25 años comercializando y fabricando desde Tudela para la Península Ibérica y países latinoamericanos. Tenemos almacenes en varios puntos del país, departamentos técnicos para cada gama y un equipo comercial dedicado a cada zona para dar un servicio óptimo y personalizado a nuestros clientes. Trabajamos a tu lado para ofrecerte las siguientes ventajas:


• Productos y soluciones innovadores y únicos en el mercado.
• Orientación total al sector profesional.
• Servicio y asesoramiento técnico en el proyecto y en la obra.
Productos y sistemas certificados.
• Un equipo cercano de más de 50 personas a tu disposición.
• Nuestros almacenes, departamentos técnicos y departamento comercial, reciben a diario
consultas de instaladores, ingenieros, arquitectos y particulares sobre productos que llevan décadas siendo líderes en el mercado. Muchos de ellos siguen funcionando y recibiendo soporte 25 años después. Roth cumple 75 años formando parte de miles de hogares.
• Por eso queremos darte las gracias y decirte que, contigo, como en casa
Tal vez ya sabías que el sistema de grapa de Roth fue el sistema original y el primero en desarrollar mejoras para aumentar la eficiencia energética de la instalación. Eso nos diferencia del resto de fabricantes, pero ¿sabías que, además, somos una de las pocas marcas de suelo radiante que fabrican en España?
A tu lado en todo momento
En Roth creemos en un servicio continuado y completo para nuestros clientes. Nuestra filosofía consiste en ofrecer sistemas completos de cada
una de nuestras gamas, para facilitar el trabajo tanto a los gabinetes de arquitectura e ingenierías a la hora de proyectar las instalaciones, como a

Estudios personalizados realizados por nuestro experimentado Departamento Técnico siempre a disposición de nuestros clientes, que elabora proyectos y valoraciones económicas para cualquiera de los productos de nuestra amplia gama.
Contamos con software específico para cada tipo de proyecto, que nos permite cumplir tanto las necesidades de la instalación como las normativas vigentes.
Estamos a su servicio para resolver cualquier duda que pudiera surgir durante la instalación y puesta en marcha de nuestros productos.
+34 948 84 44 06 tecnico@roth-spain.com (Solar - Acumulación -Suelo radiante) tecnico1@roth-spain.com (Agua - Depuración - Gasóleo - Industrial)

Información disponible a su servicio
Web completa con las documentaciones, fichas técnicas, manuales de instalación, esquemas… de todos nuestros productos.
Todo nuestro catálogo está disponible en formato Presto, (incluyendo unidades de obra completas) para facilitar la labor de ingenierías y arquitecturas.
www.roth-spain.com

Software Gratuito Suelo Radiante
Cursos personalizados según las demandas de cada cliente en particular (regulación, normativa vigente, cálculos…).
los almacenes distribuidores y empresas instaladoras a la hora de realizarlas.

distr i b ución
Roth Ibérica, S. A. U.
Pol. Ind. Montes del Cierzo, A-68 km 86 31500 – Tudela (Navarra) Tel.: 948 844 406
Loetrans, S. L. Pol. Ind. Los Olivos, C/ Comunicación, 1 28906 – Getafe (Madrid) Tel.: 91 601 11 11
Pol. Ind. El Oliveral Calle V, Nave 4 46190 – Riba-roja del Turia (Valencia) Tel.: 96 166 51 47
Rua João Paulo II Nº3 477 - 770 Vila Nova de Famalição, Vermoim Tel.: +351 910 351 503
Roth Ibérica, S. A. U.
> Energía solar térmica > Acumulación de agua caliente > Suelo radiante frío/calor > Acumulación y gestión del agua
> Depuración de aguas residuales > Depósitos para gasóleo
TCR-16.29/12/22
Soluciones completas para la eficiencia energética y una óptima gestión del agua /Roth-spain
Estamos a su disposición, no dude en contactarnos. Distribuidor:
Pol. Ind. Montes de Cierzo, A-68 km 86 E-31500 Tudela (Navarra) Tel.: 948 844 406 • Fax: 948 844 405 Correo: comercial@roth-spain.com • www.roth-spain.com
